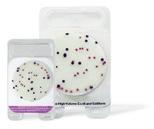

productie plantaardige basis.

2014
29e alfabetisch jaarboek van
• ondernemingen en hun contactpersonen in de Nederlandse, Belgische en Luxemburgse zuivelindustrie,
• ondernemingen en hun contactpersonen in de Nederlandse en Belgische zuivelhandel,
• organisaties en instellingen in en rond de zuivelsector en
• bedrijven die installaties, producten en diensten leveren aan de zuivelsector.
2022
Veiligheid en hygiëne spelen een grote rol. Zowel de werkzaamheden als de afwerking moet dan ook aan strenge wet- en regelgeving voldoen om deze vereisten blijvend te kunnen garanderen. Sijtsma Noord werkt uitsluitend met speciaal ontwikkelde (coating)systemen die aan alle eisen voldoen. Hierdoor kunnen wij een uitmuntende kwaliteit en hoogwaardige en duurzame afwerking waarborgen. Naast de oppervlakte afwerking dragen wij ook zorg voor de renovatie van beton en andere ondergronden. De gecertificeerde systemen brengen duurzame, veilige en hygiëne verhogende oplossingen en onderhoudsgemak.

















N S
Doelgericht Kennis van zaken Professioneel team Kwaliteit Klant gericht Snel schakelen
We doen het goed, of we doen het niet!
• Al meer dan 45 jaar dé specialist binnen de zuivel- en voedingsmiddelenindustrie • Veilige en hygiënische (coating)systemen voor o.a. vloeren, wanden, plafonds en pekelbaden • Werkzaamheden kunnen tijdens productieproces worden uitgevoerd • Internationale referenties
Volg ons ook op social media! VCA** | ISO9001 Quality Management | ISO22000 Food Safety Management | HACCP | NEN13451 Antislip
2022
Een gratis bijlage bij
ZuivelZicht
Jaargang 29
Extra exemplaren (€ 15,00) te bestellen bij
BDUvakmedia Postbus 67 3770 AB Barneveld tijdschriften@bdu.nl
Redactie
ZuivelZicht Postbus 93044 2509 AA Den Haag redactie.zuivelzicht@bdu.nl
Bij de cover
De zuivelsector verwerkt melk tot een breed pakket zuivelproducten (Foto: NZO)
Druk Vellendrukkerij BDU B.V.
COLOFON ZUIVEL IN ZICHT / 2022 5








VOOR RIJPING, OPSLAG & VERPAKKING VAN KAAS ENGINEERINGPRODUCTIEINSTALLATIEREALISATIE SAY CHEESE! Nobelweg 8, 5482 NN Schijndel / Postbus 17, 5480 AA Schijndel Tel. (073) 549 29 11 / www.voetsdonkers.nl / info@voetsdonkers.nl VERDER is fabrikant van VERDERAIR® pompen HYGIËNISCHE MEMBRAANPOMPEN VERDERAIR Hygiënische pompen voor de zuivel VERDER B.V. TEL +31 (0)50-549 59 00 MAIL sales@verder.nl WEB www.verder.nl 22-VA-AD_HiClean_125 x 85mm_ZiZ.indd 1 10-06-2022 10:42
Bij de 29e editie
Met Zuivel in Zicht biedt de redactie van ZuivelZicht een handzaam overzicht van de zuivelketen: wie is wie in de branche?
Onder invloed van veranderende omstandigheden in de markt en de maatschappij verleggen ondernemingen hun koers. Om toekomstbestendig te blijven moeten soms radicaal andere keuzes worden gemaakt. Dat leidt vaak tot aanpassingen in de bedrijfsvoering. De uitstekende uitgangspositie van de Nederlandse zuivelsector en de bijdrage van de keten aan de economische ontwikkeling zijn daarbij een belangrijke pluspunten.
Bert Kleiboer
Waarnemend hoofdredacteur ZuivelZicht
ZUIVEL IN ZICHT / 2022
7 VOORWOORD













































Zuivelindustrie
Nederland 11 België en Luxemburg 36
Zuivelhandel
Nederland 42 België 71
Kennis- en adviesinstellingen Nederland 72
Overheid en toezicht
Nederland 84
Belangenbehartiging
Nederland 88 België 112 Europa 120
Toelevering
Nederland 131 Index 157
INHOUD ZUIVEL IN ZICHT / 2022
9
Taste, texture and health
Bij DSM Food & Beverage kennen we kaas van binnen en van buiten. Of het nu gaat om kosteneffectieve kaas of om premium kaas, we werken samen met u aan het optimale product. We hebben oplossingen voor gezondere kaas, bijvoorbeeld met meer vitaminen of minder vet en zout. En dat zonder de smaak te beïnvloeden. Tegelijkertijd zorgen we voor consistente productie en brengen de CO2-voetafdruk omlaag. De basis van onze ingrediënten, expertise en oplossingen ligt in de wetenschap. En daarvan profiteert u bij het creëren van heerlijke, voedzame en duurzame kaas.

Enjoy it all

AlphenaerDe Jong Cheese
Het Sas 14, 5131 RC Alphen NB 013-5081316 (fax 013-5083301) info@dejongcheese.nl www.dejongcheese.nl
Eigenaar: Arjan de Jong
DeJong Cheese, het moeder bedrijf van Alphenaer, is een (h)echt familiebedrijf gevestigd in het Brabantse Alphen. Onze Alphenaer kazen bereiden we volgens traditionele recepturen waardoor we de beste kwaliteit kunnen garanderen. Het begint met de selectie van de hoogste kwaliteit melk welke we bij de boerderijen in de omgeving ophalen. Op al deze boerderijen wordt gewerkt met aandacht voor het welzijn van de dieren en met een duurzame manier van melkproductie. De melk wordt in onze kaasmakerij aangezuurd, gestremd en vervolgens op traditionele wijze gesneden, geroerd en verder verwerkt tot bijzondere kazen. De Alphenaer kaas wordt pas vrijgegeven voor uitlevering als onze kaasmakers de beste kwaliteit vastgesteld hebben. Zo kunnen we de kwaliteit en exclusiviteit waarborgen. We bieden een zeer divers gamma aan kazen op basis van koemelk en geitenmelk, waar we verschillende nationalen en internationale markten mee bedienen. Je vindt onze kazen in
de Retail, Foodservice, Kaasspeciaalzaken en in Business to Business onder ons eigen merk Alphenaer, maar ook als private label. Onze kracht ligt bij het op de markt brengen van unieke en innovatieve producten, we zijn zeer klantgericht en doordat we nauw samenwerken met verschillende partijen kunnen we snel inspelen op de wensen van de klant en van de markt.
Als bourgondische Brabanders houden we natuurlijk niet alleen van onze prachtige bossen, uitgestrekte landerijen en grootse uitzichten, maar ook van lekker lang tafelen. Binnen deze traditie past Alphenaer kaas als geen ander: ‘Geniet van het leven!’
Amalthea B.V.

Markiezenbaan 5, 5121 DS RIJEN 0161-224067 info@amalthea.nl www.amalthea.nl
Directie:
Bas Lavrijsen (Algemeen directeur)
Joris Aarts (Finance & Supply Chain directeur) Joop de Groot (Commercieel Directeur/DGA)
Amalthea B.V. produceert in Rijen halfharde geitenkaas en biologische koekaas. De geitenmelk is afkomstig van de leden van Amalthea, Coöperatie van Geitenhouders U.A., zij leveren al jaren eerste klasse melk die voldoet
11 INDUSTRIE / NEDERLAND ZUIVEL IN ZICHT / 2022
aan alle eisen gesteld door Kwaligeit. Vanaf 2018 voldoet deze melk ook aan alle eisen van VLOG. Voor Amalthea staat dierenwelzijn voorop. De melk, die dagelijks vers geleverd wordt, wordt verwerkt tot half harde kaas volgens moderne standaard, maar met respect voor de traditionele methodes. De kazen worden gemaakt in verschillende afmetingen en varianten, zowel natuurgerijpt als foliekaas. Ook kunnen diverse kruiden toegevoegd worden. Amalthea beschikt over eigen rijpingsfaciliteiten.
Dankzij onze speciale receptuur en jaren van ontwikkeling, is onze geitenkaas een uniek product wat door vele consumenten gewaardeerd wordt, niet voor niets werden diverse kazen tijdens de NNKC verkiezingen bekroond met Zilver en Goud.
Onze kazen vinden hun weg naar de consument in Nederland, maar ook ver daarbuiten Amalthea B.V. werkt volgens HACCP en is gecertificeerd voor Halal, BRC, IFS, SKAL, GMP+ en VLOG.
Arla Foods B.V.


Gildenstraat 30, 3861 RG Nijkerk Postbus 1089, 3860 BB Nijkerk 033-2476222 www.arla.nl
Managementteam: Mark Boot (Managing Director), Esther Tromp-Strijdveen (Sales), Susan den Boer (Marketing), Margot Tadema-van de Kraats (Site Director), Rene Malling Jakobsen (Finance), Martien van Dongen Torman (HR)
‘Creating the future of dairy to bring health and inspiration to the world, naturally...’ Dat is de missie van Arla Foods, een internationale zuivelcoöperatie ontstaan in 2000 en eigendom van ruim 8.900 melkveehouders uit zeven landen: Denemarken, Zweden, het Verenigd Koninkrijk, Duitsland, België, Luxemburg en Nederland. Arla Foods is actief in 38 landen, heeft productievestigingen in 17 ervan. Sinds 2009 is Arla Foods actief in Nederland, waar circa 400 medewerkers werken. Op basis van verwerkte melk is Arla Foods wereldwijd de op drie na grootste zuivelonderneming en de grootste producent van biologische zuivelproducten ter wereld. De zuivelcoöperatie verwerkte in 2021 bijna 14 miljard kilogram rauwe melk en behaalde een groepsomzet van 11,2 miljard euro.
Focus op duurzaamheid
We willen de hoogste waarde voor de melk van onze melkveehouders realiseren en tegelijkertijd groeimogelijkheden voor hen creëren. We zetten in op groei, maar vinden het belangrijk hoe dat gebeurt. Daarom hanteren we onder andere
12
Mark Boot
ZUIVEL IN ZICHT / 2022 INDUSTRIE / NEDERLAND
hoge standaarden voor dierenwelzijn en melkkwaliteit en streven wij naar de best mogelijke omgang met het milieu. Arla Foods heeft de ambitie om de transitie naar duurzame zuivelproductie te versnellen en daarom werken we continu aan de vermindering van onze impact op het milieu. Hierbij wordt de hele keten meegenomen: van koe tot koelkast.
Wij houden ons, samen met onze melkveehouders, dagelijks bezig met het verkleinen van de carbon footprint waarvoor we verantwoordelijk zijn. Als zuivelcoöperatie hebben we de verantwoordelijkheid - en kans - om deel uit te maken van de oplossing. Onze ambitie is duidelijk: tegen 2030 wil Arla Foods de CO2uitstoot met 30% verminderen en in 2050 volledig klimaatneutraal zijn.
Assortiment
Op onze productlocatie in Nijkerk produceren wij dagverse zuivelproducten, zoals melk, karnemelk, yoghurt, vla en pappen. We bieden in navolging van onze wereldwijze gezondheidsstrategie een gevarieerd assortiment van voedingsrijke producten aan die voldoen aan de voedingsbehoeften van consumenten en tegelijk inspireren tot een duurzaam voedingspatroon. We voeren diverse merken, zoals Arla, Melkunie, Apetina en Lurpak. Binnen deze merken hebben we succesvolle, innovatieve concepten in de markt gezet zoals Arla biologisch, Arla Lactofree, Arla skyr, Melkunie Breaker en Melkunie PROTEIN.
Royal A-ware
CEO: Jan Anker

Royal A-ware is een oer-Hollands familiebedrijf, gespecialiseerd in het produceren, rijpen, versnijden en verpakken van kaas, het produceren van dagverse zuivel, room, tapas en melkpoeder.
Wij zijn een ondernemend en klant gedreven organisatie: als actieve ketenpartner in agrifood werken we samen met melkveehouders, klanten en leveranciers aan verrassende innovaties en smakelijke producten. We werken daarbij van consument tot koe en gebruiken de ervaring die we in ons meer dan 130-jarig bestaan hebben opgedaan, voor het creëren van kortere, duurzamere agri-food ketens met onze (internationale) partners. Met ons vakmanschap,
13 ZUIVEL IN ZICHT / 2022 INDUSTRIE / NEDERLAND
Rembrandtsplein 1 3411 HA Lopik 088-7381002 info@royal-aware.com www.royal-aware.com
Jan Anker
slim gebruik van technologie en kennis van consumententrends vinden we altijd de beste en meest duurzame oplossing voor onze klanten.
Bij Royal A-ware werken meer dan 3.000 mede-werkers op diverse productielocaties en rijpingshuizen in Nederland en België.
Ausnutria

Van Nederland tot China en iedere hoek van de wereld; Ausnutria werkt iedere dag aan het bieden van hoge kwaliteit voeding voor baby’s en kinderen wereldwijd.
Wij zijn trots op onze eigen merken baby- en kindervoeding op basis van geitenmelk en (biologische) koemelk. Net zo bijzonder is de samenwerking met onze zakelijke klanten die wij ondersteunen met de ontwikkeling en productie van hun merk flesvoeding en specialistische zuivel-ingrediënten.
Onze klanten en consumenten kunnen vertrouwen op expertise op basis van ruim 100 jaar ervaring in de zuivelindustrie en hoogstaande kwaliteit geleverd vanuit onze productielocaties in Nederland.
Bel Nederland B.V.
Van Deventerlaan 31 3528 AG Utrecht 0345 799030 www.belgroup.nl
Country General Manager Nederland: Martijn Sonneveldt

Bel Nederland B.V. is onderdeel van de Franse Bel Group, een belangrijke speler op het gebied van gezonde portiesnacks op basis van fruit- en zuivelproducten. Bel verkoopt haar vijf topmerken, La Vache qui rit®, Boursin®, Babybel®, Nurishh® en Kiri®, op vijf continenten, maar heeft ook meer dan 25 sterke, lokale en internationale merken. In Nederland zorgen de 25 medewerkers van Bel Nederland B.V. ervoor dat de merken La Vache qui rit®, Boursin®, Babybel®, Nurishh® en Port Salut® verkrijgbaar zijn bij onder andere supermarkten en speciaalzaken.
Het motto van Bel, “For All. For Good” belichaamt Bel’s toewijding aan gezonder en verantwoord voedsel voor iedereen.

14 ZUIVEL IN ZICHT / 2022 INDUSTRIE / NEDERLAND
Dokter van Deenweg 150 8025 BM Zwolle 088 11 63 600 info@ausnutria.nl www.ausnutria.nl
Martijn Sonneveldt
Hieruit blijkt de vastberadenheid van Bel uit om zijn missie - “Voorvechter van gezonder en verantwoord voedsel voor iedereen” te verwezenlijken. Deze missie vormt de leidraad voor 12.510 medewerkers bij het uitrollen van een verantwoord en winstgevend bedrijfsmodel dat de consument en de gezamenlijke waarde creatie centraal stelt bij het maken van beslissingen.
In de missie zijn verantwoordelijkheid, nutritionele superioriteit en toegankelijkheid als de belangrijkste basis voor ontwikkeling in het productaanbod verankert.
Om dit duurzame bedrijfsproject uit te bouwen en Bel’s productportfolio verder te ontwikkelen, steunt Bel op het programma “We care in every portion” en deelt met zijn medewerkers en stakeholders een aanpak van voortdurende vooruitgang gestoeld op vier strategische pijlers: het bouwen van positieve merken, het versnellen van positieve innovatie, groeien in de voor de Bel Group belangrijke geografische gebieden en winnen in-store.
Op deze manier, door steeds meer verantwoorde producten aan te bieden die beantwoorden aan de groeiende verwachtingen van de consument op het vlak van milieuvriendelijke en natuurlijke voeding, streeft de Bel Group naar groei.
Bettinehoeve BV


Nieuwe donk 6, 4879 AC Etten-Leur 076-5022247 (fax 5017886) info@bettine.nl www.bettine.nl Directie : Sybren Ewijk (algemeen directeur), Ward Watzeels (inkoop directeur)
Bettinehoeve is gespecialiseerd in productie en vermarkten van verse en gerijpte geitenkaasproducten. Onder het Bettine merk wordt een breed assortiment van +/40 producten afgezet die geleverd worden aan binnen- en buitenlandse retail, horeca en industrie klanten. Het assortiment loopt uiteen van verse geitenkaas specialiteiten: naturel of met verse ingrediënten tot gerijpte geitenkaasproducten zoals witschimmel geitenkaas. Daarnaast levert het bedrijf verschillende producten voor industriële toepassingen.

15 ZUIVEL IN ZICHT / 2022 INDUSTRIE / NEDERLAND
J. Ewijk W. Watzeels
CONO Kaasmakers

Merken in kaas (o.m.)
Merken in kaas: Beemster, Beemster van ’t mes, Het Wapen van Noord Holland, Oudendijk, SmaaQ, Stompetoren, Vlaskaas, Schermermolens.
Rijperweg 20, 1464 MB Westbeemster
Postbus 1, 1462 ZG Middenbeemster 0299-689200 www.cono.nl
Netto omzet in 2021: € 268 miljoen Melkaanvoer in 2021: 406 miljoen kilogram
Bestuur: Gerben van Diepen, Jacob Willig (vicevoorzitter)

Directie: Wim Betten (algemeen directeur)
Managementteam: Wim Betten (algemeen directeur), Harco de Jager (productie) Remko van Lun (finance, control & ict), Jerry Griep (commercie Benelux & Noord Amerika), Jan Roelofs (commercie Duitsland & New Business).
‘De lekkerste en eerlijkste kaas maken we samen’ CONO Kaasmakers is een kleine toonaangevende boerencoöperatie en bestaat al meer dan 120 jaar. CONO Kaasmakers heeft ruim 400 leden melkveehouders en haar kaasmakerij staat in de Beemsterpolder. Onze boeren en kaasmakers werken sinds 1901 samen om van de beste melk de lekkerste kaas te maken. Dat doen wij met behoud van onze tradities, zoals het roeren van de wrongel met de hand, en met gebruik van de meest duurzame moderne technieken in de sinds 2020 klimaat neutraal gecertificeerde kaasmakerij.
Hardwerkende boeren verdienen een goede beloning. Naast een eerlijke melkprijs verdienen de CONO veehouders ook een extra premie voor weidegang, GMO-vrij en andere indicatoren op het gebied van duurzaamheid en dierwelzijn. Ons merk Beemster kaas is met haar unieke smaak en smedigheid een ode aan onze herkomst en wordt verkocht in meer dan 45 landen zoals in Nederland, België, Duitsland en Amerika.
Wim Betten
Productie en verkoop Kaas, melk- en weipoeder en vloeibare melken weistromen.
CONO Kaasmakers heeft in 2021 als eerste zuivelorganisatie in Nederland de ambitie uitgesproken uit om in 2030 met haar hele kaasketen klimaatpositief te zijn. Hiermee bevestigt de boerencoöperatie haar toonaangevende rol op het gebied van duurzaamheid. Duurzaamheid zit bij CONO in de genen en klimaatpositief is de volgende ambitieuze stap om de continuïteit voor volgende generaties te waarborgen.
16 ZUIVEL IN ZICHT / 2022 INDUSTRIE / NEDERLAND
DOC Kaas B.V. Hoogeveen
Buitenvaart 4001
Postbus 11, 7900 AA Hoogeveen 0528-280440 (fax 275174) info@dockaas.nl www.dockaas.nl
DOC Kaas U.A. is een Nederlandse zuivelcoöperatie, opgericht in 1895. Van de melk die de leden-melkveehouders produceren, worden kaas en andere zuivelproducten gemaakt die wereldwijd worden afgezet. Uitgangspunt bij onze activiteiten is een duurzame bedrijfsvoering die rekening houdt met mens, dier en omgeving. DOC Kaas is op 1 april 2016 gefuseerd met de Duitse zuivelonderneming DMK Group. Daarmee is de onderneming DOC Kaas B.V. een dochteronderneming geworden van DMK GmbH en is de coöperatie DOC Kaas U.A. medeeigenaar van DMK GmbH.
Voor meer informatie over DOC Kaas: www.dockaas.nl

Voor meer informatie over DMK Group: www.dmk.de/nl
Bestuur coöperatie: G.M. Mensink (voorzitter), R.T. Koopmans-van Dalen (secretaris), G. van ‘t Klooster, P.J.B. Schut Directie: M.Bruins (financieel directeur), L. Heymann (operationeel directeur)
Dr. Oetker Nederland

Postbus 57, 3800 AB Amersfoort 033-4517900 (fax 4517999) www.oetker.nl
Contactpersoon: Martin Alberts
Dr. Oetker Nederland is met de merken Dr. Oetker en Koopmans sterk gepositioneerd in het supermarktkanaal en marktleider in vriesverse pizza’s en bak- en dessertproducten. Het bedrijf is verder actief op de markt voor koelverse desserts met zuivelproducten als Paula, en Wolkentoetje. Kwaliteit en innovatie zijn de belangrijkste speerpunten in de bedrijfsstrategie. Het bedrijf is onderdeel van het familiebedrijf Dr. Oetker, een van de grootste ondernemingen in de Duitse voedingsindustrie.
Den Eelder Zuivel
Molenachterdijk 3, 5325 KL Well 073-5991283 info@deneelder.nl www.deneelder.nl
Eigenaar: E. van der Schans (directeur)
17 ZUIVEL IN ZICHT / 2022 INDUSTRIE / NEDERLAND
Koninklijke ERU


Familiebedrijf Den Eelder is gevestigd in Well (Gld.) en produceert sinds 1990 boerderijzuivelproducten. Vanaf het eerste moment hebben Ernst en Jacomine geprobeerd zo dicht mogelijk bij de (hun) natuur te blijven. De producten worden op traditionele wijze bereid van de verse melk van eigen koeien. De koemelkproducten van Den Eelder dragen met trots het keurmerk voor Echte Boerderijzuivel. Naast de stallen staat de zuivelmakerij, hier wordt de verse melk verwerkt tot een breed zuivelassortiment. Zowel van de koe als van de geit worden producten als: melk, karnemelk, yoghurt en boter geproduceerd.
Den Eelder gaat voor kwaliteit, wat alleen bereikt kan worden met echt vakmanschap. De producten liggen verspreid bij verschillende retailers in Nederland, ook is Den Eelder actief op de Foodservicemarkt. Nog generatielang wil Den Eelder Nederland blijven verrassen met kwaliteit zuivel.
Koninklijke ERU, gevestigd in Woerden, is sinds 1824 een toonaangevende producent van (smelt)kaasproducten en is internationaal actief. Koninklijke ERU heeft een passie voor kaas en heeft zich toegespitst op de productie van (smelt) kaasproducten van zeer hoge kwaliteit. Bekende consumentenproducten zijn ERU Goudkuipje, ERU Kids, ERU Balans en ERU Specialiteitskazen. Met deze producten heeft ERU een plekje veroverd bij vele Nederlandse gezinnen en ERU is met haar assortiment kaasproducten vandaag de dag nog altijd een vertrouwd beeld op de dagelijkse ontbijt- en lunchtafels van velen. Ook voor de Foodservice branche biedt Koninklijke ERU diverse smaakvolle kwaliteitsproducten zoals de handige ERU Cheese Spreads 1kg emmers.
Koninklijke ERU richt zich op het verder uitbouwen en versterken van haar marktposities in binnen- en buitenland. Daarbij zijn gezonde en smaakvolle innovaties, productontwikkeling en technologische verbeteringen belangrijke aspecten.
18 ZUIVEL IN ZICHT / 2022 INDUSTRIE / NEDERLAND
Ernst van der Schans
Middellandse Zee 7 Postbus 7, 3440 AA Woerden 0348-578411 info@eru.com - www.eru.com
Farm Dairy BV
Farmel dairy business

Kaapstanderweg 50
Postbus 520, 8200 AM Lelystad 0320-267880
info@farmdairy.com www.farmdairy.com





Contactpersoon: Arend Bouwer (directie)
Farm Dairy is al ruim 20 jaar de toonaangevende en zelfstandige private label producent van dagverse zuivel bij alle Nederlandse retailers en daarbuiten.
Als betrouwbare dedicated private label partner ontwikkelt en produceert Farm Dairy klantspecifieke en innovatieve concepten met een uitstekende prijs/kwaliteitverhouding. Op deze manier zijn we in staat samen met onze klanten het maximale uit de dynamische zuivelcategorie te halen en onze verantwoordelijkheid in de zuivelketen te nemen. Ons aanbod omvat uiteenlopende dagverse melk-, yoghurt- en vlaproducten op basis van duurzame melkstromen: (on the way to) PlanetProof, biologisch, Beter Leven Keurmerk, weide en Beter voor Koe, Natuur en Boer. Daarnaast ontwikkelen wij samen met onze klant plantaardige zuivelalternatieven.
Kortom: professionele kwaliteit en flexibiliteit, dagvers en duurzaam met flinke dosis ambitie!
Ecopark 75B, 8305 BJ Emmeloord 0527-630500 (fax 0527-630510) info@farmel.nl www.farmel.nl
Contactpersonen:


Aris van Ommeren (commercieel directeur) a.vanommeren@farmel.nl Jetze Kempenaar (algemeen directeur) j.kempenaar@farmel.nl




Farmel is een veelzijdig bedrijf actief in de nationale en internationale handel van zuivelproducten. Wij werken nauw samen met onze melkveehouders en kijken samen met hen en onze afnemers naar innovatieve mogelijkheden in de dynamische zuivelmarkt van vandaag.
Rauwe melk van de koe, geit en schaap worden rechtstreeks van onze aangesloten melkveebedrijven in Nederland, België en Duitsland vervoerd. Wij werken met verschillende melkstromen waaronder; VLOG, Beter Leven Keurmerk Zuivel 1 ster, On the Way to Planet Proof, weidemelk en biologische melk. Door het grote volume eigen melk bieden we veel flexibiliteit aan onze afnemers en zuivelverwerkers. Wij beschikken niet over eigen productiefaciliteiten en leveren onze melk aan een groot aantal melkfabrieken op basis van langetermijncontracten. Deze fabrieken verwerken de melk in consumentenproducten en
19 ZUIVEL IN ZICHT / 2022 INDUSTRIE / NEDERLAND
industriële zuivelproducten. Hierdoor kunnen wij goed inspelen op de dynamische zuivelmarkt en risico’s spreiden.







Vervolgens verzorgen wij de afvoer van de ontstane halffabricaten als room, magere melk, magere melk concentraat en wei concentraat zodat niks verloren gaat. Naast levering van de vloeibare zuivelgrondstoffen aan de industrieel verwerkers wordt een deel van de vloeibare grondstoffen in loonwerk verwerkt tot diverse soorten melkpoeders en boters.





Koninklijke FrieslandCampina N.V.
Andere Leden Executive Leadership Team: Herman Ermens (President FrieslandCampina Ingredients), Berndt Kodden (President FrieslandCampina Specialised Nutrition), Arnoud van den Berg (President FrieslandCampina Trading), Roger Loo (VicePresident FrieslandCampina Professional), Roman Scieszka (Chief Supply Chain Officer), Margrethe Jonkman (Global Director Research & Development), Simone Boitelle (Global Director Corporate Affairs), Kemal Cetin (Chief Information Officer), Hein Brenninkmeijer (Global Director Corporate Development)

De wereldwijde organisatie van FrieslandCampina
Het vervullen van onze purpose Nourishing by Nature, betere voeding voor de wereld, vereist grote inspanningen van veel mensen. We hebben

20 ZUIVEL IN ZICHT / 2022 INDUSTRIE / NEDERLAND
Postbus 1551, 3800 BN Amersfoort 033-7133333 www.frieslandcampina.com
Executive Board: Hein Schumacher (Chief Executive Officer), Hans Janssen (Chief Financial Officer), Geraldine Fraser (Chief People Officer), Roel van Neerbos (President FrieslandCampina Food & Beverage)
Roman Scieszka
Margrethe Jonkman
Herman Ermens
Arnoud van den Berg
Berndt Kodden
Roger Loo
Simone Boitelle Kemal Cetin Hein Brenninkmeijer
Hein Schumacher Hans Janssen
Geraldine Fraser Roel van Neerbos
vestigingen in 32 landen en maar liefst 22.961 medewerkers. FrieslandCampina is volledig in handen van Zuivelcoöperatie FrieslandCampina U.A., met 15.703 leden-melkveehouders in Nederland, Duitsland en België. Onze producten zijn verkrijgbaar in meer dan 100 landen. Melk en zuivel staan als sinds 1871 centraal bij alles wat we doen. Bij FrieslandCampina maken we meer dan alleen kaas en yoghurt. We produceren ook voeding op basis van zuivel voor heel specifieke groepen consumenten, zoals peuters, sporters en volwassenen met speciale behoeften. Aan de voedingsindustrie en de farmaceutische industrie leveren we ingrediënten voor hun producten. Onze activiteiten zijn onderverdeeld in vier businessgroepen:
FrieslandCampina Food & Beverage
De business group Food & Beverage voorziet consumenten wereldwijd van alle dagelijkse zuivelproducten, zoals melk, yoghurt, gecondenseerde melk, zuiveldrinks, kaas, boter en room. De business group Food & Beverage richt zich daarbij op het consumenten (B2C) en professionele (B2B) kanaal.

FrieslandCampina Ingredients
De business group Ingredients wil wereldwijd voorop lopen met voeding. Het is de ideale partner voor merken en producenten die zich willen onderscheiden met voeding, gezondheid en welzijn voor consumenten in alle fasen van het leven. Ingredients richt zich vooral op het jonge leven door het produceren van ingrediënten voor kindervoeding en biedt specifieke innovaties en toepassingen voor volwassenen op het gebied van medische voeding en sportvoeding.
FrieslandCampina Specialised Nutrition
De business group Specialised Nutrition biedt
zuivelproducten aan voor specifieke groepen consumenten. Dat varieert van kindervoeding tot voeding voor volwassenen met specifieke vereisten in verschillende levensfasen. Deze business group is actief in verschillende landen in Azië, Europa, Afrika en het Midden-Oosten.
FrieslandCampina Trading
De business group Trading houdt zich bezig met de verkoop en sourcing van basiszuivelproducten voor zowel interne als business-to-business klanten. Het productenpakket omvat kaas, boter, melkpoeder en vloeibare producten zoals rauwe melk, room, magere melk of melkconcentraat. FrieslandCampina Trading beperkt ook het risico van FrieslandCampina’s grondstofprijzen voor zuivel door het afdekken van de vet- en eiwitposities van de onderneming.
Wil je meer lezen over FrieslandCampina? Bekijk onze website www.frieslandcampina.com.
21 ZUIVEL IN ZICHT / 2022 INDUSTRIE / NEDERLAND
Globemilk Erflanden 6, 5831 ZA Boxmeer 0485-565460 info@globemilk.com www.globemilk.com Management: René van der Vleuten (DGA), Joost van Boxtel (Managing Director), Rob Branje (Commercie), Roel Peters (Inkoop/Logistiek),
Globemilk B.V. is een onafhankelijk familiebe drijf, gespecialiseerd in hoogwaardige vloeibare zuivelproducten. Als enige Nederlandse produc tielocatie, biedt Globemilk lang houdbare melk producten voor de levensmiddelenindustrie, voor groothandels en retailers. De vier kernwaarden “kwaliteit, betrouwbaarheid, verantwoordelijk heid en flexibiliteit” vind je in alle bedrijfsactivi teiten terug.
Kwaliteit
“Wij zijn een professionele partner gecertificeerd op het hoogste niveau. Dit betekend volledige controle over de keten en dus een waterdicht kwaliteitssysteem. Hiermee borgen wij de beste kwaliteit van onze producten. Van gras tot glas.”
Betrouwbaarheid
“Als betrokken en gepassioneerde partner bou wen we aan lange termijn relaties. Wij zijn als fa miliebedrijf een zeer betrokken en onafhankelijke partner, waarmee continuïteit op lange termijn gewaarborgd is.”
Verantwoordelijkheid
“Wij werken met respect voor mens, dier en milieu. Wij nemen dan ook onze verantwoorde lijkheid in de zuivelketen, door onze producten én processen te blijven verduurzamen. Wij willen oprecht de beste producten voor iedereen ter wereld beschikbaar maken.”
Flexibiliteit
“Wij anticiperen op de wens van onze partners en bieden op maat gemaakte concepten. Onze zuivelkennis in deze relatief kleine organisatie maakt ons dynamisch en geeft ons slagkracht bij nieuwe concepten en innovaties.”




22 ZUIVEL IN ZICHT / 2022 INDUSTRIE / NEDERLAND
René van der Vleuten Joost van Boxtel
Rob Branje
Roel Peters
Powder
Sales: Stationsplein 63 , 1703 WE Heerhugowaard 072-5020946 Productie: Postbus 22, 4870 AA Etten-Leur 076-5022247 info@goatmilkpowder.com www.goatmilkpowder.com
Sybren Ewijk, Franck van
Sales: Patrick Heens
Goat Milk
B.V.
Management:
Dalen
Zuivelonderneming Goat Milk Powder B.V. is een joint venture tussen geitenkaas producent Bettinehoeve B.V. uit Etten-Leur en (biologische) geiten- en schapenzuivelproducten exporteur AVH dairy trade B.V. uit Heerhugowaard.
Beide bedrijven zijn dochterondernemingen van Emmi uit Zwitserland. De geitenmelkfabriek van Goat Milk Powder, is in juni 2014 in gebruik genomen. De verwerkingscapaciteit is 5 ton melk per uur. In de zuivelfabriek wordt de verse geitenmelk en geitenwei aangeleverd door de Bettinehoeve B.V. en verwerkt tot hoogwaardige ingrediënten zoals (biologische) volle melkpoeder en WPC55, waarbij de kwaliteit van de producten de hoogste prioriteit heeft.
AVH dairy trade B.V. is verantwoordelijk voor de wereldwijde business-to-business verkoop en marktontwikkeling van deze poeders, die door de klanten kunnen worden verwerkt in toepassingen zoals babyvoeding, sportvoeding, geriatrische voeding en voedingsmiddelen in het algemeen.
Goat Milk Powder B.V. heeft gekozen om haar fabriek geheel koemelkvrij te houden. Het voordeel van koemelkvrij produceren is dat er geen koemelkresidu in het eindproduct kan voorkomen. Dit is een unique selling point voor de bovengenoemde toepassingen.
Zuivelfabriek De Graafstroom
Dorpsstraat 18, 2971 AD Bleskensgraaf 0184-430050 (fax 691718) Info@degraafstroom.com www.degraafstroom.com
Management: R.M. Noordermeer (Algemeen Directeur), M.C.H.G. Knulst (Financieel Directeur). Bestuur coöperatie: H.J. van der Wind (voorzitter), A.J. van Rees (lid), E.C. Peek (secretaris), J.G.M. de Bruin (lid), J.C. Wesselingh (lid).
Zuivelfabriek De Graafstroom is de handelsnaam van Zuivelcoöperatie DeltaMilk B.A. In deze coöperatie zijn circa 190 innovatieve melkveehouders uit het Groene Hart en omstreken verenigd. Zij werken met passie voor zuivel en voelen zich sterk betrokken bij de eigen moderne kaasmakerij, waarin circa 45.000 ton kaas per jaar wordt geproduceerd. De kernwaarden vakmanschap, ondernemerschap en rentmeesterschap staan in het handelen van de coöperatie centraal.
Zuivelfabriek De Graafstroom is gespecialiseerd in de productie van natuurgerijpte Goudse kaas in zowel wielen als rechthoeken. Het assortiment omvat naast de traditionele kazen ook laag-vet kazen, allen in diverse soorten en recepturen. Kwaliteit staat hoog in het vaandel bij De Graafstroom en dit blijft niet onopgemerkt. Al verschillende keren werden de kazen bekroond met de hoogst mogelijke onderscheidingen wereldwijd.
De Graafstroom gaat voor een langdurige samenwerking met haar partners, zowel in binnen- als buitenland. Voor retailers is De Graafstroom een gewaardeerde private label partner. De klantwensen centraal stellen is daarbij het uitgangspunt. Door een korte timeto-market is De Graafstroom in staat om snel klant specifieke recepturen te ontwikkelen en in de markt te zetten. De Graafstroom is in het bezit van de certificeringen: IFS, FSSC 22000, Q-Cert 22000, GMP+, ISO 14001, HALAL, Stichting Weidegang en Vegetarisch (op productniveau).
23 ZUIVEL IN ZICHT / 2022 INDUSTRIE / NEDERLAND
Henri Willig Groep
Hoogedijk 8, 1145 PM Katwoude 0299-65 51 51 Venus 18, 8448 GW Heerenveen 0513-484360 sales@henriwillig.com www.henriwillig.com

Management: Wiebe Willig (Algemeen Directeur), Martin Willig (Financieel Directeur), Nieske Jaspers (Commercieel Directeur), Erik Hollander (Marketing Directeur), Eric Jan Diederix (Plant Manager), Ronald Ras (Plant Manager), Anneke de Valk (Manager KAM), Marc Koetsier (Retail Directeur), Martine Thijs (HR Manager), Paul Belema (IT Manager).
Visie
De wereld inspireren met Henri Willig Kaas
Activiteiten
Henri Willig nam in 1974 het boerenbedrijf over van zijn ouders en startte met de productie van boerderijkazen. De Henri Willig Groep produceert nu in twee kaasmakerijen en is uitgegroeid tot een toeristische topattractie. De kazen worden geproduceerd in Katwoude en Heerenveen.

Henri Willig verwerkt koe- schapen- en geitenmelk zowel conventioneel als biologisch. Naast Goudse kaas worden ook diverse (kruiden) specialiteiten geproduceerd. Ook voert Henri Willig een breed assortiment babykaasjes. Vanuit eigen ontwikkeling en samen met afnemers zijn er inmiddels ruim 50 kaasvariëteiten op de markt gebracht. Er wordt voortdurend aan nieuwe unieke smaakcombinaties gewerkt.
Bekende eigen merken zijn Henri Willig® en Hooidammer®
De afzet is gericht op groothandel, retail en foodservice. De kazen worden in Nederland verkocht maar ook geëxporteerd naar meer dan 30 landen. Daarnaast wordt de kaas afgezet via meer dan 30 eigen winkels, kaashoeves, met de naam Cheese & More by Henri Willig en Henri Willig Cheese Farm (Store), welke jaarlijks door miljoenen mensen worden bezocht.
Wiebe Willig
Missie
Henri Willig Groep brengt als kaasmaker eerlijke en onderscheidende kwaliteitsproducten naar de consument en is een professionele en duurzame partner voor zijn afnemers, medewerkers en leveranciers, met respect voor mens, dier en natuur.

24 ZUIVEL IN ZICHT / 2022 INDUSTRIE / NEDERLAND
Hochwald Foods Nederland B.v.

Jacques’ Kruidenboter B.V.

Harlingerstraat 65, 8701 WR Bolsward 0515-578888
www.hochwald.de
Directie: D. Latka (algemeen directeur), K. Elzinga (fabrieksdirecteur)
Hochwald Foods Nederland B.V. is de Nederlandse dochteronderneming van Hochwald Foods GmbH in Thalfang (Duitsland), de werkmaatschappij van één van de grootste Duitse zuivelcoöperaties, Hochwald Milch eG, met internationale ambitie. De zuivelfabriek in Bolsward bestaat uit twee fabrieken, een melk- en een blikfabriek. De zuivelactiviteiten van de onderneming bestaan uit de productie van: (gesuikerde) gecondenseerde melk in klein- en grootverpakking, gesteriliseerde room in kleinverpakking, Ready to Drink producten (iced coffee, gearomatiseerde melkdranken) en koffiemelk in glazen flesjes. De blikactiviteiten bestaan uit de productie van blikverpakkingen en componenten voor eigen gebruik en voor babyvoeding voor derden.
Pastoor Koopmanweg 7 1784 NX Den Helder 0223-633771 (fax 633101) info@jkbfoods.com
Management: W. van der Linde (algemeen en commercieel directeur), G. van Malkenhorst (Salesmanager Benelux, retail en foodservice)
Jacques’ Kruidenboter B.V. ontwikkelt, produceert en vermarkt kruidenboter/ kruidencrème, mediterrane producten (o.a. op basis van feta) en kaasspecialiteiten (o.a. kaassalade en diepvries kruidenboterrozetten). De afzet is gericht op de retailmarkt, groothandel, catering/institutioneel en industrie in Nederland en enkele geselecteerde exportlanden. Ook produceert Jacques’Kruidenboter B.V. (diepvries) smaak/saus pellets als halffabrikaat voor vlees, groenten, bakkerij en kant-en-klaar-maaltijdenindustrie. De producten worden onder eigen merk en private label vermarkt.
Merken: Jacques’ Kruidenboter, Beurre Trèfle, Solataki en Solamar.
25 ZUIVEL IN ZICHT / 2022 INDUSTRIE / NEDERLAND
Kaptein PCF
Postbus 2, 1474 ZG Oosthuizen 0251-664800 info@kaptein.info www.kaptein.info
Kaptein Processed Cheese Factory (voorheen Eyssen), opgericht in 1883, is een belangrijke producent van smeltkaasproducten in Nederland en ver daarbuiten. Kaptein PCF focust zich op 4 kernproducten: smeerkaas, blokkaas, rookkaas en industriële kaas. De kracht van Kaptein PCF zit in de constante levering van hoge kwaliteit smeltkaasproducten en in-house productie. Daardoor kunnen we flexibel en accuraat inspe len op de behoeften van onze klanten. Kaptein PCF is BRC en IFS gecertificeerd.
Kaasmakerij Özgazi
Aktürk
Corebusiness
Het produceren van zachte witte kaas (“feta type”)in o.a. blikverpakking onder eigen merk en private label houders. Zowel traditionele kaas receptuur als analoge kaas (combi). Dit alles in consumentenverpakking als industriële verpakking. In blik of vacuüm verpakt. Kubusjes kaas, blokken van 2 kg of plakken van 200 gram. Daarnaast produceert Özgazi ook Ayran en Turkse Yoghurt in diverse gewicht verpakkingen van 1 kg tot 10 kg en Tulum.
Activiteiten
Kaasmakerij Özgazi verwerkt op jaarbasis ca 80 miljoen kilogram melk. Een groot gedeelte van deze melk is op contractbasis vastgelegd. Een beperkt deel wordt uit de vrije handel gekocht. Uniek is de productie van zowel koemelk als ook geitenmelk en schapenmelk in dezelfde zeer moderne coagulator.
Nijverheidsweg 39, 4879 AP Etten-Leur 076-5036992 (fax 5036919) info@ozgazi.com www.ozgazi.com


Management: Serif Aktürk (algemeen directeur), Vural Aktürk (adjunct directeur/ bedrijfsleider), Ozkan Polatli (financieel manager), Harry Kil (commercieel directeur)
De geitenmelk is van Nederlandse herkomst; de schapenmelk wordt uit Frankrijk betrokken. Om de label houders van een volledig assortiment te kunnen voorzien worden Goudse Foliekazen aangekocht, versneden en verpakt onder de diverse labels.
Özgazi produceert de zuivelproducten voor een 20- tal Private Label houders, die hun producten wereldwijd afzetten.
Het bedrijf is continue op zoek naar productontwikkelingen en verpakkingsmogelijkheden om de afzetmarkt van de label houders te verbreden.
26 ZUIVEL IN ZICHT / 2022 INDUSTRIE / NEDERLAND
Serif
Royal Lactalis Leerdammer B.V.
Steenovenweg 4, 4145 KK Schoonrewoerd Postbus 1306, 4145 ZG Schoonrewoerd 0345–648390
www.lactalisleerdammer.nl
General Manager: Jan Verbessem

Bij Royal Lactalis Leerdammer B.V. maken wij kaas: Leerdammer en meer! Dat doen we met ruim 420 collega’s, verdeeld over drie locaties in Nederland. In onze fabrieken in Schoonrewoerd en Dalfsen wordt de melk van zo’n 950 melkveehouders uit de regio verwerkt. In de fabriek in Wageningen wordt de kaas versneden en verpakt. In Schoonrewoerd is het hoofdkantoor en het Research & Development centrum gevestigd. Royal Lactalis Leerdammer B.V. is onderdeel van Groupe Lactalis, een wereldwijde speler op de zuivelmarkt.
Productielocaties: Schoonrewoerd: Steenovenweg 4, 4145 KK Schoonrewoerd 0345-648390
Dalfsen: Rondweg 9, 7721 AA Dalfsen 0345-648390 Wageningen: Nudepark 101, 6702 DZ Wageningen 0345-648390
Klaver Kaas BV

Agripoort 181, 1775 TA Middenmeer 0224–540148 info@klaverkaas.nl www.klaverkaas.nl
Bedrijfsomvang: 30 werknemers Directie: M. Klaver (contactpersoon)
Productie van Noord Hollandse Kaasspecialiteiten Onafhankelijk van de markt beschikt Klaver Kaas B.V. over de aanvoer van verse koe- of geiten melk vanuit eigen veestapel. Dagelijks wordt de melk verwerkt tot een uiteenlopend gamma aan ambachtelijke Noord-Hollandse Kaasspecialiteiten van het zuiverste zuivel. De productie Klaverkaas B.V. is HACCP, Skal en FSCC22000.
27 ZUIVEL IN ZICHT / 2022 INDUSTRIE / NEDERLAND
Jan Verbessem
LaBan Foods BV
Labeij Food Products


Spanjeweg 20, 2411 PX Bodegraven 0172-613220 post@labanfoods.nl www.labanfoods.nl
Met een breed assortiment kwalitatief hoogwaardige producten is LaBan Foods al jaren in Nederland de boterspecialist. Vanuit een modern productiepand in Bodegraven vinden dagelijks vele duizenden verpakkingen met roomboter, kruidenboter, kruidencrème en aanverwante artikelen een weg naar supermarkten, horeca en groothandels.
U kunt bij LaBan Foods terecht voor al uw vraagstukken op het gebied van roomboter of kruidenboter.
De Bleken 4 5245 NJ Rosmalen 073-6900191 (fax 6900193) info@labeij.nl www.labeij.nl
Producent van diverse voorgebakken kaasproducten, alsook vleesvullingen en toppings op basis van kaas, zoals bijvoorbeeld cordon bleuvullingen. Specialisme van Labeij Food Products is het machinaal vormen en afbakken van kaasproducten, zowel regulier als biologisch.
Eigenaren: Frank Lagas en El Pescado
28 ZUIVEL IN ZICHT / 2022 INDUSTRIE / NEDERLAND
Lekkerkerker Food
Nestlé Nederland


Handelsweg 2 3411 NZ Lopik 0348-558080 customerservice@lekkerkerkerfood.nl www.lekkerkerkerfood.nl
Nestlé Nederland Stroombaan 14, 1181 VX Amstelveen 020-5699323

www.nestle.nl
Directie: Nikki Adamo

Lekkerkerker Food is dé specialist op het gebied van kaasvullingen, bereidingen met kaas zoals kaassaus, smeerkaas, zuivelaroma’s, (vegetari sche) roomkaas of vegan alternatieven. Wij leve ren producten onder het Lebo merk en ontwik kelen klantspecifieke oplossingen voor de retail, food service en industriële markt. Lekkerkerker Food is onderdeel van de Lekkerkerker Groep. Per 1 juni jl. opereren Lebo Kaas B.V. en Kasi Food B.V. onder de nieuwe naam Lekkerkerker Food.
Nestlé is ‘s werelds grootste voedingsmiddelenproducent. We zijn in 189 landen wereldwijd aanwezig en onze 328.221 medewerkers zijn gecommitteerd aan Nestlé’ s missie om de kwaliteit van leven te verbeteren en bij te dragen aan een gezondere toekomst. Wij richten ons met deze missie op individuen en gezinnen, leefgemeenschappen en de planeet. Nestlé biedt een breed portfolio van producten en diensten waar mensen en hun huisdieren ieder moment van de dag van kunnen genieten. De bijna 2000 merken variëren van wereldwijd iconische merken als NESCAFÉ en NESPRESSO tot en met lokale favorieten als BROS. In Nederland wordt een breed scala aan merken verkocht, zoals MAGGI, GARDEN GOURMET, KITKAT, Nestlé babyvoeding zoals LITTLE STEPS, NESTLÉ PyjamaPapje en GERBER Organic for Baby, alsook water, waaronder SAN PELLEGRINO en VITTEL, en voeding voor honden en katten zoals FELIX, BONZO en Purina ONE. Nestlé is sinds haar oprichting meer dan 150 jaar geleden gevestigd in het Zwitserse Vevey. Het Nederlandse hoofdkantoor is gevestigd in Amstelveen en onze babyvoedingsfabriek in Nunspeet. Voor Nestlé Nederland werken ruim 1100 mensen.
29 ZUIVEL IN ZICHT / 2022 INDUSTRIE / NEDERLAND
Management: Jasper Swart (Sales manager), Bert Rijk (Senior accountmanager Industrie), Daan Hermens (Accountmanager Food Service)
Daan Hermens Bert Rijk
O.D.I. de Dageraad BV
Raad van beheer: B. Kooiker (voorzitter), H.J. van Leusen (vicevoorzitter)
Directie: K. Hokse (CEO), B. Gubler (CFO), T. Wienholts (COO)
Management: J. Blankespoor (manager pro gramma’s en processen), B. Brand (commercieel manager), B. Pepping (HR-manager)
Vensestraat 47, 6599 AN Ven-Zelderheide 0485-513055 (fax 515809) info@aurora-kaas.com www.aurora-kaas.com www.vivanaturakaas-cla.com
Directie: H.J.M. ten Dam, A.M.A.T. ten Dam-Rijnen O.D.I. de Dageraad produceert onder de merknaam Aurora diverse soorten koekaas, met en zonder kruiden. In het assortiment zit verder geraspte kaas en foliekaas. Onder de merknaam Aurora worden ook geiten- en schapenkaas geproduceerd. Verder produceert de onderneming Vivanatura kaas met extra natuurlijke omega 3 en CLA, naturel en met honingklaver. Alle kaas is biologisch en wordt geleverd onder EKO, Bioland en Demeter-merk. De kaasmakerij O.D.I. de Dageraad is HACPPgecertificeerd.


CZ “Rouveen” u.a.
K. Hokse
Oude Rijksweg 395, 7954 GH Rouveen 0522-298222
info@rouveenkaas.nl www.rouveen-kaasspecialiteiten.nl
Rouveen Kaasspecialiteiten is de meest veelzijdige kaasproducent van Europa. De missie om met een hoogwaardig assortiment van unieke kwaliteitskazen een melkprijs voor de leden-veehouders te realiseren die boven de algemeen aanvaardbare melkprijs ligt wordt gerealiseerd door middel van de drie kernactiviteiten innovatieve productontwikkeling, vakmanschap en biologische kaas. Er worden meer dan 400 soorten kaasspecialiteiten ontwikkeld en geproduceerd bij Rouveen Kaasspecialiteiten in Rouveen en bij Bio Kaas in Molenschot. Hiervoor wordt gebruik gemaakt van verschillende soorten melk en een oneindig scala aan toevoegingen, waaronder groente, fruit en specerijen. Daarmee worden Goudse type kazen verkocht met toevoegingen zoals boerenkool, aardbei, mosterd, kokos en truffel, en ook diverse soorten blauwschimmel, roodschmier en witschimmel kazen. Al deze kaas is verkrijgbaar onder private label én onder het biologische merk Bastiaansen Bio. Rouveen Kaasspecialiteiten, bij Koninklijke beschikking Hofleverancier, is in het bezit van
30 ZUIVEL IN ZICHT / 2022 INDUSTRIE / NEDERLAND
onder meer een Qlip procescertificaat, Skal, IFS (higher level) en BRC certificering en produceert ook demeter, weidegang, BGA, kosher en halal producten. Bio Kaas is gecertificeerd voor IFS, demeter en biologische kaas.
Bio Kaas BV
Aardstraat 31, 5124 RW Molenschot 0161-432357 info@bastiaansen-bio.nl www.bastiaansen-bio.com
Veco Zuivel BV
Werktuigweg 37 3899 AN Zeewolde 036-5494000 www.vecozuivel.com www.vecozuivel.nl www.flevomel.nl www.Betsiesgeitenzuivel.nl www.bessolakrentjebrij.nl
Directie: Hans van Tilbeurgh, algemeen directeur.
Commercie: Michiel Keijzer (B2B), Arthur Kalter (Retail), Edgar Leblans (New Business/Export Overseas)
Bij Veco Zuivel in Zeewolde wordt dagelijks rauwe boerderijmelk verwerkt tot dagverse consumptie-zuivelproducten, welke voornamelijk onder private label terug te vinden zijn in het koelschap van de verschillende supermarktketens in Nederland.
Veco Zuivel is in 1974 gestart op een boerderij in Leusden en in 2009 in Zeewolde verder gegaan als familiebedrijf in een eigen fabriekspand. Veco Zuivel is sinds 2022 onderdeel van Farmel Dairy Business en loopt voorop bij het verwerken van meerdere bijzondere melkstromen tot verschillende hoogwaardige zuivelproducten voor m.n. retail. Ook zijn er verschillende B2B oplossingen.
Naast koemelkproducten zijn ook het geitenzuivel merk Betsie’s en het dessert Bessola Krentjebrij onderdeel van de productportfolio. In 2012 is Veco Zuivel begonnen met de export van zuivelproducten naar China en Zuid-Oost Azië.
Bij Veco Zuivel werken dagelijks ca. 80 medewerkers met zorg, passie en enthousiasme aan de kwalitatief hoogwaardige zuivelproducten.
Vika BV
Nizolaan
31 ZUIVEL IN ZICHT / 2022
INDUSTRIE / NEDERLAND
4, 6718 ZC Ede 0318-619042 ede.cs@givaudan.com www.givaudan.com
Vika BV produceert smeltkaaspoeder, kaas is één van de meest gebruikte toepassingen in hartige koekjes, chips, sauzen etc over de hele wereld. Vika levert dan ook van Nederland tot China, als onderdeel van Givaudan zijn vele markten opengegaan voor Vika’s smeltkaaspoeder.
Royal VIVBuisman
Vreugdenhil Dairy Foods
Arkerpoort 5, 3861 PS Nijkerk Postbus 64, 3860 AB Nijkerk +31 33 303 5000 info@vreugdenhil.nl www.vreugdenhil.nl
Bestuur: J. Vreugdenhil (Chairman) Directie: A.P. de Groot (CEO)


De Kroon 21
Postbus 1, 4260 AA Wijk en Aalburg 0294-233054 info@royalvivbuisman.nl www.royalvivbuisman.nl

Royal VIVBuisman is een producent van hoog waardige melkvet producten zoals roomboter, boterconcentraat, ghee, en gefractioneerd melk vet. Naast bulkverpakking kunnen deze ook gele verd worden in formaten voor de foodservice en consumentenmarkt; bijvoorbeeld blikken, kuipjes, pakjes, rollen en 3D boterfiguren.
Royal VIVBuisman is samen met zusterbedrijf Van der Pol onderdeel van Van Ballegooijen Foods. Een familiebedrijf met focus op het maken en verwerken van boter.
Van links naar rechts: J. Vreugdenhil en A.P. De Groot Iedere dag genieten wereldwijd miljoenen mensen van zuivel en zuivelingrediënten van Vreugdenhil Dairy Foods. Consumenten gebruiken onze melkpoeder voor een gezond glas melk, omdat die vers, voedingsrijk en smaakvol is. Bovendien is de poeder lang houdbaar en uitstekend oplosbaar in warm en koud water. Daarnaast zijn melkpoeders van Vreugdenhil Dairy Foods een hoogwaardig ingrediënt voor kindervoeding en voor producten als ijs, chocolade en koek.
Hoogste kwaliteit
Dankzij onze jarenlange ervaring in het produceren en distribueren van melkpoeder, kennen wij de zuivelketen als geen ander.
32 ZUIVEL IN ZICHT / 2022 INDUSTRIE / NEDERLAND
Wij beheren de hele keten en beschikken over de beste melk, afkomstig van onze 850 Nederlandse melkveehouders. Dankzij hen leveren we het hele jaar door melkpoeder van de beste kwaliteit. Wij gaan zorgvuldig om met grondstoffen, natuur, mensen en dieren, en de melkpoeders voldoen aan de strengste eisen op het gebied van kwaliteit en hygiëne. U kunt bij Vreugdenhil Dairy Foods terecht voor een product dat precies voor uw toepassing op maat is gemaakt. Ook aan speciale eisen als halal of biologische melkpoeder kan Vreugdenhil voldoen. Vreugdenhil Dairy Foods exporteert melkpoeders naar ruim 130 landen wereldwijd. We bring you the best of milk!
Weerribben Zuivel

zuivelproducten, welke verkocht worden onder het merk Weerribben Zuivel in onder andere de biologische speciaalzaken en betere horeca. De biologische melk komt van de Weerribben boerderijen in natuurgebied Weerribben-Wieden en draagt het Echte Boerderijzuivel logo. Het assortiment bestaat uit o.a. melk, yoghurt, kwark, vla, pappen, Kefir, roomproducten, boter en kaas, in diverse verpakkingen voor zowel de consument als grootverbruik en industrie. Sinds 2016 verwerkt Weerribben Zuivel ook de biodynamische melk van 25 Demeter veehouders tot een assortiment Demeter zuivelproducten onder haar merk Zuiver Zuivel. Onder andere melk, yoghurt, kwark, kefir, boter en kaas worden geleverd aan de biologische speciaalzaken.
Sinds 2018 heeft Weerribben Zuivel een aparte boterfabriek, waar uitsluitend biologische en biodynamische boter wordt geproduceerd. Deze wordt verpakt in consumentenverpakkingen (pakjes, rolletjes), en grootverpakkingen (10kg, 25kg, plakken 2 kg) voor industriële toepassingen en bakkerijen. Deze boter wordt geleverd aan klanten in heel Europa.
Weerribben Zuivel is FSSC22000, biologisch en Demeter gecertificeerd.
Weerribben Zuivel BV is gestart als een boerderijzuivel verwerker. Nog steeds wordt de eigen biologische melk bij de boerderij verwerkt tot een breed assortiment ambachtelijke boeren
33
Veldhuisweg 9 8362VB Nederland (Ov) 0527 29 25 29 contact@weerribbenzuivel.nl www.weerribbenzuivel.nl www.zuiverzuivel.nl
Contactpersoon: Edwin Crombags (commercieel manager)
ZUIVEL IN ZICHT / 2022 INDUSTRIE / NEDERLAND
Yakult Europe BV
Schutsluisweg 1, 1332 EN Almere 036-5211300 www.yakulteurope.com
Directie: H. Matsubara (Managing Director)
Yakult is een internationaal bedrijf en producent van levensmiddelen, cosmetica en farmaceutica met vestigingen in 39 landen. Yakult is opgericht door de Japanse wetenschapper dr. Minoru Shirota die het bekende kleine flesje in 1935 voor het eerst introduceerde in Japan. Het hoofdkantoor, Yakult Honsha Co. Ltd, is in Tokio, Japan. In Europa heeft het bedrijf Yakult sinds 1994 zuivelproducten met bacteriën op de markt: Yakult, vanaf 2002 Yakult Light en sinds maart 2014 Yakult Plus. Het Europese hoofdkantoor en productielocatie van Yakult, Yakult Europe B.V. is gevestigd in Almere. Yakult Europe B.V. is een dochter van Yakult Honsha Co. Ltd. De marketing en sales van Yakult in Europa wordt gedaan door de vestigingen:
Vestigingen
Yakult Nederland B.V. Handelsweg 59H 1181 ZA Amstelveen Nederland www.yakult.nl Directie: P. Dekkers, Managing Director
Yakult Belgium NV/SA
The Crescent Lenniksebaan 451 1070 Brussel
België www.yakult.be Directie: B. Degeest, Managing Director
Yakult Deutschland GmbH Forumstraße 2, D-41468 Neuss Duitsland www.yakult.de Directie: T. Hirano, Managing Director

Yakult UK Ltd Anteros, Odyssey Business Park, West End Road HA4 6QQ South Ruislip, Middlesex Groot Brittanië www.yakult.co.uk Directie: H. Yoshimura, Managing Director
Yakult Ireland Suite 215, The Capel Building Mary’s Abbey Dublin 7 Ierland www.yakult.ie Directie: H. Yoshimura, Managing Director
Yakult Österreich GmbH
ALBERT HALL Business Center Albertgasse 35 A-1080 Wien www.yakult.at Directie: H. Matsubara, Managing Director
Yakult Italia srl
Via Vincenzo Monti, 51 20123 Milano, Italië www.yakult.it Directie: M. Bonati, General Manager
34 ZUIVEL IN ZICHT / 2022 INDUSTRIE / NEDERLAND
Zuiverculinair Exloo BV
Noorderkijl 19, 9571 AR 2e Exloërmond 0599-672187
info@zuiverculinair.nl www.zuiverculinair.nl
Contact: E. Weerink
Wij produceren bijzondere sauzen en dressings. Bijzonder omdat ze zuiver zijn. Anders dan vele andere sauzen en dressings; gemaakt op basis van plantaardige olie en eigen bereide verse yoghurt. Verse groentes en kruiden, scharreleieigeel, verantwoord gemaakt en alle ingrediën ten zijn voor zover mogelijk van dichtbij en niet te vergeten, wij werken volledig glutenvrij. Heel zuiver dus.
Merken: Sooo, private label. Het bedrijf is FSSC22000 gecertificeerd.
Zuivelhoeve B.V.
Bruninksweg 5a, 7554 RW Twekkelo 074-2424907 info@zuivelhoeve.nl www.zuivelhoeve.nl


Contact: Jacqueline Roerink – Zuivelhoeve Jorieke en Diane Roerink – Zuivelhoeve winkels

Zuivelhoeve is een Twents familiebedrijf waar sinds 1981 dagelijks met passie wordt gewerkt aan het maken van de allerlekkerste zuivelproducten. De kern van toen is de basis van vandaag, nog steeds maken we op onze boerderij in Twekkelo met gepaste trots, échte toegevoegde waarde zuivel. Afgelopen jaar hebben we onze hoeve uitgebreid met in totaal 8000 duurzame vierkante meters. Duurzaam en generatiebestendig, zo zijn we energieneutraal onder andere door 2.700 zonnepanelen, hebben we een eigen biologische retentievijver waardoor het gezuiverde afvalwater terechtkomt in het lokale bekennetwerk en past het 100% in ons groene Twentse landschap door het gebruik van inheems eikenhout als wandbekleding. Naast onze welbekende emmertjes, kun je ons ook kennen van onze Zuivelhoeve winkels.
In de afgelopen jaar zijn wij vanuit onze boerderijwinkel uitgegroeid naar een landelijke franchise organisatie met ruim 80 winkels verspreid door heel Nederland.
In onze winkels bieden wij naast onze NoordHollandse kazen en de meest smaakvolle boerenkazen ook een ruim assortiment aan buitenlandse kazen. Kazen, vers van het mes, en onze noten worden dagvers gebrand ook verkopen wij andere delicatessen zoals olijven, tapenades, verschillende worstsoorten en natuurlijk onze eigen Zuivelhoeve zuivel. Jorieke Roerink: ‘’Wij geloven er in dat eten alleen lekker en gezond is als het met liefde en kunde is gemaakt, met een directe verbinding tot de bron’’. Eerlijk smaakt het lekkerst! Vind meer informatie of bezoek onze webshop op: www.zuivelhoeve.nl
35
Jacqueline Roerink
ZUIVEL IN ZICHT / 2022 INDUSTRIE / NEDERLAND
Jorieke Roerink
Butterei Pur Natur AG
CAPRA s.a.

Im Kips 1 4760 Büllingen 0032-437-634207 www.butterei-purnatur.be
In oktober 2013 nam NV Pur Natur alle handelsactiviteiten van Butterei Büllingen over onder de naam van butterei Pur Natur. Hiermee behoort Pur Natur tot één van de laatste bedrijven die karnemelk produceren in Europa en is het bedrijf een unieke Belgische speler in de échte verse trommelkarneboter, vanzelfsprekend geproduceerd op traditionele wijze in karntonnen.
Contact: info@butterei-purnatur.be
Chimay Fromages
Route Charlemagne 3 B-6464 Chimay Baileux 0032-60-210450 (fax 213855) chimay-fromages@chimay.com
Contact: Xavier Pirlot en Sévrine Toussaint
Coferme S.C.
Zone Industrielle B-6464 Bailleux 0032-60-214730 (fax 213243) coferme@swing.be
Contact: B. Wauthy
Stadsbeemd 1021, B-3545 Halen 0032-13-461799 (fax 461897) www.capra.be
Directie: Guy Hex (algemeen directeur) Contact: info@capra.be
Productie en verkoop van producten op basis van geitenmelk. Geitenwrongel, -bûches en -specialiteiten. Verwerkingscapaciteit: 60 miljoen liter geitenmelk. Grootste verwerker in België en Nederland.
Corman SA
Route de la Gileppe 4, 4834 Goé 0032-87-342211 (fax 763825) corman@corman.be www.corman.be www.balade.be www.carlsbourg.be www.lechef.be
Management: Bernard Fromage (algemeen directeur), Jean-Marc Schevenels (artisanale en Professionele Gebruikersproducten), Léon Locht (consumentenproducten), Serge Adans (financiën), Jean-Marc Schevenels (human resources), Denis Pismont (industrie), Daniel Busch (industriële producten), Alain Lambert (inkoop), Didier Kariger (juridisch), Jean-François
36 ZUIVEL IN ZICHT / 2022 INDUSTRIE / BELGIË
ECO BIO
butterei ORGANIC
Cavrenne (kwaliteit & Veiligheid), Jean Salgi (marketing), Marleen Vanrusslt (research & development), Luc Gérardy (supply chain)
Wij bieden de voedingsindustrie, de professionele verbruikers en de eindverbruikers een breed assortiment van: technologisch bewerkte boter en room, watervrije melkvetten, boterconcentraten en melkerijboter.
Een greep uit ons assortiment : boter met aangepaste hardheid voor het maken van koekjes of luxebroodjes, smeerbare boters, boter en room met een verlaagd vetgehalte of cholesterolarm.
Onze producten worden vervaardigd volgens een natuurlijk procédé op basis van eerste keus room of boter, die uitsluitend fysisch worden bewerkt. Dankzij de alom gewaardeerde kwaliteit van onze producten en diensten zijn wij marktleider geworden op het gebied van melkvetten.
Fromunion NVKaasmakerij Passendale
Statiestraat 111, B-8980 Passendale 0032-51-788080 (fax 788099) info@kaasmakerijpassendale.be www.passendale.be
Ronny Verhé (Plant Manager)
Core business: kaasspecialiteiten
Wij staan garant voor duurzame ontwikkeling van halfharde kazen op basis van koe-of geitenmelk, via witschimmel-, gewassen korsten grootkazentechnologie, voor zowel eigen merken als private labels in West-Europa. In ons kwaliteitsbeleid staan klantentevredenheid,
voedselveiligheid en duurzaam ondernemen met respect voor het milieu centraal.
NV INEX
Meulestraat 19, B-9520 Bavegem 0032-9-3638282 www.inex.be info@inex.be
Directie: C. Gilain-Pycke (afgevaardigd bestuurder), S. Dierickx (Algemeen directeur) J. Geeroms (CFO), A. De Clercq (HR)
Inex is een Belgische zuivelgroep gelegen in Bavegem (Wetteren) die de volledige waaier zuivelproducten aanbiedt zowel vers als lang houdbaar en dit in de meest moderne en verscheidene verpakkingsvormen. Jaarlijks wordt ruim 250 miljoen liter melk verwerkt waarvan de helft wordt geëxporteerd. De Inex-Groep is gestaag gegroeid, telt 450 medewerkers en heeft een jaarlijkse omzet van 200 miljoen euro.
St. Jozef CV
Maaseikerlaan 28, B-3680 Neeroeteren/ Maaseik 0032-89864001 (fax 867994) leon.hulsbosch@zuivelfabriekstjozef.be www.zuivelfabriekstjozef.be
Contact: Leon Hulsbosch (verantwoordelijke)
Rue des Vétérinaires 42F, B-1070 Brussel 0032-2137811 info@lactalis.be
37 ZUIVEL IN ZICHT / 2022 INDUSTRIE / BELGIË
Produits
Lactalis Nestlé
Frais SA/NV
NV LACTIS Pur Natur SA
Laiterie Socabel S.A.
Rue de la Rochette 14, B-6900 Marche en Famenne 0032-84-311862 (fax 315034) socabel@walhorn.be
Bergensesteenweg 706 B-1600 Sint-Pieters-Leeuw 0032-2-3612900 (fax 3603567) info@lactispurnatur.be www.lactispurnatur.be
Directie: Luc De Baeremaeker (afgevaardigd bestuurder)
Zuivelbedrijf LACTIS Pur Natur is een privaat zuivelbedrijf dat over een eigen gangbare en biologische melkophaling beschikt en de melk verwerkt tot dagmelk, slagroom en industriële producten. De onderneming heeft een eigen distributieorgaan voor een volledig productenpakket.
Limelco NV
Genkerbaan 75, B-3520 Zonhoven 0032-11-819120 (fax 812615) info@limelco.be www.thedairyfoodgroup.com
Omzet 2020: 210 Mio EUR, waarvan 120 miljoen euro Limelco Melkaanvoer 2020: 185 miljoen liter
Directie: Guy Bogaerts – Plant Manager
Kurt Brouwers – QESH Manager
Paul Ceuppens – Sales Manager
Olivier Quetin – Finance Manager, Milk collection Joël Budo – ManagerTechniek, investeringen & Aankoop
Limelco is gespecialiseerd in de productie van verse kaas, verse desserten, langhoudbare desserten, melkdranken en industriële melkpoeders. Limelco NV produceert enerzijds private labels voor de supermarkten en anderzijds merkproducten voor de grote multinationals.
38 ZUIVEL IN ZICHT / 2022 INDUSTRIE / BELGIË
ORGANIC ECO BIO
Lactis
Milcobel cvba
Fabriekstraat 141, B-9120 Kallo 0032-3-7301800 (fax 7301900) www.milcobel.be
Omzet 2021: 1,14 miljard euro Melkaanvoer 2021: 1,4 miljard liter
Bestuur: Betty Eeckhaut (Voorzitter)
Luc Van Laer (Ondervoorzitter Bedrijfszaken) Vanessa Van Eynde (Ondervoorzitter Coöperatiezaken)
Management: N. van Dam (CEO)
Productiesites:
Diverse melkpoeders
Fabriekstraat 141, B-9120 Kallo 0032-3-7301800
Mozzarella, cheddar, wei-derivaten, melkpoeder, boter
Melkerijstraat 10, B-8920 Langemark 0032-57-490200
Consumentenkazen
Stationsstraat 149, B-8890 Moorslede 0032-51-270600
Kaasservice
DupontCheese
Frank Van Ackerpromenade 15, B-8200 Brugge 0032-50-312826
Camal SA Route de Légipont 12, B-4671 Barchon 0032-4-3456789
Roomijs
Ysco nv Melkerijstraat 10, B-8920 Langemark 0032-57-490300 Ysco SA 53 avenue 2e DB, F-61208 Argentan 0033-2-33364800
Olympia NV
Steenweg Asse 183 B-1540 Herfelingen 0032-54-516060 info@olympiadairy.be www.olympiadairy.be

Omzet 2021: 95 miljoen euro Melkaanvoer 2021: 103 miljoen liter
Bestuur: K. Huygh, L. Van Impe, M. Van Impe
Directie: Operations: K. Podevijn (Operations) F. Decrick (Finance), A. van Volsen (R&D), L. Strybol (Sales), M. Moock (Aankoop)
39 ZUIVEL IN ZICHT / 2022 INDUSTRIE / BELGIË
Activiteiten:
• Aankoop en ophaling van boerderijmelk (100% weidemelk ! )
• Industriële produkten : melk en melkconcentraat , room
• Verse en langhoudbare room en roomspecialiteiten
• Verpakkingen SIG / PE fles / BIB / BIC ..
• Desserts en vullingen
• UHT-produkten en drinks
• Boter
St. Paul NV
Weverslaan 20, B-9160 Lokeren 0032-9-3488119 (fax 3483559) receptie@st-paul.be www.st-paul.be

Directie: D.W.P. Kuijl
Activiteiten: Productie van kaas, smeltkaas, kaasproducten en op kaaslijkende alternatieven ten behoeve van de Europese industriële markt.
NV Pur Natur SA
Hoogstraat 25, B-9770 Kruisem 0032-9-3339399 (fax: 2811868) www.purnatur.eu
Directie : Luc De Baeremaeker (afgevaardigd bestuurder)
De groep Pur Natur Invest bestaat naast de succesvolle vestigingen Pur Natur en MIK in Kruisem ook uit LACTIS Pur Natur in SintPieters-Leeuw, butterei Pur Natur in Büllingen en Compagnie Laitière de Rochefort.
Pur Natur: productie en commercialisatie biologische zuivel, specialiteit yoghurt en verse kaas.
MIK: productie en commercialisatie gangbare zuivel, specialiteit yoghurt, verse kaas.
40 ZUIVEL IN ZICHT / 2022 INDUSTRIE / BELGIË
ORGANIC ECO BIO
SOLAREC S.A.

Rue de Saint-Hubert 75 B 6800 Libramont 0032 (0)61 229 811 info@solarec.be www.solarec.be
Directie: L. Ska (directeur)
Activiteiten: Gevestigd in het hartje van Europa, in de Belgische Ardennen, is de naamloze ven nootschap SOLAREC, actief in de zuivel industrie. Filiaal van de groep “ Laiterie des Ardennes “, de onrderneming verwerkt en verkopt de melk van 2 000 producenten. Elk jaar wordt er 1,35 mil jard liter melk verwerkt en opgewaardeerd tot 99.000 ton melkpoeder, 49 000 ton boter en 220 miljoen liter UHT-melk.
Walhorn S.A.
Chemin de la Laiterie 14, B-4711 Walhorn 0032-87-639163 (fax 639980) info@walhorn.be www.walhorn.be
Omzet 2018: 173 miljoen Melkverwerking 2020: 500 miljoen LT
Bestuur: M. Dédericks (directeur), W. Heyen en P. Lemarchand (productie), R. Franck (administratie)
Met 135 medewerkers produceert het bedrijf melkpoeders, volle, halfvolle en magere UHTmelk, biologische UHT-melk, chocolademelk en UHT-room.
Luxlait Association Agricole
L-7759 Roost / Bissen B.P. 87 L-7501 Mersch 00352-250.2801 (fax 458.566) info@luxlait.lu - www.luxlait.lu
Directie: j.crolla@luxlait.lu
Met meer dan 120 jaar ervaring is LUXLAIT de Luxemburgse zuivelfabriek per excellence. Door een splinter nieuwe moderne fabriek opgericht in 2009 is het mogelijk verschillende productcategorieën te bedienen (vers en lang houdbaar) en een veelheid aan technologieën te verzamelen om de beste producten te leveren. Luxlait werkt met HACCP-normen en zijn ISO 22000, FSSC 22000, IFS Versie 6 en Halal gecertificeerd. We streven altijd naar de top in zuiveltechnologie. De fabriek is gespecialiseerd in de productie en distributie van zuivelproducten met toegevoegde waarde binnen Europa en beschikt over invoervergunningen voor veel regio’s buiten de EU. Specialist in melk en gearomatiseerde melk, gefermenteerde melk, Halfzachte kaas, yoghurt, verse kaas, room, boter, roomijs, enz. Projecten op maat, service en kwaliteit – dat zijn wij.
41 ZUIVEL IN ZICHT / 2022 INDUSTRIE / BELGIË
Agri-Best BV
Aldi Inkoop BV
Pascalweg 21
Postbus 147, 4100 AC Culemborg 0345-478700 (fax 478740) www.aldi.com
Heeseind 21B, 5392 PD Nuland
Postbus 62, 5390 AB Nuland 073-6211633 (fax 6220212) info@agri-best.com www.agri-best.com
Agri-Best BV, opgericht in 1989, is een internationaal opererende handelsonderneming die actief is met een breed pakket zuivelproducten (o.a. melkpoeders, boter, boterolie, kaas en weiderivaten) voor de levensmiddelenindustrie, zowel binnen de EU als daarbuiten. Agri-Best heeft dochterondernemingen in Australië, Egypte en India. Merken: Agri-Best, Best Way, Best-O-Lac, Royal Delite, Royal Frisia
Leiding: Peter van Pinxteren (algemeen directeur)

Albert Heijn BV
Provincialeweg 11
Postbus 3000, 1500 HA Zaandam 075-6599111 (fax 6313030) www.ah.nl
Categorymanagers: Stefan Kastanja (zuivel), Maarten Kerkhof (kaas)
Contact: E.J. Verheul (directeur inkoop)
Alexanderhoeve kaas & noten

Geestdorp 22, 3444 BD Woerden info@alexanderhoevekaas.nl www.alexanderhoevekaas.nl
Contactpersoon: Teo Boer
Alexanderhoeve kaas & noten is een franchise organisatie met 72 winkels in Midden-Nederland. De formule is in 1994 gestart vanuit Boer Kaashandel en Kastino met 15 winkels. De winkels worden bevoorraad vanuit Woerden, waar de Alexanderhoeve al ruim 100 jaar is gevestigd. Eerst als kaasmakerij en nu als rijpingshuis en kaashandel. De formule profileert zich als hoogwaardig in kwaliteit, klantgerichtheid en versbeleving, waarbij de focus ligt op Hollandse en buitenlandse kaas, tapas, wijn en versgebrande noten. Veel winkels hebben hier ook chocolade en andere delicatessen aan toegevoegd. Zowel marketing als administratie wordt voor de ondernemers vanuit Woerden verzorgd.
42 ZUIVEL IN ZICHT / 2022 HANDEL / NEDERLAND
P. van Pinxteren
Alpha Group of Companies
Mr. van Coothstraat 9 - 5141 EP Waalwijk Postbus 457 - 5140 AL Waalwijk 0416–330345 www.alphagroup.nl info@alphagroup.nl
• Alpha Milkpowders Holland: gespecialiseerd in melkpoeder e.a. droge melkproducten.
• Alpha Trading Company: gespecialiseerd in boter, kaas & boterolie (AMF).
• Alpha Food Products: gespecialiseerd in verse eieren voor consumptie.

• Alpha Nutrition: gespecialiseerd in eiwitten, pharmaceutische (DC) lactose, infant formula.
Directie: Remco de Munck, remco@alphagroup.nl Ruud Segeren, ruud@alphagroup.nl
Export: Maurice Bolenius, maurice@alphagroup.nl Geert van Erp, geert@alphagroup.nl Julien Sleutjes, julien@alphagroup.nl Monica Baars, monica@alphagroup.nl Robert Kleinjan, robert@alphagroup.nl
De “Alpha Group of Companies”, opgericht in 1976, is in de loop der jaren uitgegroeid tot een vooraanstaande internationale handelsonderneming met name op het gebied
van zuivel en verse eieren. Producten in industriële verpakkingen (Big Bags, Zakgoed, Drums, Dozen) vormen nog steeds een groot onderdeel van onze business. Daarnaast zijn wij actief in consumentenverpakkingen (tins en sachets van diverse formaten).
Ons team is ervaren, flexibel en heeft kennis van zaken. Dit alles maakt ons een interessante partner voor zowel de in- als verkoop van eerder genoemde producten. Daarnaast verzorgen wij het transport van uw goederen, inclusief de benodigde documentatie voor iedere gewenste eindbestemming wereldwijd.
Eigen merken: Alban / Alpha / ALPHA-Goat / Bright / Champion / Linda / Royale / Farmer Jack / ALPHA-HighPro / AlphaTab
Amsterdam Ingredients B.V.
Wibautstraat 111-H 1091 GL Amsterdam 020-3048467
info@amsterdamingredients.com
Directie: Terence Molnár, Tijmen Fikse Strategisch adviseur: Jan Peter Rotmans
Amsterdam Ingredients is een ambitieuze producent van melkpoeder blends en leverancier van melkpoeder grondstoffen voor levensmiddel en diervoeding applicatie met een specialisatie in melk eiwitten.
43 ZUIVEL IN ZICHT / 2022 HANDEL / NEDERLAND
Ausnutria Dairy Ingredients
Hammerweg 25
7731 AH Ommen 088-5015170
info@ausnutria-dairy-ingredients.com www.ausnutria-dairy-ingredients.com

Ausnutria heeft in totaal al bijna 125 jaar aan historie opgebouwd in de ontwikkeling van zuivelproducten. Daarmee is er ook veel kennis opgebouwd over de verwerking van zuivel, met als doel om zoveel mogelijk positieve eigenschappen van zuivelcomponenten te behouden. Dat maakt onze dochterorganisatie, Ausnutria Dairy Ingredients, een waardevolle samenwerkingspartner gericht op geitenmelkingrediënten. We denken graag mee over (nieuwe) toepassingsmogelijkheden, om zo bij te dragen aan de hoogwaardige eindproducten van onze klanten.
CBM
Onder de merknaam CBM voeren wij een reeks producten met specialistische geitenmelkingrediënten. CBM heeft de wereldwijde markt voor geitenmelkpoeder opgebouwd en is toonaangevend en leidend in de verkoop van ingrediënten op basis van geitenmelk. Vanuit onze eigen productielocaties (o.a. in Kampen, Ommen en Heerenveen) bundelen we onze krachten met die van onze joint ventures en partners. Het CBM-assortiment bestaat onder andere uit volle en magere geitenmelkpoeder,
diverse geitenproteïnepoeders (onder meer met lactose/lecithine), geitenroom, -boter en boterolie. Deze producten worden wereldwijd voor verschillende toepassingen gebruikt.

AVH dairy trade B.V.
Stationsplein 63, 1703 WE
HEERHUGOWAARD
072-5020946 info@avhdairy.com www.avhdairy.com
AVH dairy, opgericht in 2001, is gespecialiseerd in de wereldwijde handel en marktontwikkeling van (biologische) geiten-en schapenzuivel aan de verwerkende industrie. Ons productassortiment bestaat uit melkpoeders, wei derivaten, (half) harde kaas, wrongel, lactose, room, boter en vloeibare melk. Met een wereldwijd netwerk, volledige focus op geiten –en schapenzuivel en een professioneel en ervaren team is AVH in staat haar Business-to-Business klanten optimaal te bedienen.
Onze producten voldoen aan de hoogste kwaliteitseisen geschikt voor de verkoop aan de voedingsindustrie, onder andere babyvoeding, sportvoeding en algemene levensmiddelen. Sinds 1 januari 2013 is AVH dairy een onderdeel van het zuivelconcern Emmi Zwitserland (www.emmi.com). Emmi Zwitserland heeft een sterke visie op de ontwikkeling van geitenmelkproducten binnen haar concern.
Managing Director: Franck van Dalen Sales: Franck van Dalen, Patrick Heens
44 ZUIVEL IN ZICHT / 2022 HANDEL / NEDERLAND
Bloomfield Dairy BV
Coop Supermarkten
Markweg 8 Postbus 87, 6880 AB Velp 026-7999666 (fax 7999600)
Contact: H. Vergeer (unitmanager vers), S. van der Groot (categoriemanager kaas), J. Meijboom (categoriemanager zuivel)
Lionstraat 8 5831 AK BOXMEER 085-0712169 j.verburg@bloomfielddairy.nl www.bloomfield.nl
Contact: Johan Verburg
Bloomfield is de leverancier van de originele plakken voor de Cheeseburger. Naast de meest bekende Cheddar leveren wij ook een Emmental en een Pepper Jack variant voor op de hamburger.
Voor de Tex-Mex keuken en voor de “Loaded Fries” hebben wij een aantal superieure kaassauzen in ons assortiment: Cheddar naturel, Cheddar Jalapeno, Emmental/ French taco en een blue cheese kaassaus. De kaassaus wordt geleverd in spuitzak en in Tetrapack.
Boni Supermarkten
Edisonstraat 2 Postbus 1093 3860 BB Nijkerk 033-2473131 https://bonisupermarkt.nl
Danone Nederland BV

Zonnebaan 21 Postbus 40234, 3504 AA Utrecht 030-7105000 (fax 7105099) www.danone.nl
Directie: Stijn Vandervorst (country manager), Aloys Meinema (head of category management)
Danone helpt je goed bezig te zijn met gezonde en lekkere Danone zuivel. Dat doen we al sinds 1919. En blijven we doen in de toekomst. Danone Nederland is onderdeel van de Danone groep. Danone groep is met A-merken als Danone, Nutricia en Evian, één van ’s werelds meest toonaangevende ondernemingen in de voedingsmiddelenindustrie met activiteiten in meer dan 150 landen. Danone is ervan overtuigd dat voeding een belangrijke rol speelt in het welzijn en de gezondheid van iedereen.
45 ZUIVEL IN ZICHT / 2022 HANDEL / NEDERLAND
Naast voortdurend onderzoek om de voedingskwaliteit van onze producten te verbeteren, richten we ons ook op het stimuleren van een gezonde levensstijl. Zo organiseren we -samen met de Krajicek Foundation- de Danone Nations Cup, een voetbaltoernooi voor kinderen tussen 10 - 12 jaar. Op zo’n 100 playgrounds door heel Nederland spelen meer dan 5000 kinderen om de nationale titel. Het winnende mag uiteindelijk ons land vertegenwoordigen tijdens de World Cup Finale, dit jaar gespeeld in Spanje. De zuiveldivisie Danone Nederland is verantwoordelijk voor de marketing, verkoop en distributie van zuivelproducten op de Nederlandse markt. Belangrijke merken van Danone in Nederland zijn Activia, Danio, Danoontje, Actimel en Hüttenkäse.
Detailresult Groep
Olieweg 6 1951 NH Velsen Noord 0251-278700 Assortimentsmanagers: Hans Marcelis (kaas), Ruben Minnee (overige zuivel)
DiversPack B.V.
Glazenmakersweg 8, 3449 JK Woerden 0348-433118
sales@diverspack.nl www.diverspack.nl
Contact: Dick Verburg (algemeen directeur)
DiversPack is expert op gebied van het versnijden en verpakken van porties Hollandse en buitenlandse kaas. Dit doen wij voornamelijk voor retailers, de maaltijdindustrie, foodservice, exporteurs en de mooiste kaasmerken.
Van sachets met flakes of rasp tot tapasbakjes met borrelblokjes. Van vacuüm kaassticks tot kaaskerstboompjes en sinterkaasletters. Wij denken graag met u mee over welke kaas, portie en/of verpakking geschikt is voor uw vraagstuk.
ExpertCheese B.V.
Parmentierstraat 20 NL-7903 TP Hoogeveen 0528-820180
info@expertcheese.nl www.expertcheese.nl
Contactpersoon: Erno van der Weijden Commercieel verantwoordelijk
ExpertCheese “Your partner in cheese” waardeert op innovatieve kaas op. De grondstoffen worden betrokken vanuit kaasproductie- en kaasverwerkingslocaties en door ExpertCheese geschikt gemaakt voor verdere industriële verwerking. Met onze tailor made dienstverlening sluiten wij efficiënt aan op uw core business.


46 ZUIVEL IN ZICHT / 2022 HANDEL / NEDERLAND
Fabelco BV
Fonterra

Woudebergseweg 19c-2, 3707 HW Zeist 0343-449933 info@fabelco.com www.fabelco.com

Directie: M.E. de Boer Commercieel Directeur: E. van Rees Account Manager: V. Basaran
Fabelco®, gevestigd ter Zeist (Nederland) is een premium leverancier van zuivelingrediënten voor de levensmiddelenindustrie. Naast grondstoffen voor de zuivelindustrie bieden zij ook een scala aan kwalitatieve hoogstaande plantaardige ingrediënten. De focus van het bedrijf ligt op productie, distributie en handel van zuivel componenten. Variërend van de standaard commodity’s tot hoogwaardige eiwitten en klant specifieke oplossingen. Fabelco® levert zoveel mogelijk vanuit voorraad met korte afroeptermijnen, ‘justin-time’. Daarbij is de ordergrootte zeer flexibel; van een pallet en zelfs een enkele zak (25 kg) tot volle vrachtwagens (24MT).
Als onderdeel van de F&F Group profiteert Fabelco® van de uitgebreide kennis, ervaring en netwerk binnen de groep. Kwaliteitscertificeringen die we bieden zijn o.a. ISO 22000, BIO, Kosher, Halal, VLOG. Kwaliteit, Respect, Verantwoordelijkheid en Integriteit vormen de kernwaarden van waaruit Fabelco® werkt en partnerships opbouwt, door het hele levensmiddelenindustrie heen.
Eurocenter Building 3e verdieping Barbara Strozzilaan 356 1083 HN Amsterdam 020-7075300 nzmp.europe@fonterra.com www.nzmp.com www.fonterra.com
Fonterra, een Nieuw Zeelandse coöperatie van 10.000 boeren, verwerkt jaarlijks ruim 20 miljard liter melk tot zowel consumentenproducten als ingrediënten.
Deze ingredienten (B2B) worden in meer dan 100 landen verkocht onder de merknaam NZMP (New Zealand Milk Products).
In Europa worden de NZMP ingredienten vanuit Nieuw Zeeland verkocht, maar wordt tevens vloeibare wei tot WPI, WPC en lactose verwerkt in de eigen fabriek in Heerenveen (geopend in samenwerking met Aware in 2015).
De samenwerking met A-ware is recentelijk uitgebreid met de productie van UHT room voor verkoop in zowel foodservice als TPM kanalen.
Daarnaast werkt Fonterra samen met verschillende partners, onder andere Rokiskio in Litouwen en Saputo Dairy UK in het Verenigd Koninkrijk. Deze samenwerkingen zorgen voor een solide productie van hoogwaardige ingrediënten zoals WPI, WPC, gedemineraliseerd weipoeder en GOS (galacto- oligosacchariden), allen onder de NZMP merknaam.
47 ZUIVEL IN ZICHT / 2022 HANDEL / NEDERLAND
Ingredients by
NZMP biedt één van de ruimste portfolios in de zuivelindustrie, met daarin honderden oplossingen om aan de dagelijkse wensen van al onze klanten te kunnen voldoen. NZMP, ondersteund door Fonterra’s jarenlange ervaring in agri (boeren), techniek (fabrieken) en zeer hoge kwaliteitsstandaarden, levert een scala aan ingrediënten met een duidelijk voordeel voor de markt. De merknaam NZMP is hiermee een waarborg voor ingredienten van uitstekende kwaliteit en hoge functionaliteit.
Frésena-Salland BV
Geris Dairy Solutions

Platinastraat 30 6031 TW Nederweert 0495-745800 info@geris.nl www.geris.nl
Contactpersoon: Eric Coenen (commercieel verantwoordelijk)
Geris B.V. is een internationale leverancier van zuivelproducten, met de focus op kaas en boter. Deze producten worden geleverd aan industriële verwerkers voor raspen / snijden / smelten / verpakken.
Marktstraat 87, 8102 CJ Raalte 0572-346161 info@fresena.nl www.fresena.nl
Directie: Rick de Kraker (Algemeen Directeur), Frank Oranje, Eric Westerbaan, Bart Lindeboom en Natalia Niewrzalek (Commercie).
Hoofdactiviteiten van de onderneming is het verhandelen en leveren van vloeibare zuivelproducten (zoals: room, mager melk concentraat, rauwe melk, mager melk en wei concentraat) en boter, melkpoeders en weipoeders binnen Europa.
Producten o.a.: Gouda – Edam – Maasdam –Emmental – Mozzarella – Cheddar – Cagliata –lactische boter – zoete boter – weiboter –ongezouten zoeter boter – AMF.

Gestam Kaasexport B.V.
Beitelstraat 59, 1135 KV Edam 0299-371530 info@gestam.com www.gestam.com
48 ZUIVEL IN ZICHT / 2022 HANDEL / NEDERLAND
Directie: S. Schardam
Gestam kaasexport B.V. is een veelzijdig kaasexportbedrijf uit Edam, NoordHolland. Gestam is in 1916 opgericht en is gespecialiseerd in het rijpen, verpakken en exporteren van Nederlandse kaas. Wij bieden een ruim assortiment aan producten als Edam, Mimolette, Noord-Hollandse Gouda, geiten- en kruidenkazen.
Grozette BV
Ohmweg 13, Postbus 59, 3440 AB Woerden 0348-410264 (fax 423686) info@grozette.nl www.grozette.com
Directie: J.W. Nijsse (algemeen directeur), E.W.C. Bontje (commercieel directeur)
Grozette produceert een breed assortiment kaaspoeders, kaassliertjes, kaaskorrels, gespraydroogde kaas en geraspte kaas in verschillende snijvormen zowel vers als lang houdbaar voor retail, catering en industrie. In samenwerking met de klant worden producten ontwikkeld en “op maat gemaakt”, zodat ze voldoen aan de specifieke wensen en eisen van de klant. Verpakkingen variëren van 10 g tot 25 kg. Grozette is FSSC 22000 en Halal gecertificeerd.
Havero Hoogwegt BV
Amsterdamseweg 60, 6814 CP Arnhem Postbus 6, 6800 AA Arnhem 026-3228520 (fax 3214175) mail@havero.nl www.havero.nl
Directie: F.J.M. van der Puijl (directeur) Havero Hoogwegt BV is een onderdeel van de Hoogwegt Group dat zich specialiseert in de handel, ontwikkeling en productie van zuiveleiwit en overige zuivelingrediënten. In het eigen applicatielaboratorium worden op maat gemaakte zuivelproducten ontwikkeld. Havero Hoogwegt heeft DNV-GL certificering voor ISO 22000:2018 en voor GMP+ en AEO.
Producten: Industriële caseïne, rennet caseïne, zuurcaseïne, caseinaat, melkeiwitconcentraten (40 – 85%), functionele melkeiwitten (Hapro) voor toepassingen in de voedingsmiddelenindustrie, wei-eiwitconcentraten (35-80%), wei-isolaten, wei-hydrolysaten en melk- en weipermeaat.

49 ZUIVEL IN ZICHT / 2022 HANDEL / NEDERLAND
Hazeleger Kaas BV
Van der Heiden Kaas B.V.

Koningsbergenweg 10, 3771 NS Barneveld 0342-232000
info@hazeleger-kaas.nl www.hazeleger-kaas.nl
Directie: W. van Rijn
Hazeleger Kaas is gespecialiseerd in het versnijden en verpakken van diverse binnen- en buitenlandse kaassoorten. Naast co-making voor diverse partners richten we ons met eigen producten in klein- en grootverpakkingen op foodservice, groothandel, industriële verwerkers en out-of-home. Constante kwaliteit, een hoge leveringsbetrouwbaarheid en het snel kunnen inspringen op specifieke wensen zijn belangrijke pijlers binnen het beleid van Hazeleger Kaas.
Beneluxweg 10, 2411 NG Bodegraven 0172-614084
info@vanderheidenkaas.nl www.vanderheidenkaas.nl
Directie: Maarten Jan van der Heiden
Passion for Quality. Dat is onze lijfspreuk. Daar zetten wij ons elke dag voor in. Die kwaliteit komt tot uiting in alle facetten van de totstand koming van kaas: van ambachtelijke bereiding, op smaak doorrijpen en behandelen tot een kwalitatief hoogwaardige smaakbeleving. Van der Heidenkaas is een totaalleverancier in kaas. Wij zijn gespecialiseerd in de Boerenkaas uit het Groene Hart. Ons topmerk “Stolkse Boeren” is landelijk en internationaal bekend vanwege de superieure smaak. De ervaring in het kaasmaken die sinds generaties bij de familie Van der Heiden is opgebouwd, wordt nu toegepast in de begeleiding en advisering van onze kaasmakers.
Onze merken
Naast De Stolkse Boeren bestaat ons portfo lio aan merken uit: Roemer en Holland Delta (Goudse Kaas), Dilano (diverse soorten kruiden kaas), Chèvrano (geitenkaas in diverse soorten), Eminence Grise en Pradera.
50 ZUIVEL IN ZICHT / 2022 HANDEL / NEDERLAND
Van der Heiden Cheese Services
Afleveren op gewenste lokaties, Exportorders laden in containers, Distributie naar uw afnemers Kwaliteit “Denken in waarde”; Dat is de essentie van Van der Heiden Cheese Services. Altijd in gedachten hoe wij onze partners meer waarde kunnen bieden. Organisatorisch, strategisch, innovatief, flexibel, en kwaliteit voor nu of in de toekomst. Gecertificeerd voor BRC,IFS,SKAL en Proces cer tificering
Landjuweel 15, 3905 PE Veenendaal 0318-562650 (fax 562620)
www.vanderheidencheeseservices.nl info@vanderheidencheeseservices.nl
Directeur: Teunis van der Heiden
“Serving the cheese world”; Geen concurrent maar dienstverlener van onze opdrachtgevers, die wij zien als onze partners. want wij leveren wat onze partners van ons verwachten; top kwaliteit en flexibiliteit. Dit als onafhankelijk full service dienstverlener in de markt. Warehousing.“Een goed begin, is het halve werk”; Kaasopslag voor alle soorten kaas, ook eko, in elk model en elke specialiteit en kleur plastic- coat.
Packaging – Grootverpakking: “Streven naar per fectie” ; Etikettering (ook Rok) & banderolleren Paraffineren, puntloos blank ; verpakken in doos, cbl krat, kaasbox en pallets.
Packaging – Kleinverpakking; “Hoogste kwaliteit criteria, daar willen wij aan voldoen”; Versnijden en verpakken van kaas in diverse gewichtseen heden.
Logistiek
“Uw klant tevredenheid valt of staat met be trouwbare efficiënte logistiek”; Opslag gereed product , Klaarzetten van al uw pickorders ,
Hoogvliet BV
Eikenlaan 265 Postbus 434, 2400 AK Alphen aan den Rijn 0172-418218 (fax 421074) www.hoogvliet.com
Contact: Martin Geleijnse (category manager)

Hoogwegt Cheese BV
Amsterdamseweg 60, 6814 CP Arnhem Postbus 6, 6800 AA Arnhem 026-3228500 (fax 3214175) mail@hoogwegtcheese.nl www.hoogwegtcheese.com
Hoogwegt Cheese BV is een onderdeel van de Hoogwegt Group en legt zich toe op de wereldwijde handel van bulkkazen (blokken,

51 ZUIVEL IN ZICHT / 2022 HANDEL / NEDERLAND
broden, wielen, geraspt, gesneden etc.) voor industrie, retail en food service. Wij bieden onze klanten kwaliteit, logistieke service, marktinformatie en een wereldwijde afzetmarkt.
Kwaliteit
Hoogwegt Cheese is DNV-GL gecertificeerd conform de nieuwste ISO standaard: ISO 22000:2018. Tevens is Hoogwegt Cheese AEO & SKAL gecertificeerd.
Producten: Gouda, Edam, Cheddar, Mozzarella, Cagliata, Emmental, Maasdam en diverse speciaal kazen, zoals Camembert, Brie, Combi White cheese, Gorgozola en diverse biologische kazen. De meeste kaassoorten zijn eveneens verkrijgbaar onder ons eigen merk; Royal Dam®
Hoogwegt Group BV

levert Hoogwegt aan meer dan 130 landen en met ca. 450 commerciële, technische en logistieke experts haar toegevoegde waarde aan de voedingsmiddelenindustrie. Hoogwegt levert zuivelproducten van hoge kwaliteit en biedt haar partners marktkennis, slimme logistieke services en op maat gemaakte risico management oplossingen. Door haar betrouwbaarheid, betrokkenheid, verantwoordelijkheid en de persoonlijke relaties met onze klanten en partners is Hoogwegt al jaren wereldwijd de grootste zuivelingrediënten leverancier.
Hoogwegt
International BV
Amsterdamseweg 60, 6814 CP Arnhem 026-3884802
mail@hoogwegtgroup.com www.hoogwegt.com
Directie: S. Hulsebos (CEO), F. Sluis (CFO)
Hoogwegt Group BV is een internationaal zuivelconcern bestaande uit ondernemingen in Nederland en in 9 andere landen ter wereld. Hoogwegt is wereldwijd actief in de handel in zuivelproducten zoals melkpoeder, weipoeder, boter en kaas. Sinds haar oprichting in 1965,
Amsterdamseweg 60, 6814 CP Arnhem 026-3209120 (fax 3214175) www.hoogwegt.nl
Directie: P. van Leuven (algemeen directeur), G. Willemse (commercieel directeur) , R. Lankamp (commercieel directeur)
Hoogwegt International BV is een onderdeel van de Hoogwegt Group dat zich toelegt op de wereldwijde handel van gedroogde en vloeibare zuivelproducten voor de verwerkende industrie. Hoogwegt International heeft DNV-GL certificering voor ISO 22000:2018 en certificering voor GMP+ en SKAL.

52 ZUIVEL IN ZICHT / 2022 HANDEL / NEDERLAND
Producten: Melkpoeders (mager, vol en karne-), weipoeders, lactose en boter(-olie). Voor enkele gerenommeerde leveranciers vermarkt Hoogwegt een aantal industriële zuivelcommodities op exclusieve basis.
Hoogwegt Milk

Amsterdamseweg 60, 6814 CP Arnhem
Postbus 6, 6800 AA Arnhem 026-3209120 trade@hoogwegt.nl www.Hoogwegtmilk.com
Directie: S. Hulsebos
Hoogwegt Milk BV is leverancier van een breed aanbod vloeibare zuivel en geconcentreerde zuivelproducten voor de Europese markt. Als onderdeel van de Hoogwegt Group, beschikken wij over een uniek netwerk en specialisten op het gebied van commercie, techniek en Logistiek. Hierdoor kunnen wij u voorzien van de beste kwaliteitsproducten, real-time marketinformatie en slimme logistieke services.
Imeko dairy products bv
Dr. van Deenweg 44, 8025 BB Zwolle Postbus 556, 8000 AN Zwolle 038 4567270 (4567280) info@imeko.nl www.imeko.nl
Directie: H.J.L. Smellink

Onder het motto “Imeko brings dairy around the world” exporteert Imeko dairy products bv te Zwolle lang houdbare zuivelproducten in consumentenverpakking, zoals melkpoeder, geëvaporeerde melk, gesuikerde gecondenseerde melk, UHT-melk en kaas. De nadruk ligt daarbij op de eigen merken Kanny en Morny, maar klanten hebben ook de mogelijkheid om zuivelproducten onder eigen label af te nemen. De producten worden primair via directe export buiten Europa afgezet. Imeko dairy products bv onderscheidt zich hierbij door flexibiliteit, service en klantgerichtheid.
Imeko dairy products bv is een dochteronderneming van Imeko holding nv.
Daarnaast heeft Imeko een 50% belang in een productielocatie in Strückhausen. Deze fabriek is speciaal gecertificeerd voor het afvullen van (door de klant zelf aangeleverde) kindervoeding in blik.
Voor meer informatie hierover: h.duijst@imeko.nl
53 ZUIVEL IN ZICHT / 2022 HANDEL / NEDERLAND
Interfood B.V.
Lange Trekken 42, 5531 PZ Bladel
Postbus 160, 5530 AD Bladel 0497 383828
info@interfood.nl www.interfood.com
F. van Stipdonk
Interfood B.V. is een particuliere onderneming en een toonaangevende wereldwijde zuivelleverancier, met een distributie van meer dan 1.000.000 MT aan zuivelproducten per jaar. Met een uitgebreid product portfolio, variërend van melk- en weipoeders tot kaas, boter, boterolie, proteïne, vloeibare melk en concentraten, en met uiteenlopende specialistische diensten, staat Interfood middenin de waardeketen.

De grootste toegevoegde waarde die Interfood heeft voor al haar stakeholders zit in de combinatie van mondiale kennis, riskmanagement expertise, logistieke dienstverlening en technische ondersteuning. Together for better.
Mondiale kennis
Met 14 kantoren, verspreid over elk continent, is Interfood in staat om 24/7 bovenop de markt te zitten. Continue contact tussen alle kantoren en met alle belangrijke fabrikanten en leveranciers zorgt ervoor dat Interfood constant up to date is.

Riskmanagement expertise
De toegenomen volatiliteit van de zuivelmarkt creëert een significant risico en een enorme uitdaging voor bedrijven die hun zaken duurzaam willen managen. Interfood heeft verschillende tools ontwikkeld die prijsrisico’s afdekken, zowel voor Interfood als voor haar stakeholders.
Logistieke dienstverlening
Met een uitstekend netwerk van banken, pakhuizen, expediteurs en transporteurs, heeft Interfood de flexibiliteit om op maat gemaakte oplossingen te bieden in de gehele supply chain van onze klanten.
Technische ondersteuning
Met 50 jaar ervaring heeft Interfood een enorme technische expertise en kennis over zuivelingrediënten en -toepassingen. De grondige kennis van zuivelgrondstoffen en -ingrediënten in voedingsmiddelen, processen én producten, maakt Interfood uw gekwalificeerde partner om u te assisteren bij de selectie of het ontwikkelen van ingrediënten voor uw toepassingen en producten.
54 ZUIVEL IN ZICHT / 2022 HANDEL / NEDERLAND
F. van Stipdonk
CEO:
Kaashandel Remijn


Kaas-Pack Holland BV

Industriestraat 12 5331 HW Kerkdriel 0418-633101 www.kaashandelremijn.nl
Directie: Kees Remijn, Johan Copier, Peter Verweij


Wij zijn Kaashandel Remijn, al meer dan veertig jaar dé leverancier voor Nederlandse kwaliteitskaas. Mede door onze jarenlange ervaring in de rijping- en distributie zijn wij uitgegroeid tot dé leverancier van kaasspeciaalzaak en de betere markten. Doordat wij alle kazen zelf rijpen in ons eigen rijpingspakhuis kunnen we een constante (top)kwaliteit en een constante leeftijd garanderen, waardoor we een betrouwbare partner zijn. We voeren diverse merken, waarvan Stompetoren ons bekendste handelsmerk is. Onze speciale (handels)relatie met boeren- / kaasproducenten zorgt voor een unieke en vaste productaanvoer van kazen van de absolute top van de Nederlandse kaasproducenten. Niet voor niets zijn onze producten (inter)nationaal meermaals bekroond!
Buitenvaart 2109, 7905 SW Hoogeveen 0528-268246 info@kaaspack.nl www.kaaspack.nl


Directie: Albert Koekoek, Erik Koekoek
Albert en Erik Koekoek
Kaas-Pack Holland is een hecht familiebedrijf, gespecialiseerd in het veredelen en verpakken van kaasproducten. Al ruim 25 jaar levert Kaas-Pack Holland maatwerkproducten aan de voedingsmiddelenindustrie, catering en groothandel in heel Europa. Een betrokken organisatie, met deskundige medewerkers die met u meedenken. Want bij Kaas-Pack Holland begrijpen we dat onze kaas moet aansluiten bij uw assortiment en bedrijfsproces. Onze kaas, uw business!



55 ZUIVEL IN ZICHT / 2022 HANDEL / NEDERLAND
Kaptein
Het Gemaal 2, 1851 LW Heiloo 0251-664800 info@kaptein.info www.kaptein.info
Kaptein – opgericht in 1936 – is dé flexibele verpakker en producent van kaas, boter, smeltkaas en poederkaas. Kaptein is een gedreven familiebedrijf, dat haar rijke historie goed benut. Wij leveren een totaalpakket kaas, boter, smeltkaas en poederkaas aan onze nationale en internationale klanten. De combinatie van ervaring, betrouwbaarheid & dynamiek en het zeer complete assortiment kaas, boter, smeltkaas en poederkaas, maakt Kaptein dé ideale partner.
Konings-Zuivel BV

o.a. Duitsland, Frankrijk, Italië en Oostenrijk. Geeft in de breedte en in de diepte van het assortiment een invulling aan alle dikvloeibare zuivelsegmenten, zowel vers als houdbaar, in een verpakking op maat (private label, fancy label, Konings label) ondersteund door een optimale logistiek en eventueel een begeleiding op de winkelvloer.
Lidl Nederland
Havenstraat 71, 1271 AD Huizen Postbus 198, 1270 AD Huizen 020-7095039
Contact: Emiel Peters (Inkoper zuivel en kaas)
Jan Linders
De Flammert 1211 Postbus 72, 5854 ZH Nieuw Bergen 0485-349911 (fax 342284) www.janlinders.nl
Contact: Joep Weekers (senior categorymanager Vers/Semi vers, zuivel), Ben Schuurman (commercieel manager vers)
Makro Nederland
Ambachtstraat 14, 2861 EX Bergambacht 0182-352233 (fax 352916) info@koningszuivel.nl
Directie: S.H.W. Beijer, S.J.C. Stuijts
Treedt in Nederland op als verkoopkantoor voor een aantal gerenommeerde zuivelbedrijven uit
Spaklerweg 50-52, 1096 BA Amsterdam Postbus 94202, 1090 GE Amsterdam 020-3980200 www.makro.nl
Contact: Mark Michies (inkoper kaas en zuive)l
56 ZUIVEL IN ZICHT / 2022 HANDEL / NEDERLAND
MAAZ Cheese B.V.
MAAZ Cheese wil de brug slaan tussen wat de Nederlandse zuivelsector en de Europese kaasmarkt te bieden hebben en wat de (consumenten)markt vraagt.
HANDELSPARTNER
Portugalweg 17, 2411 PR Bodegraven 0172 - 55 3000 info@maazcheese.nl www.maazcheese.nl

Management:
Matthieu Zijerveld en JeanPaul Zijerveld (Algemeen directeur Sr. en Jr.), Bernhard Veldhuyzen (Algemeen Adjunct-directeur), Jan van Popering (Commercieel directeur retail), Arie van der Vliet (Financieel directeur).
ONZE OORSPRONG
Gedreven door de passie voor het vak, geboren met een intuïtieve handelsgeest. MAAZ Cheese is een oer-Hollands familiebedrijf, gerund door mensen die hun kennis over de markt, het product en haar consumenten sinds generaties lang hebben opgebouwd. Geleid door authentiek ondernemerschap zijn de mensen achter MAAZ Cheese altijd gefocust op duurzame relaties met klanten.
ONZE DRIJFVEER
Nederland is één van de meest vooruitstrevende landen in de zuivelsector ter wereld. Met goede omstandigheden voor boerenbedrijven, een zeer hoog kennis- en kwaliteitsniveau, sterke innovatiekracht en een gezonde handelsgeest weet Nederland deze positie inmiddels vele decennia vast te houden.
MAAZ Cheese is wereldwijd actief in 60 landen. De sales organisatie is onderverdeeld in Benedu en Export. Wij zijn gespecialiseerd in het bedienen van alle marktsegmenten, uiteenlopend van Speciaalzaken, Ambulante handel, Supermarkten, Groothandels tot Foodservice. MAAZ Cheese is ook in staat om Online Retailers op maat te kunnen bedienen. De Export activiteiten worden verzorgd door Veldhuyzen Kaas welke volledig geïntegreerd is binnen MAAZ Cheese.
MAAZ Cheese biedt toegevoegde waarde in elk verkoopkanaal. Door het beschikbaar stellen van advies op het gebied van exploitatie, bedrijfsvoering en de fysieke invulling van verkooppunten is MAAZ Cheese in staat om in samenspraak met u omzet- en rendementsverbetering te realiseren.
DAIRY EXPERTS
Een uniek onderdeel binnen MAAZ Cheese is de beschikbaarheid van onze Dairy Experts. Deze professionals vormen met elkaar een ongeëvenaarde bron van kennis en ervaring in de Nederlandse en internationale zuivelindustrie. Elk van hen heeft minstens veertig jaar ervaring in de zuivelsector. Hun missie is deze kennis en ervaring met u te delen. U kunt in samenspraak met ons op projectbasis een beroep doen op hun diensten. Zij helpen onze toeleveranciers en afnemers bij het ontwikkelen van nieuwe recepturen, verpakkingsmogelijkheden en innovaties.
57 ZUIVEL IN ZICHT / 2022 HANDEL / NEDERLAND
DE KETEN
MAAZ Cheese streeft altijd naar een zo kort mogelijke keten, om onnodige ketenkosten te voorkomen en snel te kunnen anticiperen op veranderingen in vraag en aanbod. Om dit te realiseren is medio 2019 een state of the art distributiecentrum gebouwd in Bodegraven. Ook snijden en raspen van kaas vindt volgens de nieuwste technologieën plaats in eigen beheer.
SOURCING
Meer dan 180 toonaangevende kaas- en zuivelproducenten uit binnen- en buitenland verzorgen dagelijks directe leveringen af-fabriek te Bodegraven. Kaasboerderijen in de regio bereiden in samenwerking en geïnspireerd door MAAZ Cheese lokale specialiteiten. Voortdurend zijn wij op zoek naar nieuwe trends en innovaties op zowel product- als conceptniveau.
LOGISTIEK & DISTRIBUTIE
De interne goederenflow wordt door middel van een intelligent informatiesysteem strak geregisseerd waardoor maximale snelheid, minimale waste en hoge leveringsbetrouwbaarheid wordt bereikt. Distributie in de BENELUX vindt plaats met ons eigen wagenpark door eigen chauffeurs en buiten de BENELUX door betrouwbare distributiepartners.
ASSORTIMENT
Binnen de categorie halfharde kaas heeft MAAZ Cheese beschikking over een exclusieve receptuur premium Gouda in 12- en 16 kilo model. Kenmerken zijn: een perfecte balans tussen smaak en consistentie, een lager zoutgehalte en een uitmuntende smaak. Onder de merken Veldhuyzen, Basiron, Dolaner, Hommage en Montana is een compleet Hollands specialiteitenassortiment van koe- en geitenmelk beschikbaar.
Regelmatig worden binnen deze categorie creatieve innovaties geïntroduceerd om de consument wereldwijd voortdurend te blijven verrassen.
Boerderijen in de regio bereiden rauwmelkse boerenkaas, boerderijkaas en authentieke streekspecialiteiten voor MAAZ Cheese. Wij bieden de mogelijkheid om op enkele boerderijen uw eigen receptuur idee te verwezenlijken.
MAAZ Cheese beschikt over een complete invulling voor het snelgroeiende segment Biologische kaas. Biologische Hollandse kaas is in een basisassortiment beschikbaar onder het merk Biovelder. Biologische buitenlandse kaas is in een ruim assortiment beschikbaar.
Speciaal voor Foodservice en Horeca brengt MAAZ Cheese een assortiment roomproducten op de markt. De smaak en textuur zijn in samenwerking met chefs en zuivelexperts ontwikkeld.
KWALITEIT EN DUURZAAMHEID
MAAZ Cheese acteert volgens hoge kwaliteitsstandaarden in de markt en stelt hoge eisen aan voedselveiligheid, hygiëne en kwaliteit. Duurzaamheid is onder andere geconcretiseerd in terugwinning en hergebruik van warmte en koude uit de installaties, led verlichting en de aanplant van ruim 100 volwassen bomen rondom het distributiecentrum. MAAZ Cheese voldoet aan de eisen die vastgelegd zijn volgens het MVO-certificaat.
58 ZUIVEL IN ZICHT / 2022 HANDEL / NEDERLAND
Melkweg Holland BV

Nettorama
Wilhelminakanaal-Zuid 120 Postbus 182, 4900 AD Oosterhout NB 0162-455950 (fax 456520) Londen@nettorama.nl www.nettorama.nl
De Klomp 5, 6745 WB De Klomp (Ede) 0318-695495 (fax 641651) trade@melkweg.com www.melkweg.com


Directie: J.F. Kaashoek
Contact: A. Meerkerk (hoofd inkoop kaas en zuivel)
Numidia
6049 LZ Herten +31475 729 100 info@numidia.nl www.numidiadairy.com
Melkweg Holland is een dynamisch internationaal handelsbedrijf, gecertificeerd voor BRC, GMP+ en Skal. Het bedrijf is actief in de import en export van zuivelproducten voor industrieel gebruik. De belangrijkste verhandelde producten zijn melkpoeders, weipoeders- en derivaten, boter en kaas. Melkweg is een dochteronderneming van de VanDrie Group, marktleider in de kalfsvleessector en grootverbruiker van zuivelproducten. Melkweg is wereldwijd actief in de verkoop van zuivelgrondstoffen in de voedingsmiddelenindustrie.
Han van Hagen
Numidia is een internationale handelsorganisatie in zuivelproducten met vestigingen in Nederland (hoofdkantoor), Singapore, Uruguay en de USA. Ons sterke netwerk over de hele wereld stelt ons in staat om met onze partners uitgebreide marktinformatie en technische kennis te delen.

59 ZUIVEL IN ZICHT / 2022 HANDEL / NEDERLAND
J.F. Kaashoek
Managing Director: Han van Hagen
Wij streven continu naar persoonlijke service en langdurige zakelijke relaties. We worden gedreven door een collectieve ondernemersgeest en een oprechte passie voor zuivel. Zuivel is wereldwijd. Afhankelijk van de marktomstandigheden verandert de waarde propositie regelmatig. Om de beste prijskwaliteitverhouding te bieden, kan het product afkomstig zijn uit Zuid-Amerika, Noord-Amerika, Europa, Oceanië of Azië. We staan in contact met de beste zuivelproducenten op alle continenten. Ook regelen wij de wereldwijde marketing van de producten voor onze leveranciers. Hierdoor kunnen zij zich volledig focussen op de productiekant. De zuivelproducten van Numidia zijn inmiddels beschikbaar in meer dan 100 landen wereldwijd. De toegevoegde waarde voor onze klanten is dat wij de logistiek, administratieve procedures, het transport en desgewenst de specifieke warehousing verzorgen. Maar bovenal dat wij onze markt- en technische kennis met ze delen. Wij volgen de zuivelmarkt 24/7 en zijn altijd beschikbaar voor advies. Numidia is gecertificeerd voor verschillende kwaliteitsmanagementsystemen voor voedselen voederveiligheid. Hiermee kan Numidia verzekeren dat de kwaliteit van de processen en producten gegarandeerd zijn. Wij zien het als onze verantwoordelijkheid om bij te dragen aan CO2-reductie en compensatie. Daarom zijn wij er trots op om de eerste wereldwijde zuivelhandelaar te zijn, die CO2-neutraal is in zijn activiteiten en continu een verbetering van de milieuprestaties nastreeft door ambitieuze doelstellingen en doelen vast te stellen in overeenstemming met milieubeheersystemen en -wetgeving. Met specifieke focus op de belangrijkste emissiebronnen zoals de productie en het transport van onze producten.
Plus Retail B.V.
Postbus 85405, 3508 AK UTRECHT 088 - 344 60 00 www.plus.nl
Contactpersonen: Marcus Husselman (Kaas) en Stephen Ophof (Zuivel).
‘De Producent’ BA
De Noordbaan 940, 2841 MG Moordrecht Postbus 5, 2800 AA Gouda 0182-513366 (fax 517479) info@deproducent.nl www.deproducent.nl
Directie: R. Paulis (algemeen directeur)
Coöperatieve Handelsvereniging “De Producent BA”, ook wel ‘De Producent BA’ genoemd is sinds 1915 een coöperatie van boerenkaas bereiders. Wij staan garant voor de afname en verantwoorde inkoop van de geproduceerde kaas van onze leden. In ons nieuwe pakhuis in Moordrecht verzorgen wij de opslag, afwerking, controle en kwaliteit van de vele soorten boeren kaas en kaas van de boerderij. In samenwerking met onze klanten stellen wij een assortiment samen en bespreken we de diverse mogelijkhe den. De Producent is in 100 jaar uitgegroeid tot een modern en flexibel bedrijf en behoort tot de grote leveranciers in binnen- en buitenland van Boerenkaas en Kaas van de Boerderij.

60 ZUIVEL IN ZICHT / 2022 HANDEL / NEDERLAND
Sligro Food Group Nederland BV
Corridor 11 Postbus 47, 5460 AA Veghel 0413-343500 (fax 341520) www.sligrofoodgroup.nl
Inkoper: P. Meeuwesen (zuivel), T. van Schijndel (inkoper kaas vers)
Spar Holding
Zijlweg 18, havennummer 1904 Postbus 50, 5140 AB Waalwijk 088- 4457777
Assortimentsmanager: W. van Beem (kaas en zuivel)
Treur Kaas
Rietveld 93, 3443 XB Woerden, Nederland 0348-688 941 info@treurkaas.nl www.treurkaas.nl
Directie: René Treur, Daan Treur
Verkoop: Bert Westmaas, Mark Eversteijn, Stefaan Pinsart, Willem-Jan Oudehinken, Eduard Treur, Rik Koekoek, Christel Schreuders
Treur Kaas is een familiebedrijf en sinds 1955 gespecialiseerd in het rijpen en verzorgen van Hollandse Kaasspecialiteiten. Vanuit ons kaaspakhuis, gelegen in het Groene Hart, leveren wij kwaliteitskaas aan o.a. kaasspeciaalzaken, markthandel en groothandelaren in binnen en buitenland.
Treur Kaas beschikt over een zorgvuldig kwaliteitssysteem om de voedselveiligheid te garanderen. Wij zijn in het bezit van FSCC 22000, ISO 22000 en Skal certificaten en leveren met eigen vrachtwagens de kaas om de kwaliteitsketen te waarborgen, van deur tot deur.
Wij werken samen met kleinschalige kaasmakerijen en boeren om de lekkerste specialiteiten te selecteren. Vanuit een Christelijke grondslag willen wij bijdragen aan een wereld zoals deze bedoeld is met respect voor mens, dier en natuur.
Missie Compagnons in bijzondere kaas.
Visie
Met passie en expertise meesterlijke kaas ontwikkelen en rijpen voor kaasspecialisten. Als eerlijke en betrouwbare compagnon bouwt Treur Kaas aan duurzame relaties met leveranciers en afnemers. Onze afnemers kunnen rekenen op een persoonlijke begeleiding en maatwerk verkoopondersteuning. Samen verantwoordelijk voor succes; ieder zijn kracht!
Kaasmerken
Treur Kaas beschikt over unieke Hollandse kaasspecialiteiten onder de merknamen: Erfgoed Stelling kaas, Weydeland kaas, Oudelandse Boeren- en Boerderijkaas, Chevretta Geitenkaas en de Villa’s; ambachtelijke kruidenkazen. In het biologische segment zijn verkrijgbaar: Mèkkerstee;
61 ZUIVEL IN ZICHT / 2022 HANDEL / NEDERLAND
biologische geitenkaas, Jerseyhoeve; biologische Jerseykaas en BioStee; biologische kaas. Deze exclusieve kaasmerken zijn bijzonder puur van smaak, natuurlijk gerijpt en hebben een extra intense smaak door een dun korstje.
Onze kracht? Het leveren van eerlijke kwaliteitskaas met de puurste smaak en een complete kaasbeleving!
Uniekaas Holland B.V.

Alle kazen worden geproduceerd conform eigen, vaste recepturen. Zo wordt de kaas voor het Uniekaas merk niet alleen met Hollandse weidemelk van de eigen DOC boeren gemaakt, maar ook al jarenlang zónder conserveringsmiddelen.
Op de productielocatie in Kaatsheuvel vindt vervolgens het rijpen plaats, onder toeziend oog van onze rijpingsspecialist, en worden tientallen verschillende kaassoorten efficiënt versneden, verpakt en zorgvuldig getransporteerd naar klanten in binnen- en buitenland. Diverse teams werken hier dagelijks aan de strategie en productontwikkeling om te kunnen blijven voldoen aan de verwachtingen van klant en consument voor zowel PL als het Uniekaas merk; het oudste kaasmerk van Nederland.
Unilac Holland
Belgiestraat 6, 5171 PN Kaatsheuvel 0416-288500 info@uniekaas.nl www.uniekaasholland.nl
Directie: R. Krekels (algemeen directeur)
Uniekaas Holland staat al meer dan 50 jaar garant voor pure, smaakvolle echte Hollandse Goudse. Onder de corporate vlag Uniekaas Holland wordt zowel het Uniekaas merk als Private Label geproduceerd voor de Nederlandse markt en voor export. Uniekaas Holland is onderdeel van het moederbedrijf DMK. De kaas wordt geproduceerd met melk afkomstig van melkveehouders van de coöperatie DOC Kaas in Hoogeveen. Hiermee heeft de organisatie de volledige controle over de hele keten van melkproductie tot kaasverkoop.
Unilac Holland is een onafhankelijk Nederlands zuivelbedrijf, gespecialiseerd in de im- en export van Europese kaas, boter en melkproducten. De zuivelproducten, zowel eigen merken, merken van producenten als private labels, zijn afkomstig uit alle Europese ‘zuivellanden’ en worden geëxporteerd naar alle continenten ter wereld.

62
Zonnecel
3815 KN Amersfoort
info@unilac-holland.com www.unilac-holland.com
De
3,
033-4760230
Directie: Onno Schneiders
ZUIVEL IN ZICHT / 2022 HANDEL / NEDERLAND
Vandersterre
Duitslandweg 9-11 2411 NT Bodegraven 0172-606111 (fax 618137)



Vestigingen:
Vandersterre Holland B.V. Duitslandweg 9-11 2411 NT Bodegraven 0172-606111 (614133) info@vandersterre.nl www.vandersterre.nl
Vandersterre Groep Packaging B.V. Industrieweg 11 1613 KT Grootebroek 0183-353088 (515624) packaging@vandersterregroep.nl www.vandersterregroep.nl
Jan
Als innovatieve totaalleverancier van Hollandse en buitenlandse kaassoorten biedt Vandersterre Groep een prachtig assortiment kazen. Wij zijn gespecialiseerd in het produceren, veredelen,

verpakken en vermarkten van kwalitatief hoogwaardige kaas. Zowel nationaal als internationaal opereert Vandersterre Groep met een totaaloplossing voor elk assortiment, actief in landen zowel binnen als buiten de Europese Unie. Onze kazen leveren we aan kaasspeciaalzaken, supermarkten, horeca en markthandel. Door heel Nederland leveren wij met gecertificeerd eigen vervoer. Passie is ons voornaamste ingrediënt. Want kaas verkopen doe je niet alleen met je verstand, maar ook met je hart. In de rijke geschiedenis die Vandersterre Groep kent, hebben wij leren inspelen op de diversiteit van onze klanten en van consumenten. Kwaliteit, flexibiliteit, creativiteit en actieve (verkoop)ondersteuning staan daarom bij Vandersterre Groep hoog in het vaandel. Samen met onze klanten willen we een uitstekende prestatie leveren. Sinds 2011 werkt Vandersterre Groep samen met Herbert, Yvonne en hun kinderen van Landgoed Kaamps. Met veel zorg en liefde maken ze dagelijks van de melk van eigen koeien zeer bijzondere kazen. Boer’n Trots kaas is zonder meer uniek, een karakteristieke, iets zoete kaas met een natuurlijke korst van karamel of honing. Landgoed Kaamps, gelegen in Deurningen, heeft het traject van gras naar kaas volledig in eigen beheer en streeft naar een zo duurzaam mogelijk landgoed.
Afzetkanalen
In het segment ambulante handel heeft Vandersterre Groep een leidende rol. Binnen onze marktformules Holland Kaascentrum, Daalder Kaas, KaasKoning en Liefde & Ambacht wordt samengewerkt met zelfstandig ondernemers. Door bundeling van kennis en ervaring op het gebied van inkoop, verkoop & marketing en een gezonde dosis persoonlijk ondernemerschap, genieten de leden van de
63
Directie: Frank de Graaff, Bert Klein, Jan Kos
Frank de Graaff Bert Klein
Kos
HANDEL / NEDERLAND ZUIVEL IN ZICHT / 2022
marktformules grote waardering van consumenten op de vele Nederlandse, Duitse, Belgische en Oostenrijkse weekmarkten.
Specialiteiten
Voor het traditionele kanaal heeft Vandersterre Groep prachtige merken ontwikkeld. Beemster van ’t mes is hier één van. Dit is niet zomaar een Beemster kaas, maar eentje die alleen bij de echte kaasspeciaalzaak te koop is. Beemster van ’t mes is extra groot en dat betekend extra lekker. De naam zegt het al: deze kaas is altijd versgesneden van ’t mes, hierdoor blijft de pure, smedige smaak bewaard. Prachtige boeren- en boerderijkazen vanuit alle windstreken van Nederland verkopen we onder Boerenpracht en Van het Erf. Ook bieden wij een uitgebreid assortiment biologische kaas onder Bioweide en ambachtelijk & streekgebonden specialiteiten afkomstig van Landgoed Kaamps onder Boer’n Trots. Door jarenlange ervaring wordt er een evenwichtig en compleet assortiment Hollandse en buitenlandse kaas aangeboden, uiteraard afgestemd op de wensen van de consument van vandaag. Wat de klant zoekt hebben wij, meestal direct uit voorraad leverbaar, in huis.
Full-service partner
In de dynamische wereld van het Retail & Foodservice kanaal weet Vandersterre Groep inmiddels haar weg goed te vinden. Onze rol varieert van conceptontwikkelaar en verpakkingsspecialist tot full-service partner. Doordat wij beschikken over eigen pakhuizen, een moderne verpakkingslocatie, eigen logistiek en een betrokken marketing & sales team, kan er snel ingespeeld worden op de wensen van onze klant. Of het nu gaat om onze eigen merken, boerenkaas of private label, door onze kennis en ervaring zijn wij in staat om maatoplossingen te bieden.
Internationale merken Vandersterre heeft een zeer uitgebreid kaasassortiment; van merkkazen waaronder internationale merken als Prima Donna en Landana kaas, maar ook Goudse jong tot en met oud in verschillende gewichten en modellen, kazen met minder vet, regionale kazen, geitenkazen, schapenkazen en niet te vergeten échte boerenkaas.
Prima Donna (www.primadonnakaas.nl) onderscheidt zich van traditionele Goudse kaassoorten door smaak, kwaliteit en unieke uitstraling. De licht zoete smaak is kenmerkend voor Prima Donna fino (gerijpt), Prima Donna maturo (extra gerijpt), Prima Donna forte (oud) en Prima Donna leggero 30+ (light).
Landana Kaas (www.landanakaas.nl) staat voor een kwalitatief hoogwaardig assortiment Hollandse kazen van koe- en geitenmelk. De kazen zijn met zorg bereid en op natuurlijk wijze gerijpt. De verschillende leeftijden en varianten, waaronder light- en kruidenkazen, zorgen voor een breed en herkenbaar Landana assortiment.
64
HANDEL / NEDERLAND ZUIVEL IN ZICHT / 2022
Vepo Cheese
Vergeer & Zn. B.V., Th.
Beneluxweg 1
Postbus 10, 2410 AA Bodegraven 0172-635200 (fax 635215) info@vepocheese.com www.vepocheese.com
Directie: M.J.C. Verkleij

M.J.C. Verkleij
Vepo Cheese is gespecialiseerd in het verwerken en verpakken van kaas, wij rijpen, versnijden en raspen diverse Europese kaassoorten. Wij bieden u een assortiment van zowel klein- als groot-verpakkingen kaas voor supermarkten, out-of-home kanalen, industriële verwerkers en foodservice.Met onze BRC, IFS, COKZ en Geraspte Kaas Keurmerk certificeringen voldoen wij aan de hoogste voedselveiligheidseisen. Wij zijn ook in het bezit van een SKAL- en Halalcertificaat voor het verpakken van biologische en Halal kaas.
Reewal 18, 2811 PT Reeuwijk 0182-398600 info@vergeerholland.com www.vergeerholland.com
Management: Diederik Vergeer (Algemeen Directeur), Hanneke Vergeer (Financieel Directeur), Marcel van Gils (Operationeel Directeur), Wim Hofman (Salesmanager Nederland)
OORSPRONG
Al sinds 1934 maakt Vergeer Holland gewone kaas weer bijzonder. Het familiebedrijf met meer dan 540 medewerkers is uitgegroeid tot één van de grootste, innovatieve kaasverwerkers ter wereld. Vergeer Holland is gespecialiseerd in het rijpen, versnijden, raspen en verpakken van kaas.
ASSORTIMENT
Wij bieden een breed scala aan verpakkingen van klein- en grootverpakking onder merk en private label. Dit doen we voor zowel natuurkaas als foliekaas en voor verschillende soorten zoals de populaire Gouda, Edam en Maasdam. Daarnaast verwerken we ook speciaalkazen zoals komijn, sambal, tuinkruiden, geitenkaas, boerenkaas, biokaas, natriumarme kaas, kazen van 20+ tot 40+ en bieden we een ruim assortiment in duurzame producten van onder andere; Weidegang, PlanetProof, VLOG Ohne Gentechnik en Clean. Wij denken graag mee met onze
65
HANDEL / NEDERLAND ZUIVEL IN ZICHT / 2022
afnemers en hun assortiment en zorgen er altijd voor dat we aan iedere wens kunnen voldoen. We garanderen flexibiliteit en snelheid aan al onze afnemers.
AFZETKANALEN
Een groot deel van onze producten is bestemd voor de export en inmiddels behoren we tot de grootste kaasverpakkingsbedrijven en exporteurs van Europa. Vergeer is actief in meer dan 30 landen. We exporteren binnen Europa, maar ook ver daarbuiten. Onze afnemers bevinden zich binnen verschillende marktsegmenten in de kaasbranche; retail, foodservice, out of home en industrie.
KWALITEIT EN DUURZAAMHEID
Vergeer Holland stelt hoge eisen aan voedselveiligheid, hygiëne en kwaliteit. Het hele traject van inkopen, rijpen, snijden, raspen, verpakken en distribueren gebeurt onder strenge regels. Wij zijn gecertificeerd voor: IFS 6.1 Higher Level Unannounced, SKAL, Weidegang, BGA Geitenkaas, VLOG Ohne Gentechnik, Grated Cheese, PlanetProof, Kwaliteitszorg Boerenkaas en BREEAM outstanding.
DE KETEN
Rijpen, snijden, verpakken en opslag zijn de bedrijfsactiviteiten van Vergeer Holland, verdeeld over 5 vestigingen. Het distributiecentrum is gelegen in Bodegraven. Van daar uit worden de producten naar de afnemers getransporteerd. Naast het distributiecentrum bevindt zich onze nieuwe duurzaam gebouwde locatie voor Productie-, Rijping en Opslag. Deze nieuwe locatie voldoet aan de hoogste eisen van het BREEAM-certificaat outstanding, het keurmerk voor duurzame bouw met minimale milieu impact. Het gehele productieproces geschiedt volautomatisch voorzien van de meest moderne
technieken. Ultramoderne productielijnen met een ongekende snij- en verpakkingstechniek wat heeft geleid tot maar liefst 30% reductie van verpakkingsgewicht. Zeer uniek is de automatische aanvoer van grondstoffen en de afvoer van gereed product. De inrichting van het gebouw loopt uiteen van een zeer geavanceerd intern transportsysteem tot volautomatische rijping, waar nauwelijks nog mensenhanden aan te pas komen. In Bodegraven vindt de bulkproductie plaats, op locatie Reeuwijk de gespecialiseerde verpakkingen en op locatie Woerden worden alle raspproducten verwerkt.
MISSIE
Wij zijn een toonaangevend en klantgericht familiebedrijf dat door haar flexibele, dynamische karakter en gericht op continue verbetering, alle marktsegmenten op een maatschappelijk verantwoorde wijze van kwalitatief hoogwaardige producten voorziet.
VESTIGINGEN:
Vergeer Holland Reeuwijk (Rijping, Productie en Hoofdkantoor) Reewal 18, 2811 PT Reeuwijk
Vergeer Holland Next Generation (Rijping, Productie en Opslag) Denemarkenweg 10, 2411 RK Bodegraven
Vergeer Holland Bodegraven (Distributiecentrum) Portugalweg 20, 2411 PR Bodegraven
Vergeer Holland Bodegraven (Rijping) Henri Dunantweg 5, 2411 NJ Bodegraven
Vergeer Holland Woerden (Productie) Golf van Biskaje 1, 3446 CS Woerden
66
HANDEL / NEDERLAND ZUIVEL IN ZICHT / 2022
Visser Kaas
Nijverheidsweg 20, 1271 EA Huizen j.n.vanmill@visser-kaas.nl info@visser-kaas.nl www.visser-kaas.nl
Directie: J.A. (Jasper) van Mill en R.J. (Robert-Jan) Visser, telefoon 035 656 80 00


Cheese Käse Fromage since 1916
Een authentiek familiebedrijf met meer dan 100 jaar ervaring als kaasrijper, – verpakker én –verkoper van Hollandse kwaliteitskaas. Een echt familiebedrijf met passie voor het vak en de kaas. Opgericht in 1916 door Hendrik Visser, de eerste generatie. Vijf generaties verder geniet men van onze top kwaliteitskazen in meer dan 60 landen, wereldwijd.
Onze rijke geschiedenis – bij koninklijke beschikking hofleverancier
In 1916 is Visser Kaas officieel ingeschreven bij de Kamer van Koophandel. Inmiddels kunnen we bouwen op meer dan 100 jaar ervaring en zijn we uitgegroeid tot een betrouwbare, wereldwijde speler op de kaasmarkt. Wij geloven erin dat onze rijke historie nog steeds voortleeft in onze kazen en zich uit in lange termijn relaties en bedrijfsvoering. Onze reputatie is in 2016 bevestigd, toen wij het Hofleverancier predicaat mochten ontvangen. En daar zijn we trots op.
Ons huidige kaasbedrijf – betrouwbaar, veelzijdig en flexibel In ons kaaspakhuis in het Noord-Hollandse
Huizen, waar het bedrijf al sinds de oprichting gevestigd is, worden onze kazen nog echt op traditionele manier en met liefde gerijpt; zoals het vroeger ook al gedaan werd. De kazen rijpen onder de juiste temperatuur op échte houten planken, totdat de excellente smaak en leeftijd bereikt is. Kwaliteit is hiermee gegarandeerd en onze kazen zijn dan ook wereldwijd geliefd.
Naast onze natuurgerijpte kazen bieden we vele specialiteiten en foliegerijpte kazen aan. Kleinere retail porties versnijden en verpakken wij zelf in een moderne (dieptrek)verpakkingslijn en zijn in staat om alle verpakte kaas van hoogwaardige kwaliteit aan te bieden. Met dit veelzijdige assortiment kwaliteitskaas bieden wij waarde voor de segmenten Retail, Foodservice & Horeca en Industrie. Met onze flexibele mentaliteit en efficiënte bedrijfsvoering vervullen wij orders volledig tailor made en managen ook de levering middels ons transportnetwerk en export expertise.
Onze merken – wereldwijd geliefd HUIZER KAAS-GILDE
Huizer Kaas- Gilde is ons eigen topmerk voor traditioneel gerijpte kaas met gegarandeerde kwaliteit uit Holland en is inmiddels wereldwijd bekend. Huizer Kaas-Gilde is beschikbaar in een ruim assortiment van koe -en geitenmelk. Speciaal voor de Nederlandse markt is er in samenwerking met verschillende markthandelaren en detaillisten een verkoop-organisatie onder de naam Het Huizer Kaas-Gilde.
FRAU ANTJE PIKANTJE & MAI GOUDA
Wij zijn blij om distributeur te zijn van de welbekende merken Frau Antje Pikantje en Mai Gouda. Met een typisch Hollands etiket en icoon Frau Antje is deze kaas een must in het buitenland, vooral in Duitsland.
67
ZUIVEL IN ZICHT / 2022 HANDEL / NEDERLAND
PRIVATE LABEL
Wij vinden het belangrijk om samen met onze klanten te kijken wat het beste past in de markt. Qua type kaas, maar ook qua merkuiting. Wij bieden onze klanten daarom de mogelijkheid om Private Label te voeren. Zo werken we gezamenlijk aan een exclusief merk en bouwen we langdurige relaties op met klanten en consumenten.

Onze kwaliteit – gewaarborgd en constant

Door onze gecertificeerde productie- en verpakkingstechnologieën zijn klanten verzekerd van een hoge en constante kwaliteit van al onze producten. Wij gebruiken de kwaliteitssystemen en -handboeken: AEO, FSSC, IFS, Procescertificaten voor opslag, rijpen, verwerken, verpakken en transport. Daarnaast zijn wij in het bezit van een SKAL certificaat voor biologische kazen, als ook het Weidegang certificaat.
Vreugdenhil Dairy Foods is een Nederlandse producent van melkpoeders die naar 130 landen wereldwijd worden geexporteerd. De hoogwaardige en voedingsrijke melkpoeders worden gebruikt als ingredient voor kindervoeding, voor heerlijke melk in een glas of als ingredient voor de levensmiddelenindustrie. Door aanwezigheid in de volledige productieketen, van boerderijmelk tot halffabrikaat, is Vreugdenhil in staat om zichzelf de hoogste kwaliteitseisen op te leggen. Vreugdenhil is FSSC 22.000 gecertificeerd. Ook aan speciale eisen als kosher, halal of biologische melkpoeder kan Vreugdenhil voldoen.

68
Vreugdenhil Dairy Foods Arkerpoort 5, 3861 PS Nijkerk Postbus 64, 3860 AB Nijkerk 033 303 5000 info@vreugdenhil.nl www.vreugdenhil.nl Bestuur: J. Vreugdenhil (Chairman) Directie: A.P. de Groot (CEO)
Van links naar rechts J. Vreugdenhil en A.P. de Groot
Zuiderzee 5 Postbus 13, 1270 AA Huizen 035-5287528 www.westlandkaas.nl
Team: Ronald
(CEO
Frank Fischer (CFO), Floor
(COO), Huub Postma (CCO) ZUIVEL IN ZICHT / 2022 HANDEL / NEDERLAND
‘We bring you the best of milk’ is niet voor niets de missie van het bedrijf. Westland Kaas B.V.
Management
van Zetten
a.i.)
Hesselmans
De Hollandse handelsgeest heeft de kaasmerken van Westland ver gebracht. Al 85 jaar is Westland een vertrouwde naam op de wereldwijde kaasmarkt. Altijd op zoek naar de vernieuwing die mensen beweegt. Old Amsterdam, Maaslander en Trenta zijn de belangrijkste merken van Westland. Sterk door zinvolle innovatie in zowel ingrediënten en smaak, als verpakking en presentatie.
Zijerveld
Broekveldselaan 9, 2411 NL Postbus 52, 2410 AB, Bodegraven 0172-630100



info@zijerveldfood.nl www.zijerveldfood.nl www.kaas.nl
Management: Tuncay Özgüner (CEO), Carlijn Janssen (CF0)
Zijerveld is van oudsher een handelshuis, opgericht door de gelijknamige familie en nu zelfstandig opererend als dochteronderneming van FrieslandCampina. Door de jaren heen heeft Zijerveld bewezen dé aanbieder te zijn van een totaalassortiment aan Hollandse en buitenlandse kazen en aanverwante producten.
MISSIE & VISIE

Zijerveld is al meer dan 100 jaar vernieuwer in de kaasmarkt. Klantfocus en sterke relaties maken
onder meer het verschil. Zijerveld onderscheidt zich in de Europese markt met het brede assortiment van topkwaliteit kaas en visie op de categorie. Passie, ervaring en kaaskennis delen met klanten staan hoog in het vaandel. Klanten uit meerdere marktsegmenten als supermarkten, e-commerce, kaasspeciaalzaken, ambulante handel, groothandels en foodservice kunnen bij Zijerveld terecht.
CHEESE UNLIMITED

Zijerveld biedt onbegrensde mogelijkheden met kaas en noemt dat Cheese Unlimited: een totaaloplossing in kaas en aanverwante artikelen en diensten. Zijerveld is in de gehele keten betrokken. Van product en logistieke dienstverlening tot ondersteuning en advies op gebied van assortiment, promotie en exploitatie. Daarin zit de toegevoegde waarde voor de klant.
VIJF PIJLERS
Zijerveld biedt innovatieve concepten, hoge kwaliteitsborging en unieke producten, flexibel samengesteld en verpakt en geleverd door een eigen logistieke dienstverlening met een uiterst hoge leverbetrouwbaarheid. Bij Zijerveld ziet u de liefde voor kaas terug in het uitgebreide assortiment dat met aandacht en vanuit passie is samengesteld. Het assortiment bevat vijf pijlers; Noord–Hollandse kaas, boerenkaas, regionale kaas, Hollandse geitenkaas en buitenlandse kaas.
NOORD-HOLLANDSE GOUDA
Gouden Zegel – Rode Zegel
In de bijzondere kaasmakerij van Lutjewinkel in
69 ZUIVEL IN ZICHT / 2022 HANDEL / NEDERLAND
de Kop van Noord-Holland wordt al sinds 1916 kaas bereid. Daar komen al meer dan honderd jaar unieke omstandigheden bijeen om tot op de dag van vandaag de beste en lekkerste kwaliteitskaas te bereiden. Zoals de unieke ligging van Noord-Holland aan twee zeeën en twee meren, met de weidse grasrijke polders waar de zeewind vrij spel heeft. Gecombineerd met de door generaties lang gevestigde en betrokken veehouders, die hun koeien laten grazen in de ingepolderde weides, zorgt dit voor de allerbeste Noord-Hollandse weidemelk.
Van deze weidemelk worden de eersteklas Noord-Hollandse kazen bereid met wereldfaam. Zijerveld levert Noord-Hollandse Gouda uit Lutjewinkel o.a. via de merken: Lutjewinkel1916, Oorspronck en Meesterlijck én als Premium Private label bij diverse klanten.
(KB) en de Europese GTS erkenning. Zijerveld levert Boerenkaas o.a. via de merken Boerenkaas Juweel en Boerenmeesterwerk.

BUITENLANDSE KAAS
Onze inkopers reizen de hele wereld af en vinden de lekkerste kazen voor onze klanten. Daardoor heeft Zijerveld door de jaren heen een breed bestand aan betrouwbare en kwalitatief hoogwaardige leveranciers opgebouwd. Zo heeft Zijerveld voor elke klant een passend product, of het nu om het topsegment gaat, of over andere prijsklasses. Zo beschikt Zijerveld bijvoorbeeld over meer dan 90 rauwmelkse specialiteiten en kazen uit alle windstreken en van diverse melksoorten.
•
BOERENKAAS
BK - GTS
Boerenkaas is kaas in zijn meest pure vorm: kaas zoals die al eeuwenlang in Nederland op de boerderij wordt gemaakt. Boerenkaas is daarmee de meest authentieke kaas van Nederland en is letterlijk en figuurlijk puur Hollands erfgoed: kaas waarop we trots kunnen zijn. Klanten kunnen bij Zijerveld rekenen op de allerbeste kwaliteit boerenkaas. Die zekerheid ligt allereerst besloten in de vaste en diepe samenwerking die Zijerveld heeft met gepassioneerde boerenkaasfamilies en grondige kennis van de boerenkaasketen. Samen met de wijze van rijping in het eigen traditionele boerenkaaspakhuis in Bodegraven garandeert dit een uitmuntende kwaliteit, die bezegeld wordt door het keurmerk Kwaliteitszorg Boerderijzuivel
Het assortiment is bovendien continu in beweging. Twee keer per jaar presenteert Zijerveld nieuwe heerlijkheden. Hierdoor is Zijerveld altijd vernieuwend in de markt. Dit gaat overigens niet ten koste van alle tijdloze klassiekers. Zij gaan tenslotte niet voor niets al eeuwen mee! Le Favori® is hét kwaliteitsmerk buitenlandse kaas van Zijerveld, kazen speciaal geselecteerd met de beste smaak en uitstekende kwaliteit.
HOLLANDSE GEITENKAAS
De basis van Hollandse, halfharde geitenkaas is de beste geitenmelk die er te vinden is. Deze eersteklas melk komt van boerderijen uit het zuiden van het land. Hier hebben de witte geiten, van het ras Saanen, volop leefruimte en krijgen ze het hele jaar door uitgebalanceerde voeding. Het geeft de melk een ongekend romig karakter. Een perfecte basis voor kaas. Zijerveld levert geitenkaas o.a. via de merken Saantje, Amaltura en Arina.
REGIONALE KAAS
Met ‘Kaas van Hier’ levert Zijerveld
70 ZUIVEL IN ZICHT / 2022
HANDEL / NEDERLAND
• NARAGEG D EERDETRADITIONELES P
E TIETILAIC
kwaliteitskazen uit heel Nederland. Kleinschaligheid en de regionale oorsprong voeren daarbij de boventoon. De regionale kazen zijn stuk voor stuk bijzondere kazen met een bijzonder verhaal. Geselecteerd op hun herkomst en identiteit, dat zich vertaalt naar een bijzondere smaak. Stuk voor stuk het ontdekken waard. Unieke merken in deze pijler zijn o.a.: Skylger, Twentse Bunkerkaas en Kernhem. Naast deze pijlers heeft Zijerveld binnen haar assortiment ook nog een aantal exclusieve merken zoals o.a. De Rotterdamsche Oude, Danish Chef en PanPan.
NV Danone SA
Met een sterke verankering op de Belgische retailmarkt verzekert Vache Bleue sinds 1927 de distributie en verpakking van zuivelproducten en andere verse producten. Het Vache Bleuemerk staat garant voor smaak en kwaliteit, en is al jarenlang marktleider in gemengde geraspte kazen. Ons vakmanschap wordt tevens aangewend om de distributiemerken toegevoegde waarde te geven, zowel in België als buiten de landsgrenzen. Ons uitgebreid assortiment lactosevrije producten onder het merk Dilea staat garant voor 100% smaak en 0% lactose. Ons eigen verpakkingsatelier laat toe zowel voorverpakte als vers verpakte kazen te transformeren, onder eigen merk, private label of co-packing. Tevens bieden wij gekoelde logistieke diensten aan, van opslag, order picking en facturatie tot transport via ons geïntegreerd logistiek bedrijf Frigoway. Sinds 2019 maken we zelf onze emmental op basis van hoog kwalitatieve melk in de Allgäu (regio Beieren) in de kaasmakerij van Bad-Wörishofen.


S.A Vache Bleue N.V.
71 ZUIVEL IN ZICHT / 2022
Jules Cockxstraat 6, B-1160 Auderghem 0032-2-7766811 (fax 7628452) www.danone.be
Grand’Route 552, B-1428 Lillois-Witterzee 0032-67-894940 info@vachebleue.com www.vachebleue.com Management: D. Parent (Managing Director), F. Vroome (Managing Partner), F. Hopchet (Sales Director Europe), B. Tuts (Sales Director Branded Belux)
Marketing, verkoop en administratie: The Crescent Route de Lennik 451, 1070 Bruxelles Lenniksebaan 451, 1070 Brussel 0032-2-5242092 info@yakult.be www.yakult.be Bestuur: Bart Degeest (managing director)
van het product Yakult in België en Luxemburg. HANDEL / BELGIË
Yakult Belgium NV/S.A
Distributie-activiteiten
ABAB Accountants en Adviseurs

Ellen Pankhurststraat 1k 5032 MD Tilburg 013-4647100 info@abab.nl www.abab.nl
ABAB Accountants en Adviseurs is een fullservice accountants- en adviesorganisatie met meer dan negentig jaar ervaring en zevenhonderd betrokken medewerkers, verspreid over veertien vestigingen. ABAB investeert al jaren in specialistische kennis op het gebied van de melkveehouderij. Onze agrarische bedrijfsadviseurs kennen uw branche, volgen de ontwikkelingen op de voet en zijn op de hoogte van mogelijke kansen voor uw onderneming. Gecombineerd met onze fiscale, administratieve en juridische kennis ondersteunen wij melkveehouders bij bedrijfseconomische en branchegerichte vraagstukken.

Agribusiness Service BV
Braillelaan 9 2289 CL Rijswijk 085 – 77 319 73
info@agribusiness-service.nl www.agribusiness-service.nl
Agribusiness Service BV (ABS) is de toonaangevende dienstverlener en adviseur voor organisaties en bedrijven die actief zijn in de dynamische agrarische sector. ABS biedt verschillende expertises aan van secretariële werkzaamheden tot beleidsadvies. ABS levert kennis, support, coördinatie en uitvoering van verschillende projecten met een flexibel team, bestaande uit professionals in verschillende vakgebieden. Met onze servicegerichte dienstverlening werken wij aan een transparante en toekomstbestendige agrarische sector. Het samenbrengen van netwerken en toepassen van opgedane ervaringen zorgt ervoor dat onze klanten hun bedrijfsvoering optimaal kunnen uitvoeren.
72 ZUIVEL IN ZICHT / 2022 KENNIS- EN ADVIESINSTELLINGEN
Alfa accountants en adviseurs


goed inzicht in je resultaten ten opzichte van de best vergelijkbare melkveebedrijven. De bedrijfskundigen staan dus dicht bij jou als ondernemer en bekijken samen met jou de toekomstmogelijkheden van het bedrijf.
Alfa Wageningen
Agro Business Park 85 6708 PV Wageningen 088 253 1015 hdebie@alfa.nl
Contactpersoon: Hans de Bie, Marktmanager Food & Agri


Als melkveehouder heb je te maken met veel vraagstukken op het gebied van je bedrijfsvoering, wet & regelgeving en strategie. De bedrijfskundigen van Alfa, verspreid over ruim 30 kantoren in Nederland volgen de ontwikkelingen in de melkveehouderij en de zuivelketen op de voet. Hierdoor zijn ze goed op de hoogte van de actualiteiten en kunnen je daardoor goed ondersteunen bij de diverse vraagstukken. Met een goede financiële en technische rapportage van je bedrijf geven ze inzicht in de mogelijke verbeterpunten in je bedrijfsvoering. De rapportage geeft ook
Agro & Agri
Dokter Stolteweg 2 8025 AV Zwolle 038-45 526 00
Contact persoon: Rick Hoksbergen, specialist melkveehouderij
Rick Hoksbergen
In de agrarische sector heeft de ondernemer met stevige uitdagingen te maken. Veranderende wet- en regelgeving. Steeds strengere eisen. Een sterk veranderende markt. Om winstgevend te blijven is het zaak om daar flexibel op in te spelen. De Countus agro-specialisten helpen daarbij.
73 ZUIVEL IN ZICHT / 2022 KENNIS- EN ADVIESINSTELLINGEN
Hans de Bie
Dairy Campus
Boksumerdyk 11, 8912 CA Leeuwarden info@dairycampus.nl www.dairycampus.nl
De resultaten zorgen voor meer kennis op gebied van slim beweiden, efficiënt voeren, mest verwaarden, dier- en milieuvriendelijke huisvesting, langere levensduur of het management van de koeien en het bedrijf. Allemaal om te zorgen dat ook in de toekomst voldoende, gezonde en veilige zuivel wordt geproduceerd met respect voor mens, dier en milieu.
Inspirerende omgeving

Dairy Campus is onderdeel van Wageningen Livestock Research. Het is een inspirerende omgeving voor iedereen die werkzaam is in de zuivelsector. Alle melkveestallen op Dairy Campus hebben een eigen onderzoeksfunctie. Met 550 melkkoeien, zes melkveestallen, een praktijkstal en ruim 300 hectare grond en trainings- en vergaderfaciliteiten is Dairy Campus dé ontmoetingsplek voor iedereen die met de zuivelsector te maken heeft.

Dairy Campus is hét onderzoek- en praktijkcentrum voor de melkveehouderij en zuivelketen waar het draait om innovatie, onderzoek, educatie en praktijkleren. Wereldwijd kent Dairy Campus zijn gelijke niet, hier werken onderzoekers uit verschillende disciplines samen met het bedrijfsleven, onderwijs en de melkveehouders. Wetenschap en praktijk zitten hier onder één dak. Alle activiteiten zijn gericht op de ontwikkeling van een duurzame zuivelketen. De koeien produceren hier niet alleen melk, maar vooral ook data en kennis
Onderzoek voor de toekomst De Nederlandse zuivelsector is steeds op zoek naar een duurzamere en efficiëntere manier om zuivel te produceren. Op Dairy Campus worden de nieuwste onderzoeken voor de melkveehouderij van morgen uitgevoerd.

74
Managers: Kees de Koning en Frank Jorna
Kees de Koning Frank Jorna
DLV Advies Postbus 511 5400 AM Uden 0413 336800 info@dlvadvies.nl www.dlvadvies.nl Contactpersonen: Paul Bens (directeur), Herrold Lammertink (directeur), Jos de Groot (directeur) Harm Wientjes (projectaccountmanager) PMS 361C PMS 3025C ZUIVEL IN ZICHT / 2022 KENNIS- EN ADVIESINSTELLINGEN
DLV Advies is een onafhankelijk adviesbedrijf voor ondernemers, bedrijven en instanties die actief zijn in de agrarische sector. Wij staan voor Advies én Resultaat. Geen mooie praat jes, maar eerlijk en oprecht advies gericht op concreet resultaat. Met onze brede kennis van agrarische bedrijven zetten wij u op het juiste spoor van resultaatgericht ondernemen. Onze kennis - samen met uw vakmanschap - is de sleutel tot resultaat. DLV is daarom méér dan advies…
Onze specialisten adviseren op de terreinen bouw, financieel management, mest, energie, makelaardij, schade en het verbinden van keten partijen.
Naast individuele advisering op bedrijfsniveau begeleidt DLV Advies agrarische studiegroepen en zijn wij actief in innovatieve Agri & Foodprojecten. DLV Advies adviseert dan ook meer dan alleen ondernemers in de agrarische sector. Ook juristen, verzekeraars, financiers, accoun tants en overheden kunnen bij ons terecht. Door het brede werkterrein en onze diepgewortelde
kennis overzien we als geen ander het gehele agrarische speelveld. De combinatie van prak tische agrarische kennis en inzicht in de keten maakt van DLV Advies dé partner voor advies & resultaat.
Flynth adviseurs en accountants




Meander 261 6825 MC Arnhem 088 23 67 777 agro@flynth.nl www.flynth.nl
Flynth adviseurs en accountants stimuleert ondernemers en haar werknemers om het maximale uit zichzelf te halen. We voorzien onze klanten tijdig met relevante cijfers, geven advies en verlenen zekerheid op basis van de laatste inzichten vanuit de markt en wet- en regelgeving. Met 1500 medewerkers en zo’n 60 vestigingen zijn we Nederlands’ grootste adviseur en accountant voor het midden- en kleinbedrijf. Flynth is ontstaan vanuit een coöperatie en brengt dit gedachtegoed nog steeds in praktijk. We zijn er voor de ondernemer én de onderneming in alle levensfasen.
De melk- en rundveehouderij wordt steeds kennisintensiever. Tegelijkertijd staan de marges in uw bedrijfstak onder druk. Er zijn veel mogelijkheden om uw rendement zo hoog mogelijk te houden.
75
Paul Bens Herrold Lammertink
Jos de Groot Harm Wientjes
ZUIVEL IN ZICHT / 2022 KENNIS- EN ADVIESINSTELLINGEN
De gespecialiseerde adviseurs van Flynth ondersteunen u graag met strategisch advies, bijvoorbeeld rondom:
• Uitbreiding stal en/of aankoop grond
• Eigendom en investering in coöperaties
• Overdracht aan de volgende generatie
• Vergunningen, financiering, verzekeringen
Foodvalley NL
Bronland 10F 6708 WH Wageningen info@foodvalley.nl www.foodvalley.nl 0317 42 70 95
Directie: Marjolein Brasz (directeur)
Foodvalley is het kennisintensieve agrifood ecosysteem in Nederland waar vele bedrijven van startups tot en met multinationals en kennisinstellingen samen werken aan innovatieve oplossingen, gezonde voeding en duurzame productie. Foodvalley NL versnelt innovatie door bedrijven met kennisinstellingen, overheid en onderwijs binnen en buiten Nederland met elkaar te verbinden.
FoodService Instituut Nederland

Dr. Willem Dreeslaan 1C, 6721 ND Bennekom Postbus 615, 6710 BP Ede
Directie: Inga Blokker
Bestuursvoorzitter: Walter Seib
Drie bestuursleden vanuit de formules: Rob Heesen, Albert Heijn (Foodservice, Concepten & Realisatie), Henri Froeling, Vital Food Group, Teun Verheij, Albron
Twee bestuursleden vanuit de grossiers: Freek van Beek, Lekkerland, Dries Bögels, Sligro
Drie bestuursleden vanuit de leveranciers: Bas Padberg, Arla Foods, Paul van Haeren, Johma, Eveline Nederlof, Unilever Foodsolutions
Het FoodService Instituut Nederland (FSIN) is het onafhankelijke kennisinstituut voor de buitenshuisconsumptie. Het FSIN is een vereniging die tot doel heeft om cijfers en analyses over het koopgedrag van de consument rond voedings- en genotmiddelen in kaart te brengen en met hulp van inzichten van experts die door te vertalen naar Monitors en Outlooks voor de komende jaren. Het FSIN richt zich primair op de Foodservice kanalen, maar brengt alle kanalen die voedings- en genotmiddelen verkopen in kaart. Het FSIN heeft ruim 215 leden
76
ZUIVEL IN ZICHT / 2022 KENNIS- EN ADVIESINSTELLINGEN
die met elkaar de hele bedrijfskolom afdekken (leveranciers, grossiers en outletformules). Een bestuur van 9 personen vanuit de leden bepaalt het beleid en houdt toezicht op de organisatie. Het FSIN publiceert jaarlijks diverse kennisproducten en organiseert congressen en rondetafel sessies voor haar leden met als uitgangspunt het delen van kennis.
Stichting Foodspecialiteiten Nederland
Blekerijlaan 1, 3447 GR Woerden 0348-419771
www.foodspecialiteitenwinkels.nl & www.vakbeursfoodspecialiteiten.nl www.kaasweek.nl
Bestuur: Hans Koelemij (voorzitter), Harrie ten Have, Inge Overeem, Pieter Renkema, Edwin Schreff en Astrid Willems
Directeur: Rick Brantenaar

De stichting heeft ten doel het adviseren, stimuleren en ondersteunen van activiteiten, die tot gevolg hebben dat de kwaliteit van het zelfstandig ondernemerschap in de detailhandel in foodspecialiteiten verder wordt vergroot, en voorts al hetgeen wat hiermee verband houdt, of daartoe bevorderlijk kan zijn, in de ruimste zins des woords. Activiteiten die plaatsvinden zijn: het
bevorderen (en doen) van onderzoek, het (doen) organiseren van beurzen, competities en prijsuitreikingen, het (doen) organiseren van studiedagen en studiereizen, het (doen) organiseren van de certificering van foodspecialiteitenwinkels.
Royal GD

Arnsbergstraat 7, 7418 EZ Deventer Postbus 9, 7400 AA Deventer 088-2025500 info@gddiergezondheid.nl www.gddiergezondheid.nl
Samen werken aan diergezondheid, in het belang van dier, dierhouder en samenleving. DIt is de missie waar we al meer dan honderd jaar voor staan. Royal GD is een onafhankelijk en marktgericht bedrijf. Met 500 medewerkers werken we elke dag aan de gezondheid van landbouwhuisdieren en gezelschapsdieren. GD is gevestigd in Deventer. In 2021 realiseerde de GD Group een geconsolideerde omzet van 85 miljoen euro. Voor de bijna 5 miljoen laboratoriumbepalingen die we per jaar uitvoeren, hebben we één van de grootste veterinaire laboratoriums ter wereld tot onze beschikking. Daarnaast beschikken we over een team van dierenartsen, specialisten en wetenschappers. Zij voeren diergezondheidsmonitoring uit, doen praktijkgericht onderzoek en ontwikkelen programma’s voor dierziektepreventie en
77 ZUIVEL IN ZICHT / 2022 KENNIS- EN ADVIESINSTELLINGEN
Rick Brantenaar
-bestrijding. De combinatie van diagnostiek en diergezondheidsexpertise is wat GD zo uniek maakt. Hiermee kunnen we producten en diensten aanbieden die niet alleen zorgen voor verbetering van de diergezondheid, maar ook voor de klant gemak en een goed rendement opleveren.
Platform Boerderijeducatie Nederland
Steegstraat 5, 6041 EA Roermond info@boerderijeducatienederland.nl www.boerderijeducatienederland.nl
Voorzitter: A. Monteny Secretaris: M. Theunissen
Het Platform Boerderijeducatie Nederland bestaat uit een samenwerking van regionale initiatieven op het gebied van boerderijeducatie door het hele land. Partijen willen hierdoor komen tot een verdere professionalisering en uniformering van boerderijeducatie in Nederland door middel van het Keurmerk Boerderijeducatie Nederland en door gebruik te maken van elkaars expertise. Educatie aan jongeren over voedsel en de oorsprong daarvan vormt de basis voor meer aandacht voor duurzame productie en consumptie van voedsel. De LTO vakgroep Multifunctionele landbouw is verantwoordelijk voor het aansturen van de uitvoerende taken, het coördineren en het gezamenlijk met de regionale initiatieven uitvoeren van activiteiten. Het platform wordt financieel ondersteund
door diverse agrarische sectoren, waaronder de melkveehouderij via ZuivelNL en door de overheid in de vorm van het Jong Leren Etenprogramma.
Stichting Top Institute Food and Nutrition
Agro Business Park 82 6708 PW Wageningen 088-0228000 info@tifn.nl www.tifn.nl
Themadirecteuren: Rob Beudeker, Wouter-Jan Schouten
TiFN is een publiek-privaat samenwerkingsverband voor multi- en interdisciplinair onderzoek in voedsel en voeding. Wetenschappers met verschillende achtergronden werken nauw samen binnen projecten die elk werken aan de belangrijkste uitdagingen voor de foodsector:
• Consumentengedrag
• Effect van voeding op gezondheid
• Goede nutritionele waarde van voeding
• Effectieve voeding voor het individu
• Regeneratieve landbouw
• Milde verwerking en optimaal gebruik van grondstoffen
• Minimalisering van voedselverspilling
78 ZUIVEL IN ZICHT / 2022 KENNIS- EN ADVIESINSTELLINGEN
TKI Agri&Food
Trouw Nutrition

Agro Business Park 82
6708 PW Wageningen 06-14328077 info@tki-agrifood.nl www.topsectoragrifood.nl



Directie: Dr.ir. C.D. de Gooijer
Postbus 229, 3800 AG Amersfoort Contactpersoon: Jet Huijser jet.huijser@trouwnutrition.com www.trouwnutrition.com
Trouw Nutrition Research and Development: John Doelman (Director Trouw Nutrition R&D) Javier Martin Tereso ( Manager Ruminants Research)
Dr.ir. C.D. de Gooijer
Het TKI Agri & Food coördineert de totstandkoming van de Kennis -en Innovatieagenda van Topsector Agri & Food, verzorgt de onder-zoeksprogrammering en adviseert het Topteam Agri & Food over te maken afspraken met de Rijksoverheid. Ondernemers kunnen innovatiemakelaars inschakelen voor ondersteuning bij de ontwikkeling van innovatieve ideeën. Ook kunnen ze via verschillende projectvormen financiële steun krijgen.
Trouw Nutrition is internationaal toonaangevend in soort specifieke voeroplossingen bestaande uit voedingsconcepten, producten en kennis. De unieke combinatie van deze producten, modellen en diensten verhoogt de productiviteit en ondersteunt de gezondheid van dieren in alle levensfasen.
Het is onze missie om de wetenschap te vertalen naar haalbare, praktische oplossingen voor het voederbeheer en het beheer van veehouderijen zodat klanten vlees, eieren en melk van hoge kwaliteit kunnen produceren. We reiken voedingsproducenten technologie aan waarmee ze advies en gegevens binnen handbereik hebben.
79 ZUIVEL IN ZICHT / 2022 KENNIS- EN ADVIESINSTELLINGEN
John Doelma Javier Martin Tereso
We wijden al ruim 90 jaar aan innovatie en de ontwikkeling van slimmere en duurzamere manieren voor het opfokken van gezonde boerderijdieren. Het begon allemaal heel bescheiden in Nederland - waar we wereldwijd gekend stonden om onze uitmuntendheid in duurzame landbouw - en we zijn intussen uitgegroeid tot een onderneming die 105 landen ter wereld aandoet. Doordat we deel uitmaken van Nutreco, met een unieke positie en een uniek netwerk, kunnen we sterke partnerschappen uitbouwen in onze sector. Het bedrijf is al sinds het begin begaan met duurzaamheid en innovatie - en moedigt ons aan om onze gezamenlijke missie ‘Feeding the Future’ uit te dragen.
Bij Trouw Nutrition doen we alles met passie en een wetenschappelijke basis. Onze ruim 8.000 medewerkers zijn erg begaan met wat ze doen, met elkaar en het milieu waarin we werken. Om onze gezamenlijke missie ‘Feeding the Future’ te kunnen verwezenlijken, houden we vast aan vier duidelijke kernwaarden: ‘innovative’ (innovatief), ‘caring’ (zorgend), ‘collaborative’ (samen) en ‘capable’ (bekwaam), die in de hele groep worden uitgedragen. Ze worden ondersteund door de SHV-waarden: integriteit en loyaliteit.
VLB - Vereniging van Accountants- en Belastingadviesbureaus

Agro Business Park 85, 6708 PV Wageningen 073-5230412
(Bernadette Roos, algemeen secretaris VLB) vlb@vlb.nl www.vlb.nl
Bestuur: mr. Ronald Meijers (ABAB), drs. Guus Delgers RA (Accon avm), Fou-Khan Tsang RA (voorzitter, Alfa), drs. Bob Seemann RA (plaatsvervangend voorzitter, Countus), drs. Bas Hidding RA (Flynth) en mr. Bernadette Roos-van Diemen (secretaris)
De VLB is een vereniging die de fiscaal/juridische en bedrijfskundige belangen op agrarisch gebied behartigt voor haar leden ABAB, Accon avm, Alfa, Countus en Flynth.De VLB bestaat uit de vaksecties Agro Bedrijfskunde, Recht en Elektronische uitwisseling. In de vaksectie Agro Bedrijfskunde worden de onderwerpen voor de gezamenlijke belangenbehartiging op het terrein agro bedrijfskunde en agro advies afgestemd. De vaksectie Recht behartigt de belangen van de leden op agro fiscaal en agro juridisch terrein. De vaksectie Elektronische uitwisseling stelt zich ten doel om de uitwisseling van gegevens in de ketens rondom en binnen de agrarische sector transparant en betrouwbaar te laten zijn alsmede om de uitwisseling met uitvragende partijen zoals de overheid, efficiënter te maken.
80 ZUIVEL IN ZICHT / 2022 KENNIS- EN ADVIESINSTELLINGEN
Wageningen University & Research
Wageningen University & Research houdt zich binnen verschillende projecten bezig met onder zoek en onderwijs op het gebied van zuivel.
Milk Genomics project
Costerweg 50
Postbus 9101, 6700 HB Wageningen 0317-480100 (fax 484884) Info@wur.nl - www.wur.nl
Raad van Bestuur: prof. dr. ir. L.O. Fresco (voorzitter), prof.dr.ir. A.P.J. Mol (rector magnificus), L.A.C. Buchwaldt, MBA
‘To explore the potential of nature to improve the quality of life ‘
Dat is de missie van Wageningen University & Research. Onze 6.500 medewerkers en 10.000 studenten uit ruim honderd landen werken in ons domein van gezonde voeding en leefom geving overal ter wereld, zowel voor overhe den als voor het bedrijfsleven. De kracht van Wageningen University & Research ligt in de bun deling van gespecialiseerde onderzoeksinstituten en Wageningen University in de samenwerking vanuit verschillende natuur-, technologische en maatschappijwetenschappelijke disciplines. Daardoor kunnen wetenschappelijke doorbraken snel in de praktijk en in het onderwijs worden vertaald, dat is de Wageningen Aanpak. De wetenschappelijke kwaliteit van Wageningen University & Research wordt bevestigd door de prominente positie die wij innemen in de interna tionale rankings en citatie-indexen. Het domein van Wageningen UR bestaat uit drie samenhan gende kerngebieden: voeding en voedselpro ductie, leefomgeving en gezondheid, leefstijl en levensomstandigheden.
Wageningen University & Research, de Nederlandse Zuivel Organisatie (NZO) en fokkerijorganisatie CRV werken gezamenlijk aan kennis op het gebied van de samenstelling van melk. Dit programma wordt mede gefi nancierd door de Stichting voor Technologische Wetenschappen (STW), het ministerie van EZ en de provinciale overheden van Gelderland en Overijssel. Het Milk Genomics initiatief heeft als doel het identificeren van de genen die bijdragen aan de natuurlijke variatie in de kwaliteitsaspec ten van melk, in het bijzonder vetten en eiwitten. Voor het onderzoek is een database aangelegd met gegevens verzameld aan circa 2.000 koeien op zo’n 400 bedrijven. Voor een overzicht van de resultaten tot op dit moment: www.milkgenomics.nl.
Contactpersonen: prof.dr. M.A.M. Groenen, hoogleraar Fokkerij en genetica, tel. 0317-482335
Meer informatie: www.wur.nl/abg
Master specialisatie Dairy Science and Technology
Dairy Science and Technology is een specialisatie binnen de Masteropleiding Food Technology die zich richt op alle aspecten van de zuivelketen. De specialisatie wordt gevolgd door 20 stu denten waarvan het merendeel afkomstig uit Nederland, de EU, Zuid-Oost Azië en ZuidAmerika.
Contactpersonen: ir. H.J.F. (Hein) van Valenberg, universitair docent, tel. 0317-482284, hein.vanvalenberg@wur.nl.
81 ZUIVEL IN ZICHT / 2022 KENNIS- EN ADVIESINSTELLINGEN
Wageningen Economic Research
Wageningen Livestock Research
Prinses Beatrixlaan 582 - 528 2595 BM Den Haag 070-3358330 (fax 3615624) www.wur.nl/economic-research
Directie: prof.dr.ir. J.G.A.J. (Jack) van der Vorst prof.dr.ir. J.G.A.J. (Jack) van der Vorst Wageningen Economic Research is een interna tionaal toonaangevend, sociaaleconomisch on derzoeksinstituut. De unieke data, modellen en kennis van het Wageningen Economic Research ondersteunen opdrachtgevers bij beleid en be sluitvorming en dragen uiteindelijk bij aan een duurzamere wereld.
De Elst 1 Postbus 338, 6700 AH Wageningen info.livestockresearch@wur.nl www.wur.nl/livestock
Directie: G. van Duinkerken (business unit manager)

Excellence in Livestock Innovations Wageningen Livestock Research is een internationaal opererende kennispartner voor de veehouderij. Samen met de overheid, het bedrijfsleven en maatschappelijke organisaties staan wij aan de basis van grensverleggende en innovatieve ontwikkelingen voor de agrarische sector. Voor nu, maar zeker ook voor toekomstige generaties. We ontwikkelen kennis voor een duurzame, zorgvuldige en renderende veehouderij, vertalen deze naar praktijkgerichte oplossingen en innovaties, en zorgen voor doorstroming van deze kennis. Onze wetenschappelijke kennis op het gebied van veehouderijsystemen en van voeding, genetica, welzijn en milieuimpact van landbouwhuisdieren integreren we, samen met onze klanten en de praktijk, tot veehouderijconcepten voor de 21e eeuw.

82 ZUIVEL IN ZICHT / 2022 KENNIS- EN ADVIESINSTELLINGEN
G. van Duinkerken
Deskundig en veelzijdig
Wageningen Livestock Research heeft uitgebreide kennis en expertise om complexe vraagstukken om te zetten in innovatieve marktgerichte oplossingen op het gebied van: Diervoeding, Fokkerij en genomica, Dierenwelzijn en gezondheid, Veehouderij en omgeving. Verder beschikt Wageningen Livestock Research over uitgebreide en state-of-the art laboratoria, dierfaciliteiten en praktijkcentra, waaronder Dairy Campus. Wageningen Livestock Research is onderdeel van (Wageningen University & Research) en is NEN-EN-ISO 9001:2015 gecertificeerd.
83 ZUIVEL IN ZICHT / 2022 KENNIS- EN ADVIESINSTELLINGEN
Controle Orgaan Kwaliteits Zaken
Fokkerstraat 1, 3833 LD Leusden
Postbus 250, 3833 LD Leusden 033-4965696 www.cokz.nl
Bestuur: Mr. drs. Ing. D. Duijzer (voorzitter) Leiding: ir. W.J.H. van der Sande (directeur)
Organisatie
Het COKZ is dé onafhankelijke Nederlandse controle-instelling voor de zuivelsector en de eiersector. Het COKZ controleert op de naleving van wet- en regelgeving op het gebied van kwaliteit, voedselveiligheid en etikettering van zuivel, eieren en eiproducten en op de handelsnormen voor pluimveevlees.
• Door middel van controle, toezicht en kennis van de wetgeving, ziet het COKZ toe op de naleving van de regelgeving. Het COKZ doet dit voor en in opdracht van de overheid.
• Het COKZ is een privaatrechtelijke controleinstelling, die zelf geen producten produceert of verhandelt.
• De werkzaamheden worden uitgevoerd in het kader van de nationale of Europese weten regelgeving en staan onder toezicht van de Nederlandse overheid.
Activiteiten
Het COKZ voert de volgende werkzaamheden uit:
• houdt toezicht op de naleving van de Wet dieren;
• houdt toezicht op de naleving van het EU Hygiënepakket;
• houdt toezicht op EU-verordening Dierlijke bijproducten;
• controleert in het kader van Cross compliance.
• houdt toezicht op derde landen eisen ten behoeve van de export;
• geeft exportcertificaten zuivel af;
• geeft voorcertificaat eieren en eiproducten af;
Bestuur: Mr. Drs. Ing. D. Duijzer (voorzitter), Ir. C.A.C.J. Oomen (vicevoorzitter), drs. F.J.P. F. van Luin (bestuurslid), Ir. M. Hovenkamp (bestuurslid), Dr. Ir. A.G.J. Velthuis (bestuurslid)
Directie: W.J.H. van der Sande (directeur). De directeur vervult tevens de rol van secretaris en penningmeester van het bestuur van COKZ.
84 ZUIVEL IN ZICHT / 2022 OVERHEID EN TOEZICHT / NEDERLAND
Ministerie van Landbouw, Natuur en Voedselkwaliteit


Bezuidenhoutseweg 73
Postbus 20401 2500 EK Den Haag 070-3798911
Bewindspersoon: Henk Staghouwer (minister van Landbouw, Natuur en Voedselkwaliteit)

NVWA - Nederlandse Voedsel en Waren Autoriteit
Catharijnesingel 59
Postbus 43006, 3540 AA Utrecht 088-223 33 33 info@nvwa.nl www.nvwa.nl NVWA Klantcontactcentrum: 0900-03 88
Meldingen doorgeven via: www.nvwa.nl/onderwerpen/melding-doen U kunt hier meldingen doorgeven over hygiëne, roken in openbare ruimtes, de betrouwbaarheid van gebruiksartikelen, dierziekten en dierenwelzijn.
Skal Biocontrole
Het ministerie van Landbouw, Natuur en Voedselkwaliteit staat voor een eerlijke en verantwoorde landbouw en visserij. Boeren, tuinders en vissers moeten economisch perspectief hebben en produceren in verbondenheid met waarden van duurzaamheid en welzijn. Samen met alle betrokkenen wordt er gewerkt aan het herstel en behoud van Nederlandse natuur. Het ministerie van LNV wil de internationale koppositie van de agrarische sector verstevigen met een nadruk op het benutten van kennis en innovatie. Daarmee draagt Nederland bij aan de aanpak van het wereldvoedselvraagstuk. Verder stimuleert het ministerie de vitalisering van de plattelandsregio’s in Nederland.
Postbus 384, 8000 AJ Zwolle 038–4268181 info@skal.nl www.skal.nl
Bestuur: Renée Bergkamp (voorzitter) Directie: Nicolette Klijn (directeur)
85 ZUIVEL IN ZICHT / 2022 OVERHEID EN TOEZICHT / NEDERLAND
Henk Staghouwer
Renée Bergkamp Nicolette Klijn
Skal houdt toezicht op de naleving van de wettelijke productievoorschriften voor de biologische productie in Nederland. Richtinggevend voor deze voorschriften zijn Europese Verordening (EU) nr. 2018/848.
Skal houdt toezicht in opdracht van het ministerie van LNV. Het betreft zowel de primaire agrarische productie als de verwerking van agrarische producten tot levensmiddelen, en de verkoop hiervan.
Ook houdt Skal toezicht op bedrijven die biologische producten importeren uit landen van buiten de EU en handels- en opslagbedrijven voorzover deze niet direct aan de eindconsument leveren. Ondernemers die biologische producten op de markt willen brengen, moeten zich bij Skal laten registreren en een certificatie-overeenkomst afsluiten. De kosten van het toezicht door Skal worden door de geregistreerde ondernemers gezamenlijk gedragen via een door het ministerie goedgekeurd tariefsysteem. Momenteel staan ruim 2200 agrarische bedrijven en meer dan 3300 verwerkende, import-, handels- en opslagbedrijven bij Skal geregistreerd, en meer dan 200 verkooppunten. Biologische producten die door Skal zijn gecertificeerd mogen het Europese bio-keurmerk voeren en moeten in principe volledig uit biologische agrarische ingrediënten bestaan. Skal werkt samen met andere controle-instanties zoals de NVWA en douane maar ook in internationaal verband (EOCC, de Europese associatie van biocertifceerders).
Tweede Kamer der Staten Generaal
Bezuidenhoutseweg 67, 2594 AC Den Haag www.tweedekamer.nl Vaste Commissie voor Landbouw, Natuur en Voedselkwaliteit Prinses Irenestraat 6, 2595 BD Den Haag Secretariaat Vaste Commissie voor LNV Postbus 20018, 2500 EA Den Haag 070-3182037
cie.lnv@tweedekamer.nl
Leden
• Amhaouch, Mustafa CDA (m.amhaouch@tweedekamer.nl)
• Baarle, Stephan van DENK (s.vbaarle@tweedekamer.nl)
• Beckerman, Sandra SP (s.beckerman@tweedekamer.nl)
• Bisschop, Roelof SGP (r.bisschop@tweedekamer.nl)
• Boswijk,Derk CDA (d.boswijk@tweedekamer.nl)
• Boucke, Raoul D66 (r.boucke@tweedekamer.nl)
• Bromet, Laura GL (l.bromet@tweedekamer.nl)
• Campen, Thom van VVD (a.vcampen@tweedekamer.nl)
• Eppink, Derk Jan JA2 (d.eppink@tweedekamer.nl)
• Erkens, Silvio VVD (s.erkens@tweedekamer.nl)
• Geurts, Jaco CDA (j.geurts@tweedekamer.nl)
• Ginneken, Lisa van D66 (l.vginneken@tweedekamer.nl)
• Graus, Dion PVV (d.graus@tweedekamer.nl)
86 ZUIVEL IN ZICHT / 2022 OVERHEID EN TOEZICHT / NEDERLAND
• Grinwis,Pieter CU (p.grinwis@tweedekamer.nl)
• Groot, Peter de VVD (p.dgroot@tweedekamer.nl)
• Groot, Tjeerd de D66 (t.dgroot@tweedekamer.nl)
• Haan, Liane den Den Haan (l.dhaan@tweedekamer.nl)
• Hagen, Kiki D66 (k.hagen@tweedekamer.nl)
• Haverkort, Erik VVD (e.haverkort@tweedekamer.nl)
• Hijink, Maarten SP (m.hijink@tweedekamer.nl)
• Koekkoek, Marieke VOLT (m.koekkoek@tweedekamer.nl)
• Kops, Alexander PVV (a.kops@tweedekamer.nl)
• Kröger, Susanne GL (s.kroger@tweedekamer.nl)
• Meijeren, Gideon van FVD (g.f.c.vmeijeren@tweedekamer.nl)
• Mulder Edgar PVV (edgar.mulder@tweedekamer.nl)
• Neef Daan de VVD (d.dneef@tweedekamer.nl)
• Plas, Caroline van der BBB (c.vdplas@tweedekamer.nl)
• Anne-Marijke Podt D66 (a.podt@tweedekamer.nl)
• Simons, Sylvana BIJ1 (s.simons@tweedekamer.nl)
• Strolenberg, Mark VVD (m.strolenberg@tweedekamer.nl)
• Thijssen, Joris PvdA (j.thijssen@tweedekamer.nl)
• Valstar, Peter VVD (p.valstar@tweedekamer.nl)
• Vestering, Leonie PvdD (leonie.vestering@tweedekamer.nl)
87 ZUIVEL IN ZICHT / 2022 OVERHEID EN TOEZICHT / NEDERLAND
BeNeLuxSmelt Association of Processed Cheese Manufactures
Van Stolkweg 31 2585 JN Den Haag 070-4131910
Voorzitter: D.W.P. Kuijl
BeNeLuxSmelt houdt zich bezig met de collectieve belangenbehartiging voor de smeltkaasindustrie. In BeNeLuxSmelt zijn particuliere en coöperatieve smeltkaasbedrijven verenigd.
Leden
Kaptein PCF, Industrielaan 3, 1474 MR Oosthuizen (0299 401951) www.kaptein.info
Kasi Food, 3e Industrieweg 5d 3411 MD Lopik (0348 558080) www.kasifood.nl
Koninklijke ERU, Middellandse Zee 7, 3446 GC Woerden (0348 578411) www.eru.eu
St. Paul NV, Industriepark Rozen Weverslaan 20 B-9160 Lokeren België (+32 9 3488119) www.stpaul.be
Vonk Culinary Cheese VCC, Industrieweg-Zuid 1315 3520 Zonhoven, België (+32 11 392546) www.vcc.be
Bond van Boerderijzuivelbereiders

Postbus 1, 4170 AA Herwijnen 06 83 96 25 83 secretariaat@boerderijzuivel.nl www.boerderijzuivel.nl
Bestuur: Voorzitter Theo Dekker, vicevoorzitter Cees Slob, penningmeester Jeantine van Dusseldorp, secretaris Heleen Brantenaar, bestuursleden Wim Meure, Marije van der Poel en Willem van der Schans, Ard van Wees
De BBZ telt een kleine 300 leden. Dit zijn melkveehouders die koeien-, geiten-, schapen-, paarden-, of buffelmelk verwerken tot zuivelproducten zoals boerenkaas, kaas van de boerderij, zachte kaas, boerenboter, kwark, yoghurt, ijs, karnemelk, vla en papsoorten waaraan al dan niet extra ingrediënten, zoals vruchten of kruiden zijn toegevoegd.
De BBZ stelt zich ten doel de belangen van de leden te behartigen in de meest uitgebreide zin van het woord.
88 ZUIVEL IN ZICHT / 2022 BELANGENBEHARTIGING / NEDERLAND
Zij geeft uitvoering aan deze doelstelling door:
• Lobby bij wet- en regelgevingstrajecten

• Bevorderen van scholing en opleiding via de zuivelacademie en studieclubs
• Het verstrekken van informatie en voorlichting in het Vakblad Boer en Zuivel
• Contact onderhouden met overheden en ketenpartijen
• Promotie van boerderijzuivelproducten: onder andere via de Graskaasactie, de Cum Laude Awards en de Oktober Boerenkaasmaand
De BBZ bevordert naamsbekendheid van boerderijzuivelproducten met collectieve campagnes zoals de Cum Laude Awards en de website Boerderijzuivel.nl. Leden van de BBZ kunnen zich voor handelstransacties baseren op de handelsvoorwaarden van de GemZu. Ook is er de mogelijkheid voor deelname aan het onderzoeksprogramma rauwe melk. De BBZ is actief betrokken bij de Noteringscommissie Kaas, gemaakt op de boerderij. De BBZ is dossierhouder voor de GTS (Gegarandeerde Traditionele Specialiteit) Boerenkaas. De BBZ controleert tevens op de naleving van het keurmerk ‘Echte Boerderijzuivel’ door de leden. De BBZ is eigenaar van het private woordbeeldmerk ‘kaas van de boerderij’.
Boerenkaasnotering, Commissie
p/a GemZu, Van Stolkweg 31, 2585 JN Den Haag 070-4131910 info@gemzu.nl
Voorzitter: C. Remijn
Noteringscommissie kaas gemaakt op de boerderij
De Commissie tot het vaststellen van een notering van kaas gemaakt op de boerderij is ingesteld door de Bond van Boerderij Zuivelbereiders (BBZ) en Gemzu.
Doelstelling
De commissie heeft tot taak het vaststellen van de notering voor Goudse kaas gemaakt op de boerderij voor 12 kg, 16 kg en zwaarder dan 20 kg. Daarnaast voor de Boeren Leidse 30+ en 48+ met kruiden. De commissie komt doorgaans iedere vier weken bijeen. Het doel van de commissie is een zodanige notering vast te stellen dat deze binnen nauwe grenzen een getrouw beeld geeft van de werkelijk betaalde prijzen. Zij baseert zich daarbij op marktomstandigheden en andere feiten, die de prijs van kaas gemaakt op de boerderij bepalen.
89 ZUIVEL IN ZICHT / 2022 BELANGENBEHARTIGING / NEDERLAND
CBL - Centraal Bureau Levensmiddelenhandel
Overgoo 13
Postbus 262, 2260 AG Leidschendam 070-3376200 info@cbl.nl www.cbl.nl
Directie: R. Roorda (algemeen directeur). ir. M.J.B. Jansen (directeur)


• Coopsupermarkten, Postbus 87, 6880 AB Velp (www.coop.nl)
• Deen Supermarkten, Postbus 139, 1620 AC Hoorn (www.deen.nl)
• DekaMarkt, Postbus 86, 1940 AB Beverwijk (www.dekamarkt.nl)
• Dirk, Postbus 86, 1940 AB Beverwijk (www.dirk.nl)
• Hoogvliet Supermarkten, Postbus 434, 2400 AK Alphen a/d Rijn (www.hoogvliet.com)
• Jan Linders, Postbus 72, 5854 ZG Bergen (www.janlinders.nl)
Het Centraal Bureau Levensmiddelenhandel (CBL) is de belangenbehartiger en spreekbuis van de supermarkten en foodservice in Nederland.
Het CBL houdt in politiek Den Haag continu de vinger aan de pols en voert regelmatig overleg met de verschillende ministeries. In Brussel worden de ontwikkelingen gevolgd via de Europese organisatie EuroCommerce. Als spreekbuis van de branche ontplooit het CBL activiteiten om de branche goed naar buiten te brengen.
Het CBL richt zich daarbij op de thema’s Gezondheid en voedselveiligheid, Duurzaamheid, Arbeidsmarkt en medewerkers en Sterke keten.
Leden
• Albert Heijn, Postbus 3000, 1500 HA Zaandam (www.ah.nl)
• Aldi, Postbus 147, 4100 AC Culemborg (www.aldi.nl)
• Bidfood, Postbus 440, 6710 BK Ede
• (www.bidfood.nl)
• Boni Markten, Postbus 1093, 3860 BB Nijkerk (www.bonisupermarkt.nl)
• Boon’s Markt, Postbus 3128, 3301 DC Dordrecht (www.boonsmarkt.nl)
• Jumbo Supermarkten, Postbus 8, 5460 AA Veghel (www.jumbosupermarkten.nl)
• Lekkerland, Postbus 128, 5690 AC Son (www.lekkerland.nl)
• Lidl Nederland, Postbus 198, 1270 AD Huizen (www.lidl.nl)
• Makro, Postbus 22579, 1100 DB Amsterdam (www.makro.nl)
• Nettorama, Postbus 182, 4900 AD Oosterhout (www.nettorama.nl)
• NS Stations Retailbedrijf
• Plus Retail, Postbus 21, 3730 AA De Bilt (www.plusretail.nl)
• Poiesz Supermarkten, Edisonstraat 3, 8606 JH Sneek (www.poiesz-supermarkten.nl)
• Sligro, Postbus 47, 5460 AA Veghel (www.sligro.nl)
• Spar, Postbus 147, 4760 AC Zevenbergen (www.spar.nl)
• Vakcentrum, Blekerijlaan 1, 3447 GR Woerden (www.vakcentrum.nl)
• Van Tol Retail (Dagwinkel, Recra, Springer), Postbus 64, 2410 AB Bodegraven (www.vantolversunie.com) (www.tolfood.com)
• Vomar Voordeelmarkt, Postbus 1100, 1810 KC Alkmaar (www.vomar.nl)
90 ZUIVEL IN ZICHT / 2022 BELANGENBEHARTIGING / NEDERLAND
R. Roorda M.J.B. Jansen
CBM - Coöperatieve Belangenvereniging Melkgeitenhouderij Midden Nederland ua.

Engelenburgstraat 19, 7391 AM Twello 0571-268280 info@cbmua.nl www.cbmua.nl

Voorzitter: M.J.M Tuinte Directeur: W.H. Brilman
De ca. 85 bij de coöperatie aangesloten leden, in Nederland, leveren in 2019 ca 89 miljoen kg geitenmelk.
De door CBM ingezamelde geitenmelk wordt verkocht aan hoofdzakelijk Nederlandse afnemers van geitenmelk die de geitenmelk verwerken tot kaas, consumptiemelk en kindervoeding. Verder verkopen we geitenmelk aan afnemers in Europa.
Collectief Praktiserende Dierenartsen
Postbus 9528 1006 GA Amsterdam info@cpd-online.nl www.cpd-online.nl
Bestuur: drs. K. Koenders-van Gog (Karien), voorzitter; drs. S.F. van Genugten (Fieke), vicevoorzitter; drs. R.J. Brouwer-Cummins (Rachel), secretaris; drs. M.J. LautenschutzSoethout (Maaike), penningmeester; drs. H.C. van Doorn (Marco), drs. Y.C.J. Kersten-Klomp (Yolanda); drs. C.G. de Kruif (Kees)




Algemeen secretaris: drs. S.J. de Groot (Hugo)
Het Collectief Praktiserende Dierenartsen (CPD) is dé onafhankelijke belangenbehartiger dóór en vóór practici. Het CPD heeft sinds haar oprichtingsvergadering op de Faculteit Diergeneeskunde op 19 december 2013 een succesvolle start en ontwikkeling doorgemaakt. Het CPD is een vereniging met algemene vergadering waarin praktiserende dierenartsen
91 ZUIVEL IN ZICHT / 2022 BELANGENBEHARTIGING / NEDERLAND
M.J.M. Tuinte W.H. Brilman
Karien Koenders Fieke van Genugten
stemrecht hebben. Het CPD hanteert de European Veterinary Code of Conduct die is opgesteld door de Federation of Veterinarians of Europe als algemeen afwegingskader voor haar aanpak en lobby. Daarbij stelt het CPD de belangen van de praktiserende dierenartsen en de praktijk centraal. Het CPD is voorstander van werkbare regels die het professionele handelen stimuleren en praktisch en niet star zijn. Het CPD onderhoudt over de positie en taken van de dierenarts en de gezondheidszorg voor dieren contacten met o.a. ministeries, NVWA, COKZ, Bureau Diergeneesmiddelen, Faculteit Diergeneeskunde. Voor de gezondheidszorg herkauwers heeft het CPD afgevaardigden in diverse organisaties o.a. de Diergeneesmiddelenautoriteit SDa; de ZuivelNL themagroep Rundergezondheidszorg DKR: adviseur Fieke van Genugten; de ZuivelNL DKR Stuurgroep Verantwoord Medicijngebruik Runderen: afgevaardigde Hugo de Groot; het College van Belanghebbenden Geborgde Rundveedierenarts van de Stichting Geborgde Dierenarts: afgevaardigden Annemarie OlsmanVrielink en Shaula Bouwman en is betrokken partij bij het Vertrouwensloket Welzijn Landbouwhuisdieren.
DDB - Dutch Dairymen Board
p/a Ged. Schuinesloot 3, 7776 PD Slagharen 06-30105890 (fax 084-742 24 27) info@ddb.nu www.ddb.nu
Bestuur: Sieta van Keimpema (voorzitter), Harm Jonker (penningmeester), Hennie de Zwaan (secretaris), Jan Aantjes (bestuurslid)
De DDB (Dutch Dairymen Board) is een belangenbehartiger voor melkveehouders die zich richt op wijzigingen in het zuivelbeleid die leiden tot een kostendekkende boerenmelkprijs, een gelijkwaardige positie in de zuivelketen voor melkveehouders en een duurzame Europese melkveehouderijsector. De DDB werd in 2006 opgericht en is grondlegger van de EMB (European Milk Board). De EMB behartigt de belangen van ongeveer 100.000 Europese melkveehouders die verdeeld zijn over 19 organisaties in 14 verschillende Europese landen. De activiteiten van de DDB en de EMB hebben op politiek niveau geleid tot een bredere discussie over de positie en het inkomensniveau van de Europese melkveehouders. Uit de EMB-acties van 2009 is de oprichting door de Europese Commissie van een High Level Expert Group on Milk voortgevloeid. Deze groep van ambtenaren heeft o.a. de opdracht gekregen om naar maatregelen te zoeken die de machtspositie van melkveehouders in de zuivelketen versterken. De DDB is de enige Nederlandse belangenorganisatie voor melkveehouders die rechtstreeks communiceert met deze High Level Expert Group on Milk.
92 ZUIVEL IN ZICHT / 2022 BELANGENBEHARTIGING / NEDERLAND
Fedecom
Afdeling Veehouderijtechniek
Einsteinbaan 1, 3439 NJ, Nieuwegein Postbus 2600, 3430 GA, Nieuwegein 030 6049111 www.fedecom.nl
Contactpersoon: G.W.J. Heerink (directeur), G.W.J. Heerink
Bestuur afdeling Veehouderij: J. van Dijck (voorzitter), A.J. de Bruin (vice-voorzitter), R. Scherpenzeel, M. Murk, E. van den Hengel
Branchevereniging Fedecom investeert collectief in innovatie, kennis(transfer) en vakmanschap ten dienste van het positioneren van de veehouderij in de maatschappij en markt. Fedecom bundelt de belangen van fabrikanten, importeurs en dealers van techniek en technologie voor de veehouderij.
Fedecom’s afdeling Veehouderijtechniek heeft ca. 100 lidbedrijven die leverancier zijn van producten/systemen voor huisvesting, klimaatregeling, voeren, melken, koelen, mestverwerking, mestopslag en managementsystemen voor de veehouderij. Nederland is in de (melk)veehouderij een land dat voorop loopt in de technische ontwikkelingen. Fedecom wil deze positie en ontwikkeling in het belang van de Nederlandse veehouders en gerelateerde agribusiness helpen uitbouwen.
FNLI - Federatie Nederlandse Levensmiddelen Industrie

Schenkkade 50 Postbus 96949, 2509 JH Den Haag 070-3365150 info@fnli.nl / www.fnli.nl



Directeur: Cees-Jan Adema Adjunct-directeur: Murk Boerstra
De Federatie Nederlandse Levensmiddelen Industrie (FNLI) is de koepelorganisatie en belangenbehartiger voor circa 500 verwerkende en importerende bedrijven en 18 brancheorganisaties in de Nederlandse voedingsmiddelensector. Als proactieve pleitbezorger voor de voedingsmiddelensector, één van de grootste industrietakken van Nederland, streeft zij naar een stevige inbedding in de Nederlandse samenleving als een gewaardeerde en verantwoordelijke sector. De FNLI is ook op Europees niveau
93 ZUIVEL IN ZICHT / 2022 BELANGENBEHARTIGING / NEDERLAND
Cees-Jan Adema Murk Boerstra
betrokken bij wet- en regelgeving en is lid van FoodDrinkEurope, de Europese koepelorganisatie van voedingsmiddelenproducenten.
FND - Federatie Nederlandse Diervoederketen
Louis Braillelaan 80 2719 EK Zoetermeer 06 - 53696470 info@diervoederketen.nl www.diervoederketen.nl
Coördinator & technisch voorzitter: Gerrianne Jansen
De Federatie Nederlandse Diervoederketen (FND) is een koepel van acht aangesloten branchever enigingen. Samen vertegenwoordigen zijn de ketenpartijen die diervoeders produceren van landbouwhuisdieren en gezelschapsdieren.
FNV
FNV Centraal Vakbondshuis
Hertogswetering 159, 3543 AS Utrecht Postbus 9208, 3506 GE Utrecht 088-368 0368
Woordvoerder Zuivel: Ron Vos 06-51256097, ron.vos@fnv.nl, 088- 3681066


94 ZUIVEL IN ZICHT / 2022 BELANGENBEHARTIGING / NEDERLAND
Genootschap t.b.v. Melkkunde
GemZu - Vereniging Gemeenschappelijk Zuivelsekretariaat
p.a. NIZO Food research BV
Postbus 20, 6710 BA Ede 06-22498364
secretariaat@genootschapmelkkunde.nl www.genootschapmelkkunde.nl Contactpersoon: Harm Abma (voorzitter)
Onderscheiden met de Koninklijke Erepenning. Het Genootschap ter bevordering van Melkkunde heeft als doelstelling het bevorderen van kennis over melk, de daaruit bereide producten en de toepassingen daarvan. Tegelijk beoogt het Genootschap de contacten tussen de leden, voornamelijk werkzaam in de melk- en zuivelsector, te bevorderen. Doelstelling is kort samen te vatten als kennisoverdracht en contactbevordering tussen de leden. Het genootschap kent een rijke geschiedenis en is in 1908 opgericht. Kennisoverdracht vindt plaats door 2 keer per jaar een symposium te organiseren en een nieuwsbrief uit te geven met uitgebreid verslag van de lezingen. Contact tussen de leden vindt plaats op het symposium. Voor leden is het een andere manier om mensen in de zuivelsector te ontmoeten. Daarnaast zijn de sprekers op de symposia van een goed niveau en is het een aantrekkelijke manier om snel op de hoogte te worden gebracht van een onderwerp.
Van Stolkweg 31, 2585 JN Den Haag 070-4131910 info@gemzu.nl www.gemzu.nl
Bestuur: J. Kos (voorzitter), P. van Leuven (vice-voorzitter), J. Anker, B. van Belleghem, F. van Stipdonk
Directie: O.F. Boersma
Gemzu behartigt de belangen van de in Nederland gevestigde zuivelhandel. De organisatie heeft drie afdelingen: kaas, boter(olie) en poedervormige melkproducten.
In deze drie afdelingen worden de productspecifieke zaken behandeld. In totaal zijn zo’n 130 bedrijven bij Gemzu aangesloten. Daarnaast voert Gemzu secretariaatswerkzaamheden uit voor:
• Stichting Nederlandse Zuivelbeurs (ZB)
• Vereniging Automatisering

• Kaasgroothandel (VAK)

• Stichting Nederlands Nationaal KaaskeurConcours (NNKC)
• Stichting Kwaliteitszorg Boerenkaas (Kb)
• Stichting Importeurs Buitenlandse Kaas (SIBK)
• Beneluxsmelt
• Nederlandse Geiten Zuivelorganisatie (NGZO)
• CAO voor het personeel werkzaam in het Partikulier Kaaspakhuisbedrijf
95 ZUIVEL IN ZICHT / 2022 BELANGENBEHARTIGING / NEDERLAND
Global Dairy Farmers
Hisfa
Postbus 8097 9702 KB Groningen (+31) (0)6-13872867 gdf-manager@globaldairyfarmers.com www.globaldairyfarmers.com

Bestuur: Ad van Velde, Alfons Beldman (voorzitters) en Co Daatselaar (penningmeester) Directie: Baukje Sinnige - de Beer
Global Dairy Farmers is een wereldwijd netwerk van melkveehouders en partners uit de zuivelindustrie. De deelnemers aan het netwerk discussiëren met elkaar over ontwikkelingen in de zuivelmarkt en nieuwe beleidsmaatregelen om van elkaar te leren en zo hun strategie scherp te houden. Vanuit het management worden nieuwsbrieven gestuurd aan de leden, maar tevens worden er congressen en studietrips georganiseerd. Daarnaast wordt met behulp van de melkveehouders, industrie en andere contacten wereldwijd jaarlijks een Dairy Outlook gemaakt en tweemaandelijks de Dairy Monitor waarin de trends op basis van emotie van melkveehouders wereldwijd wordt getoetst en een voorspelling geeft waar de markt in die regio’s naartoe gaat. Voor meer informatie, kijk op onze website of neem contact op met de GDF manager.
Hisfa is de Nederlandse Vereniging van Handelaren in Stro, Fourages en Aanverwante Produkten. Hisfa is de enige vereniging in Nederland die zich specifiek richt op de belangen van de handel in stro, hooi, fourages en aanverwante producten. Bij Hisfa zijn ruim 80 fouragebedrijven aangesloten. Hisfa heeft als belangrijkste doelstelling om de belangen van de handelaren in stro, hooi, fourages en aanverwante producten te behartigen. De bedrijven die bij Hisfa zijn aangesloten zijn met name actief in de levering van enkelvoudige veevoeders, zoals fourage en bijproducten uit de levensmiddelenindustrie. Een substantieel aantal van deze bedrijven houdt zich daarnaast bezig met transport, loonwerk, handel in organische mest of kunstmest etc.

96
Braillelaan 9 2289 CL Rijswijk 085 7731975 info@hisfa.nl www.hisfa.nl
ZUIVEL IN ZICHT / 2022 BELANGENBEHARTIGING / NEDERLAND
Kaasmerk Matec
Roomburgerweg 3A, 2314 XM Leiden 071-5820690 winus.sloot@kaasmerkmatec.com www.kaasmerkmatec.com
Directie: Winus Sloot
Kaasmerk Matec is de internationale leverancier van kaasmerken die op de kaas worden gelegd aan het begin van de kaasproductie. Het bedrijf heeft vestigingen in Nederland en Frankijk. Het kaasmerk biedt bescherming van naam en herkomst van de kaas en maakt kaas traceerbaar in de kaasproductie en verdere keten. Ook kan een (bedrijfs-)logo op een kaasmerk worden geprint en zijn er kaasmerken tot een diameter van 25 cm om er voor te zorgen dat indien de kaas versneden wordt ook de herkomst duidelijk blijft. Voor traceerbaarheid en voorraadbeheer bij de ambachtelijke kaasmaker is de webapp Ficaseo© ontwikkeld. Ficaseo© werkt door het unieke volgnummer geprint op het kaasmerk op de smartphone, tablet of pc in te voeren. Dat geeft inzicht en overzicht over de kaasproductie, -voorraad en verkoop van de ambachtelijke kaasmaker.
KB - Stichting Kwaliteitszorg Boerenkaas
Van Stolkweg 31, 2585 JN Den Haag 070-4131913 info@gemzu.nl www.boerenkaas.org/www.kb-kaas.nl
Bestuur: J.A.A. Loomans (voorzitter),
De Stichting KB is een initiatief van GEMZU. De Stichting KB geeft licenties af aan bereiders en groothandelaren in boerenkaas op basis van het KB kwaliteitssysteem. Tevens bewaakt en verbetert zij het systeem. De doelstelling van het KB kwaliteitssysteem is het garanderen van de kwaliteit en Nederlandse oorsprong van KB Boerenkaas. Een belangrijk deel van KB Boerenkaas vindt via de groot- en detailhandel zijn weg naar de consument. De ambachtelijke bedrijfsvoering en de kleinschaligheid van de kaasproducerende boeren hebben geleid tot de gezamenlijke aanpak om te komen tot een garantie voor kwaliteit en echtheid richting consument. De Stichting KB beheert het KB-kwaliteitssysteem en het ontwikkelde KB-keurmerk, dat staat voor een kwalitatief hoogstaand en ambachtelijk boerderijzuivelproduct van gegarandeerde Nederlandse herkomst.
97 ZUIVEL IN ZICHT / 2022 BELANGENBEHARTIGING / NEDERLAND
KNMvD
De Molen 77
Postbus 421, 3990 GE Houten 030-6348900 info@knmvd.nl www.knmvd.nl




Bestuur: mevr. drs. S.A.M. Deleu (voorzitter), mevr. drs. E. Smiet (penningmeester), drs. F.M. Meulders (voorzitter cluster Landbouwhuisdieren), dr. P.J.J. Mandigers (voorzitter cluster Gezelschapsdieren), dr. T.P. Frippiat (voorzitter cluster Paard), drs. B.D.S. de Ruiter (voorzitter cluster DIMEO)
Directie: A. Bolomey
De Koninklijke Nederlandse Maatschappij voor Diergeneeskunde is de beroepsvereniging van de Nederlandse dierenartsen. De vereniging telt circa 3.400 leden, die verschillende disciplines vertegenwoordigen. De KNMvD geeft op tal van plaatsen gevraagd en ongevraagd beleidsmatig advies met betrekking tot dierenwelzijn, diergezondheid, volksgezondheid en voedselveiligheid en is deelnemer/adviseur bij verschillende reguliere overlegstructuren.
In dit verband is er regelmatig en intensief overleg met de sector, de overheid en tal van andere organisaties.Het cluster Landbouwhuisdieren van de KNMvD vertegenwoordigt alle landbouwhuisdierenartsen. De rundveedierenarts verzorgt op het melkveebedrijf preventieve en curatieve diergezondheidszorg, zowel op dier– als op bedrijfsniveau. De rundveedierenarts is een multidisciplinair adviseur binnen een netwerk van begeleiders van de rundveehouder. Deze dierenarts heeft kennis en kunde op het gebied van dierenwelzijn, diergezondheid, bedrijfsmanagement, wet- en regelgeving, volksgezondheid en voedselveiligheid. Vanuit die rol levert de dierenarts een bijdrage aan de kwaliteitsborging in de melkveehouderij.
98 ZUIVEL IN ZICHT / 2022 BELANGENBEHARTIGING / NEDERLAND
Kwaliteitszorg Onderhoud Melkinstallaties Onderdeel van Qlip B.V. Zweedsestraat 1a 7202 CK Zutphen 088-7547014 kom@qlip.nl Contactpersoon: P.J.M. Huijsmans (manager KOM)
KOM -
Sophie Deleu Frans Meulders
KOM heeft ten doel gesteld het handhaven en waar nodig verbeteren van de kwaliteit van het onderhoud van melkinstallaties, melkmeetappa ratuur, sensoren en melkkoelinstallaties, alles in de ruimste zin van het woord. Voor de borging van de kwaliteit en onafhankelijkheid, als ook advisering, is een College van Deskundigen sa mengesteld uit belanghebbende organisaties die de doelstelling onderschrijven.
LTO Nederland
Bezuidenhoutseweg 105, 2594 AC Den Haag 070-3382700 (fax 3382710) www.lto.nl
LTO Nederland is een ondernemersorganisatie voor Nederlandse boeren en tuinders. Zij behartigt de belangen van 35.000 leden door te werken aan een gunstig ondernemersklimaat voor agrariërs in Nederland en Europa. LTO Nederland ondersteunt en verbindt ondernemers in de land- en tuinbouwsector. Als derde werkgeversorganisatie van Nederland zorgt LTO Nederland tevens voor goede arbeidsvoorwaarden voor alle mensen in de land- en tuinbouwsector. Zij kent negentien vakgroepen die de diversiteit van de land- en
tuinbouw weerspiegelen. Tien dierlijke en acht plantaardige vakgroepen en de vakgroep multifunctionele landbouw, en toetst haar inspanningen langs de thema’s; Voedsel & Gezondheid, Klimaat, Platteland & Stad en Ondernemerschap.
LTO vakgroep Melkveehouderij
Bezuidenhoutseweg 105, 2594 AC Den Haag 070-3382700 (fax 3382710) www.lto.nl


Samenstelling vakgroep: E. Wunnekink (voorzitter), H. Bakhuis, W. Brouwer de Koning, J. Verstraten , R. Derks en E. Vedder
Beleidsmedewerkers: A. Aalberts, C. van Rees
De vakgroep Melkveehouderij zet zich bij de politiek, maatschappij en ketenpartijen in voor de belangen van de Nederlandse melkveehouder. We werken daarvoor aan een gezond ondernemersklimaat en maatschappelijke waardering voor de melkveehouderij op basis van onze visie “Samen naar een nieuwe Wij”.
LTO vakgroep Melkgeitenhouderij
Bezuidenhoutseweg 105, 2594 AC Den Haag
Bestuur vakgroep: J. Tolboom (voorzitter), H. van Roekel, A. van der Schans en N. van Middelkoop
Beleidsmedewerker: J. Megens
99 ZUIVEL IN ZICHT / 2022 BELANGENBEHARTIGING / NEDERLAND
P.J.M. Huijsmans
De vakgroep Melkgeitenhouderij behartigt de belangen van de Nederlandse melkgeitenhouders. De vakgroep werkt samen met ketenpartners aan een gezonde en vertrouwde geitenketen, die zorg heeft voor mens, dier en producten. Een keten met een herkenbare waarde voor consumenten, geitenhouders en omgeving.

NAJK - Nederlands Agrarisch Jongeren Kontakt
Nevedi
Bemuurde Weerd OZ 12 3514 AN Utrecht 030-2769869 info@najk.nl www.najk.nl
NAJK behartigt de belangen van agrarische jongeren in Den Haag en Brussel, maar biedt ook actief handvatten tot ontwikkeling en beter ondernemerschap. Hiermee draagt NAJK enerzijds bij aan de persoonlijke ontwikkeling van jongeren verbonden met de agrarische sector en anderzijds aan de ontwikkeling van zelfbewuste en kundige jonge ondernemers die met beide benen in de maatschappij staan: de ondernemers van de toekomst.
Braillelaan 9 2289 CL Rijswijk 085 7731977 info@nevedi.nl www.nevedi.nl


Als brancheorganisatie van de diervoederindus trie behartigt Nevedi de collectieve belangen van de Nederlandse diervoederindustrie. Ruim 100 diervoederbedrijven en voerleveranciers zijn bij Nevedi aangesloten. Samen vertegenwoor digen zij circa 95% van de totale productie in Nederland. De sector bestaat uit fabrikanten van mengvoeders, premixen, kalvermelkpoeder en leveranciers van vochtrijke diervoeders (co-producten uit de levensmiddelenindustrie).
Centraal staat dat wij als vereniging belangen behartigen, bijdragend aan een gunstige economische ontwikkeling en maatschappelijke positie van aangesloten diervoederbedrijven in Nederland. Nevedi tracht samen met haar leden een positief ondernemingsklimaat te bereiken in dialoog en samenwerking met ketenpartners en relevante stakeholders als overheden en maat schappelijke organisaties.
100 ZUIVEL IN ZICHT / 2022 BELANGENBEHARTIGING / NEDERLAND
Henk Flipsen, directeur
NGZO - Nederlandse
GeitenZuivel Organisatie
Van Stolkweg 31 2585 JN Den Haag 070-413 19 15 www.ngzo.nl info@ngzo.nl
Bestuur: N.T.M. Verduin (voorzitter), W.A.P. Watzeels, W.H. Brilman, K. Hokse, J. Aarts, W. Vellema, O.F. Boersma (secretaris)
NIZO food research B.V.

Kernhemseweg 2, 6718 ZB EDE, The Netherlands P.O. Box 20, 6710 BA EDE 0318- 659511 info@nizo.com www.nizo.com

Directie: Gisella Frijlink, CEO, Nel Zoon, CSO, Jan Dick van der Nol, CFO, André van der Wulp, COO
De drie kernactiviteiten van de NGZO zijn crisesmanagement, woordvoering en lobby. De Nederlandse GeitenZuivel Organisatie (NGZO) heeft als doelstelling: de behartiging van de gemeenschappelijke belangen van Nederlandse verwerkers en inzamelaars van door derden geproduceerde geitenmelk. Het programma KwaliGeit van de NGZO is het ketenkwaliteitszorgsysteem voor de melkgeitenhouderij.
Consumenten verlangen vandaag de dag meer van levensmiddelen, producten dan ooit tevoren. Nieuwe producten, toegevoegde functionaliteiten, begrijpelijke korte labels en tegelijk duurzaam en gemaakt met de hoogste kwaliteitseisen. Dat levert de industrie nieuwe uitdagingen op. Gebruik van meer en andere proteïnen, duurzaam en clean en clear label zonder in te boeten op sensorische kwaliteiten, kwaliteit en betrouwbaarheid. NIZO is hierbij vele nieuwe en bestaande bedrijven van dienst. Ontstaan uit het Nederlands Instituut voor Zuivel onderzoek zijn we nu één van de meest geavanceerde, onafhankelijke contract research centra in de wereld. Met meer dan 70 jaar ervaring passen wij de zuivelkennis ook toe in niet zuivel toepassingen. Het is onze passie om voedsel gezonder, duurzamer en van nog betere, constante kwaliteit te maken door toepassingen van onze bewezen expertise en nieuwe technologische oplossingen te ontwikkelen. Ook produceert NIZO voor de
101 ZUIVEL IN ZICHT / 2022 BELANGENBEHARTIGING / NEDERLAND
voedingsmiddelen industrie proefproducties in haar eigen food grade pilot plant, één van de grootste van Europa. Onze klanten waarderen de toegepaste kennis van het hele product ontwikkelingsproces, van formulering tot productie die hun in staat stelt sneller marktintroducties door te voeren van ingrediënten en kant en klare producten.
NMV - Nederlandse Melkveehouders Vakbond
zoals mestbeleid, Natura 2000, KRW en diergezondheid. Tenslotte vindt NMV dat beleid te allen tijdegefundeerd dient te zijn op betrouwbaar onderzoek en feiten.
NNC-IDF
Benoordenhoutseweg 46 Postbus 93453, 2509 AL Den Haag 070-2191611
Secretariaat: ir. J.M.M. Jansen (secretaris) 06 46 80 68 25 www.zuivelnl.org/over-zuivelnl/ nederlands-nationaal-comité-van-idf www.fil-idf.org
Krachtighuizerweg 28, 3881 PD PUTTEN 06-21322313 info@nmv.nu www.nmv.nu
Woordvoerder: Sjoerd de Vries (secretaris a.i.)


NMV is een groeiende belangenorganisatie door melkveehouders, voor melkveehouders. Bij NMV staat het inkomen en verdienmodel van de leden centraal. NMV is lid van de European Milk Board (EMB). Samen met haar partners zet NMV zich in voor beleid dat moet zorgen voor ee n kostendekkende melkprijs. Ook is zij voorstander van crisisinstrument zoals het Markt Verantwoordelijkheids Programma. Naast zuivelbeleid behartigt NMV de belangen van haar leden in tal van onderwerpen
J.M.M. Jansen
Het Nederlandse Nationaal Comité (NNC) van de Internationale Zuivelbond (IDF) vertegenwoordigt de belangen van de Nederlandse zuivelsector in de Internationale Zuivelbond IDF. Bij de IDF zijn 46 landen aangesloten, die samen goed zijn voor 75% van de wereldmelkproductie. IDF vormt een netwerk van meer dan 1.000 zuivelexperts uit de hele wereld en biedt een platform voor het uitwisselen van ideeën en ervaringen. De organisatie vertegenwoordigt de
102 ZUIVEL IN ZICHT / 2022 BELANGENBEHARTIGING / NEDERLAND
wereldwijde zuivelsector en zorgt ervoor dat de beste wetenschappelijke kennis wordt gebruikt om het belang van hoge kwaliteit melk en voedzame, veilige en duurzaam geproduceerde producten wereldwijd te ondersteunen.
NNC-IDF vormt de locatie netwerkorganisatie van IDF en functioneert sinds medio 2017 als een themagroep onder de paraplu van ketenorganisatie ZuivelNL. In het netwerk van NNC-IDF participeren de belangrijkste stakeholders van de Nederlandse zuivelsector, zoals de Nederlandse Zuivelorganisatie, de LTO Vakgroep Melkveehouderij, NIZO Food Research, de GD, WUR (inclusief Dairy Campus), Qlip en het Nederlands Normalisatie Instituut NEN.
IDF richt zich op het bevorderen van zuivel gerelateerde kennis over een breed scala van onderwerpen, waaronder milieu en duurzame ontwikkeling, gezondheid en voeding, analysemethoden, diergezondheid en dierenwelzijn, zuivelwetenschap en -technologie, hygiëne en voedselveiligheid, zuivelbeleid en economie en marketing.
IDF is partner van vele mondiale organisaties die van belang zijn voor de zuivelsector, zoals de VN-voedsel en landbouworganisatie FAO, de wereld gezondheidsorganisatie WHO, de wereld organisatie voor diergezondheid (OIE), de Codex Alimentarius Commissie, de internationale orga nisatie voor standaardisering (ISO), de internatio nale federatie van agrarische producenten (IFAP) en de organisatie voor economische samenwer king en ontwikkeling (OESO).
IDF werkt ook nauw samen met het Global Dairy Platform – GDP, een samenwerkingsverband van een aantal toonaangevende zuivelondernemingen in de wereld.
NNKC - Stichting Nederlands Nationaal Kaaskeur Concours
Van Stolkweg 31, 2585 JN Den Haag 070-4131910 info@nnkc.nl www.nnkc.nl
Bestuur: Y. van Coillie, (voorzitter, Royal FrieslandCampina), T. van der Heiden (vice voorzitter, Van der Heiden Cheese Services), K. Hokse (Rouveen Kaasspecialiteiten), R. Krekels (Uniekaas Holland B.V.), R. Lekkerkerker (RL Food-strategy BV), J.N. van Mill (Visser Kaas)

Y.M.K. van Coillie
Het NNKC organiseert één van de grootste vakwedstrijden in Nederland en is uniek in de wereld van kaas. Het doel van de stichting is het bevorderen van de vakkennis met betrekking tot het volledige assortiment van in Nederland bereide soorten kaas. Centraal staat de vakkennis van de Nederlandse kaassector. Niet het product wordt gekeurd (wat normaliter het geval is); maar de persoon wordt gekeurd! De deelnemers (circa 500) doen jaarlijks mee aan de NNKCkaaskeuring.
De deelnemers krijgen tien kaasboorsels voorgezet waarvan de soort, de leeftijd, de smaak en de kwaliteit moeten worden omschreven. De winnaar ontvangt de Gouden
103 ZUIVEL IN ZICHT / 2022 BELANGENBEHARTIGING / NEDERLAND
Kaasboor, een belangrijke prijs in de Nederlandse kaaswereld. De Gouden Kaasboor wordt tijdens een feestelijk programma met optredens van artiesten en een uitgebreid kaasbuffet uitgereikt.
Gouda Cheese Awards

Van Stolkweg 31, 2585 JN Den Haag 070 4131910 info@nnkc.nl www.goudacheeseawards.nl
Gouda Cheese Awards is een belangrijke en bijzondere kaaswedstrijd in Nederland. Het is geen technische kaaskeuring, maar een neutrale smaaktest: consumenten proeven en beoordelen. Smaak bepaalt! De voorrondes worden gehouden met consumentenpanels van het Essensor. De spannende finale is live op mee te maken. Het decor vormt de traditionele Goudse Kaasmarkt, waar boeren en handelaren nog altijd met een ‘handjeklap’ onderhandelen over de prijs.
Deelname aan de Gouda Cheese Awards staat open voor alle Nederlandse kaasmerken. Producenten, handelsbedrijven en detailhandel: iedereen kan meedoen zolang de inzending voldoet aan het wedstrijdreglement.

NVC - Nederlandse IJsfabrikanten
Schenkkade 50 Postbus 96949, 2509 JH Den Haag 070-3365158
Bestuur: K. Vandamme (voorzitter)
De Nederlandse Vereniging van ConsumptieIJsfabrikanten houdt zich bezig met de collectieve belangenbehartiging voor de Nederlandse consumptie-ijsindustrie.
Leden
• Boermarke Desserts, Staalsteden 17, 7547 TA Enschede (053-4324802, fax 4328009)
• De IJsfabriek, Industriestraat 1, 7005 AN Doetinchem (0314-354425, fax 360229)
• Dessert Meesters, Bruninksweg 5a, 7554 RW Hengelo (088-374 9400)
• Holiday Ice BV, Slotweg 17, 8521 MA St.-Nicolaasga (0513-433000, fax 433001)
• IJspaleis BV, Rucphensebaan 48, 4174 RE Sprundel (0165-353535, fax 383536)
• La Venezia IJs B.V., Platinawerf 16, 6641 TL Beuningen (024-6782822, fax 6782838)
• Unilever Nederland Ice Cream and Frozen Food, Postbus 160, 3000 AD Rotterdam (010-4394911, fax 4394744)
• Unilever Nederland SU Ola, Postbus 13, 7447 ZG Hellendoorn (0548-659659, fax 659700)
• Otelli, R. Hofmanweg 65, 2031 BH Haarlem (023-5311113, fax 5325353)
104 ZUIVEL IN ZICHT / 2022 BELANGENBEHARTIGING / NEDERLAND
NVC - Nederlands Verpakkingscentrum

NVC ondersteunt het bedrijfsleven met een breed scala aan opleidingen, cursussen en workshops. De lessen worden gegeven in hybride vorm of Live Online vanuit de NVCopleidingsstudio in Gouda. Dus altijd en overal! NVC-leden ontvangen een aantrekkelijke korting.
Postbus 164, 2800 AD Gouda 0182-512411 info@nvc.nl www.nvc.nl

Contactpersoon: Ir.drs. M.W.C.M. Nieuwesteeg (directeur)
NVC-leden signaleren samen nieuwe ontwikkelingen en onderzoeken deze in innovatieprojecten. Zo inspireren ze elkaar en de gehele verpakkingswereld. Onderwerpen zijn: milieu, farma, e-commerce, print en Design for Intended Use.
NZO - Nederlandse Zuivel Organisatie
M.W.C.M. Nieuwesteeg
NVC (opgericht in 1953) is de vereniging van bedrijven die het belang erkennen van verpakken als activiteit binnen de gehele supply chain van verpakte producten. Het NVC lidmaatschap, de innovatieprojecten, informatiediensten en de opleidingen stimuleren het continu verbeteren van het verpakken.
De NVC-informatiediensten zijn in principe alleen toegankelijk voor NVC-leden, kosteloos als onderdeel van het lidmaatschap. Zo is de NVC Members-only Update (MOU) een unieke informatiedienst op maandbasis voor diegene die een professionele behoefte heeft aan een upto-date overzicht van de ontwikkelingen op het gebied van verpakken wereldwijd.
Benoordenhoutseweg 46 Postbus 93044, 2509 BC Den Haag 070-2191700 info@nzo.nl www.nzo.nl www.zuivelonline.nl
Bestuur: H.M.A. Schumacher (voorzitter), A.P. de Groot (vice-voorzitter), R.M. Noordermeer (penningmeester), J.P. Tanis en W.H. Maij
Directie: F.A.M. van den Heuvel
105 ZUIVEL IN ZICHT / 2022 BELANGENBEHARTIGING / NEDERLAND
F.A.M. van den Heuvel
De Nederlandse Zuivel Organisatie (NZO) is de branchevereniging van de Nederlandse zuivelindustrie. Zij behartigt de belangen van dertien zuivelondernemingen, die melk in Nederland tot een breed pakket zuivelproducten verwerken. Van zuiveldranken, baby- & kindervoeding, kaas en desserts tot ingrediënten voor de voedingsmiddelenindustrie en de farmaceutische sector. De NZO streeft naar een vitale zuivelsector die duurzaam produceert en die maatschappelijke waardering ontvangt. Zij faciliteert haar leden bij de verduurzaming van de keten en bewaakt de hoge kwaliteit van de Nederlandse zuivelproducten. Daarnaast benadrukt de NZO de voedingswaarde van zuivel en tracht zij de internationale marktpositie van haar leden te bevorderen.
Leden
• Arla Foods, Nijkerk
• Ausnutria B.V., Heerenveen
• Royal A-ware, Lopik
• Royal Bel Leerdammer b.v., Schoonrewoerd
• Coöperatieve Zuivelfabriek ‘Rouveen’ u.a., Rouveen
• Coöperatieve Zuivelonderneming CONO b.a., Westbeemster
• Drents-Overijsselse Coöperatie Kaas B.V. (DOC Kaas), Hoogeveen
• De Graafstroom B.V., Bleskensgraaf
• Hochwald Foods Nederland B.V., Bolsward
• Royal FrieslandCampina N.V., Amersfoort
• Vreugdenhil Groep B.V., Nijkerk
• Kaasmakerij Henri Willig BV, Heerenveen


• Yakult Europe B.V., Almere
Qlip
Zweedsestraat 1a Oostzeestraat 2a (laboratorium) Postbus 119, 7200 AC Zutphen 088-7547000
www.qlip.nl info@qlip.nl

Management: Jan Bobbink (directeur), Eric van Dam (manager sales), Louw Beerstra (manager routine laboratorium), Armand Hermans (manager QCM laboratorium), Sybrand Merton (manager audits, inspecties & certificering), Harrie van den Bijgaart (manager innovation & business development).
Qlip ondersteunt de internationale zuivelketen (melkveehouderij, zuivelindustrie en -handel en retail) ter versterking van vooraanstaande marktposities. Dit doen we door een toonaangevende, innovatieve, betrouwbare en betrokken partner te zijn in de TIC (Testing, Inspection & Certification) business. Onze kernactiviteiten zijn gericht op het gebied van voedselveiligheid, kwaliteit, samenstelling en verduurzaming. Van oudsher is Qlip actief
106 ZUIVEL IN ZICHT / 2022 BELANGENBEHARTIGING / NEDERLAND
Jan Bobbink
in de Nederlandse zuivelsector. Zowel op de boerderij, tijdens het transport van rauwe melk, de verwerking van melk in de fabriek, tot aan het zuiveleindproduct in de winkel. Zo analyseert Qlip jaarlijks in Zutphen ruim 13 miljoen monsters rauwe melk (koe & geit). Dit in opdracht van zuivelondernemingen en veeverbeteringsorganisaties. Daarnaast worden ruim 600.000 chemische en microbiologische analyses uitgevoerd op zuivelproducten, zoals kaas, boter, melkpoeder en zuigelingenvoeding. We hebben een breed portfolio met o.a. de analyse van contaminanten & residuen, microorganismen en aminozuren. Ook biedt Qlip een groot assortiment controlemonsters, kalibratiereeksen en rondzendonderzoeken aan en ondersteunen we zuivelondernemingen bij het onderhouden van specifieke kalibratielijnen, het instellen van meetinstrumenten en het trainen van medewerkers.
Verder voert Qlip jaarlijks ruim 15.000 audits en beoordelingen uit op het functioneren van kwaliteitssystemen in de melkveehouderij en zuivelsector. Ook richt het zich met KOM op het bewaken, en verbeteren van de kwaliteit van melkwinning en -bewaring op het melkveebedrijf. Dit wordt o.a. gedaan door borging van onderhoudsbeurten op de melkinstallaties, melkmeting en koelinstallaties. Tevens verzorgt het Milk Competence Center van Qlip de administratie van melkleveranties -kwaliteit en de melkgeldadministratie voor een groot aantal zuivelondernemingen, bekend als Z-net en Imilk. Ook de vele initiatieven van zuivelondernemingen en melkveehouders op het gebied van verduurzaming worden middels de verwerking van data door Z-net ondersteunt. Qlip voert steeds meer activiteiten uit buiten Nederland, met name in Noord-West Europa. Bactoforce International A/S is een
zusterorganisatie van Qlip. Dit inspectiebedrijf van Deense origine is Europees marktleider bij het inspecteren van processing equipment in de liquid food sector.
SIBK
-
Stichting Importeurs Buitenlandse Kaas
p/a Van Stolkweg 31 2585 Jn Den Haag 070 4131910 info@gemzu.nl www.sibk.nl Bestuur: J. Hoogenboom (voorzitter)

De SIBK is een initiatief van de Nederlandse kaashandel. Deze bedrijven importeren vanuit de hele Europese gemeenschap speciaal geselecteerde en gecontroleerde buitenlandse kazen naar Nederland. Belangrijk daarbij zijn de smaak van de kaas maar zeker ook de kwaliteit, waarbij authenticiteit hoog in het vaandel staat. Daaraan worden geen concessies gedaan.
Het SIBK behartigt de belangen van de aangesloten importeurs en zorgt voor de noodzakelijke afstemming tussen de Voedsel- en Warenautoriteiten, het COKZ en verschillende ministeries, zoals de Ministeries van EL&I en VWS. Daarnaast zorgt de SIBK op Europees niveau in Brussel voor de juiste afstemming inzake de kwaliteitsbewaking en voedselveiligheid.
107 ZUIVEL IN ZICHT / 2022 BELANGENBEHARTIGING / NEDERLAND
Dit alles met als doel de andere groothandelaren, de kaasspeciaalzaken en uiteindelijk natuurlijk de consument het best mogelijke product te kunnen aanbieden.
Stichting Nederlandse Zuivelbeurs
Van Stolkweg 31 2585 JN Den Haag 070 4131910
Bestuur: M.A.C. Bink-Verkleij (voorzitter), P. Bouter, K. Hokse
De Stichting Nederlandse Zuivelbeurs heeft de Algemene Handelsvoorwaarden voor de Handel in Kaas tevens Arbitragereglement opgesteld. Deze handelsvoorwaarden worden gebruikt in de relatie tussen de leden van de Zuivelbeurs onderling en in de relatie tussen de leden van de Zuivelbeurs en derden. Tevens is er het Arbitragereglement en -commissie waardoor geschillen tussen de bedrijven onderling kunnen worden beslecht. De handelsvoorwaarden worden gedeponeerd bij de Kamer van Koophandel en zijn beschikbaar in het Nederlands, Duits, Engels, Frans en Spaans.
De Unie in jouw belang
Multatulilaan 12 Postbus 400, 4100 AK Culemborg 0345-851851 www.unie.nl
Contactpersoon: Mandy Raaijmakers (belangenbehartiger) Werknemersorganisatie Vakcentrum
Blekerijlaan 1, 3447 GR Woerden 0348-419771 info@vakcentrum.nl www.vakcentrum.nl
Bestuur: Hans Koelemij (voorzitter), Harrie ten Have, Inge Overeem, Pieter Renkema, Edwin Schreff, Edwin Seggelink en Astrid Willems

108 ZUIVEL IN ZICHT / 2022 BELANGENBEHARTIGING / NEDERLAND
Foodspecialiteiten
Vee&Logistiek Nederland

Vee&Logistiek Nederland is dé brancheorganisatie van ondernemers in de veehandel en het veetransport, ondernemers met veeverzamelcentra, importeurs en exporteurs van levend vee. Onze kerntaak is belangenbehartiging.
Zo is Vee&Logistiek Nederland hét aanspreekpunt van de overheid, politiek, ketenpartners en maatschappij als het gaat om de veehandel en het veetransport.


Wij hebben vertegenwoordigers in vele commissies, werkgroepen en andere samenwerkingsverbanden. In Europees verband is Vee&Logistiek Nederland lid van de Europese Vee en Vleeshandelsunie (UECBV) in Brussel. We werken met erkenningsregelingen aan professionalisering en toekomstbestendigheid van de veelogistieke sector. Ook zorgt Vee&Logistiek Nederland voor informatievoorziening, ledenondersteuning en ledencontact.
Sinds 1 januari 2017 is Veepro Holland onderdeel van Vee&Logistiek Nederland. De promotie en bevordering van de export van Nederlandse genetica horen daarom ook bij onze hoofdactiviteiten.
109 ZUIVEL IN ZICHT / 2022 BELANGENBEHARTIGING / NEDERLAND
Manager speciaalzaken: Rick
Het Vakcentrum is
belangenbehartiger
partner van zelfstandige
in food,
fast moving consumer goods en franchisenemers.
Rick Brantenaar
Brantenaar
de onafhankelijke
en bewezen
detaillisten
non-food,
Benoordenhoutseweg 46-5 2596 BC Den Haag 070-2193000 info@vee-logistiek.nl www.vee-logistiek.nl Voorzitter: Helma Lodders Helma Lodders
Vereniging Automatisering Kaasgroothandel Van Stolkweg 31 2585 JN Den Haag 070 4131910 Bestuur: M.J. van der Heiden (voorzitter), J. van Amstel, P. van Binsbergen, H. Schep, J.K. van der Wind
De Vereniging Automatisering Kaasgroothandel (VAK) heeft in samenwerking met de ontwikkelaar Cervus Automatisering B.V. een computerprogramma met de naam Profin op maat ontwikkeld, speciaal voor de kaas- en zuivelgroothandel. De VAK, die de belangen van haar leden behartigt, speelt bij de verdere optimalisering van Profin een centrale rol. Profin is precies afgestemd op alle administratieve behoeften en wensen die een moderne kaas- en zuivelgroothandel heeft. De complete administratie wordt met een minimum aan handelingen geautomatiseerd. Profin kan vanuit een basis met modules worden uitgebreid. Zo zijn er de modules Oplegregistratie, Warehouse Management, Documentenstroom, Kostprijsberekening en Onderhoudsplanning. Er zijn onder andere een onderhoudsmodule en een productiemodule beschikbaar.
De verwerking van binnenkomende orders en uitgaande verzendberichten kan volledig geautomatiseerd plaatsvinden. Orders kunnen via EDI (Electronic Data Interchange) worden ontvangen en direct worden verwerkt in Profin. Verzendberichten kunnen automatisch worden verzonden. Op een in uw website opgenomen bestelsysteem kan uw afnemer zijn bestelling invoeren, waarna deze in Profin wordt ingelezen. Op basis van diverse praktijkervaringen is een speciale partijen- of batchregistratie ontwikkeld. Deze is geschikt voor de registratie van kaas met als kenmerk bedroging, maar natuurlijk ook inzetbaar voor andere artikelen. Zo kan worden geselecteerd op productiedatum, THT, aantal, gewicht of andere criteria.
Voor meer informatie: www.cervus.nl
VNFKD - Vereniging van Nederlandse Fabrikanten van Kinder- en Dieetvoedingsmiddelen

Schenkkade 50, etage 13 Postbus 96949, 2509 JH Den Haag 070-3365156 vnfkd@vnfkd.nl www.vnfkd.nl
Bestuur: C. Frenkel (algemeen secretaris), H. Sirag (Nutricia) (voorzitter), F. Verouden (Abbott) (penningmeester & vicevoorzitter), M. Heining (Fresenius Kabi), C. Lodder (FrieslandCampina), A. Pavone (Nestlé)
De Vereniging van Nederlandse Fabrikanten van Kinder- en Dieetvoedingsmiddelen (VNFKD) behartigt de gemeenschappelijke belangen van de bij haar aangesloten fabrikanten van kinder- en dieetvoedingsmiddelen. Het gaat hierbij om producten die specifiek zijn bedoeld voor zuigelingen en jonge kinderen (0-3 jaar) en om bijzondere producten voor volwassenen zoals medische voedingen, producten voor gewichtsbeheersing.
De vereniging is op nationaal niveau o.a. aangesloten bij de FNLI en VNO-NCW. Voorts is de VNFKD aangesloten bij de Europese
110 ZUIVEL IN ZICHT / 2022
BELANGENBEHARTIGING / NEDERLAND
brancheorganisatie Specialised Nutrition Europe (SNE) en bij de mondiale brancheorganisatie International Special Dietary Foods Industries (ISDI).
ZuivelNL
Benoordenhoutseweg 46
Postbus 93453, 2509 AL Den Haag info@zuivelnl.org www.zuivelnl.org
Bestuur
A. Schimmel (onafhankelijk voorzitter), H. Bakhuis (LTO), H. Bleker (NMV), K. Hokse (NZO), H. Maij (NZO) en E. Wunnekink (LTO)
Directie: H. Andela
H. Andela
Over ZuivelNL
ZuivelNL is de ketenorganisatie van de Nederlandse zuivelsector en is actief op terreinen waar samenwerking tussen de schakels in de zuivelketen tot meerwaarde leidt. Activiteiten zijn het financieren en initiëren van onderzoek & innovatie in de melkveehouderij en zuivelketen, het financieren en het faciliteren van de ontwikkeling en

het programmamanagement op het gebied van duurzaamheid en diergezondheid & dierenwelzijn. Voorbeelden hiervan zijn de Duurzame Zuivelketen, de KringloopWijzer en KoeMonitor. In het kader van voedselveiligheid financiert ZuivelNL het onderzoeksprogramma Gemeenschappelijk Research Zuivel. ZuivelNL publiceert marktinformatie over de (inter) nationale zuivelmarkt en de Nederlandse melkveehouderij en faciliteert de export van zuivelproducten. ZuivelNL heeft een educatieprogramma jongeren gericht op voedsel en de oorsprong daarvan. Daarnaast organiseert ZuivelNL het Nederlands Nationaal Comité van de Internationale Zuivelbond.
ZuivelNL werkt nauw samen met de ledenorganisaties LTO-melkveehouderij, Nederlandse Melkveehouders Vakbond (NMV) en de Nederlandse Zuivelorganisatie (NZO) en een aantal partnerorganisaties uit de agrarische sector. ZuivelNL wordt gefinancierd via een contributie die is gebaseerd op een inhouding per geproduceerde kilo melk van melkveehouders en de verwerkte kilo’s melk van zuivelondernemingen.
111 ZUIVEL IN ZICHT / 2022 BELANGENBEHARTIGING / NEDERLAND
BCZ Belgische Confederatie van de Zuivelindustrie
R. Debergh
Kolonel Begaultlaan 1A, bus 11 B-3012 Leuven 0032-16-300770 (fax 300779) office@bcz-cbl.be www.bcz-cbl.be

Bestuur: C. Gilain-Pycke, Inex (voorzitter), L. Ska, Laiterie des Ardennes (ondervoorzitter), J. Van De Broek, FrieslandCampina (ondervoorzitter), R. Debergh (afgevaardigd bestuurder).
Bestuurders: N. Van Dam (Milcobel), J. Van De Broek (FrieslandCampina), C. Gilain-Pycke (N.V.Inex), L. Ska (Laiterie des Ardennes), J. Berckmans (Danone), L. Locht (Corman), L. van Impe (Olympia N.V.), R. Debergh, G. Bogaerts (BMC), R. Van Ballegooijen (A-Ware), B. Buytaert (Lactalis Belgique), J.M. Cabay (Terre de Fromages)
Werkgroepen: Voedingsreglementering (secr. L. Callewaert), Zuivel en gezondheid (secr. L. Callewaert) Melkaanvoer (secr. E. Goyens)
De Belgische Confederatie van de Zuivelindustrie BCZ behartigt de economische en professionele belangen van de ondernemingen uit de Belgische zuivelnijverheid op regionaal, nationaal en in ternationaal vlak. Hiertoe kan zij onder meer vormingsactiviteiten organiseren voor, diensten verlenen en informatie verspreiden aan individu ele zuivelondernemingen. BCZ is voor wat betreft de belangenverdediging op Europees vlak lid van de European Dairy Association (EDA). Op wereldvlak is de BCZ via het Belgisch Comité F.I.L. lid van de Fédération Internationale de Laiterie.
Leden
• Agral R.A. - Courcelles
• Arla Foods Belgien - Welkenraedt
• Biomelk Vlaanderen C.V.B.A. – Westouter
• BMC - Zonhoven
• Butterei Pur Natur – Bullange
• Bullinger-St.-Vither Molkerei E.D. - Sankt Vith
• Eurofit S.A. - Luik
• Capra NV, Halen
• Castle Dairy - Welkenraedt
• Castle ingredients - Plombières
• Chimay Fromages - Baileux

• Coferme S.C. - Bailleux
• Corman N. S.A. - Goé
• Danone N.V. - Brussel
• Farmel Dairy België - NL Emmeloord
• FrieslandCampina Belgium N.V. - Aalter
• FrieslandCampina Professional Belgium N.V. –Lummen
• Fromagerie Bel S.A. – Nijvel
112 ZUIVEL IN ZICHT / 2022 BELANGENBEHARTIGING / BELGIË
• Group Loicq - Chevrardennes - Nivelles
• Terre de Fromages S.A- Herve
• Inex N.V. - Bavegem
• Fromunion-Kaasmakerij Passendale N.V. –Passendale
• A-ware La Concorde - Merchtem
• Lactalis Nestlé Produits Frais S.A. - Brussel
• Lactalis Noord Europa N.V. – Brussel
• Laiterie des Ardennes - Rendeux
• Luxlait – Mersch
• Mathot - Celles Houyet
• MIK – Pur Natur N.V. - Kruishoutem
• Milcobel C.V./B.A. – Kallo
• Mondelez Belgium N.V. - Halle
• Olympia N.V. – Herfelingen
• Savencia Fromage & Dairy Benelux - Brussel
• Socabel S.C. – Marche-en-Famenne
• Solarec - Recogne
• Schreiber Foods - Denee
• Vache Bleue S.A. – Lillois Witterzee

• NV LACTIS Pur Natur, Sint-Pieters-Leeuw
• Walhorn A.G./S.A. – Walhorn
• Yakult Belgium N.V. – Brussel
leden te verdedigen en te bevorderen en dit door studie, vertegenwoordiging, informatie en organisatie. Dit gebeurt hoofdzakelijk via frequente contacten met de Europese organisatie Eucolait.
Belgische Senaat
Leuvenseweg 11, 1009 Brussel www.senaat.be 0032-2-5017070
BioForum vzw
Regine Beerplein1, bus E305, 2018 Antwerpen 0032-3-2869278 info@bioforum.be www.bioforum.be
Contactpersonen: Lieve Vercauteren (directeur, Lieve.vercauteren@bioforum.be), Alexander Claeys (voorzitter, alexander.claeys@bioforum.be)
BioForum vzw is de sectororganisatie van

113 ZUIVEL IN ZICHT / 2022 BELANGENBEHARTIGING / BELGIË
BDF Belgian Dairytrade Federation B.D.F. Belgian Trade Federation C/O Nutricima Industrieterrein Hoogveld 89 9200 Dendermonde 0032-32-986802 YVerberght@glanbia.ie Bestuur: Y. Verbergt (secretaris)
van de Belgische Zuivelhandel
heeft tot doel de algemene, economische en handelsbelangen
de
De Beroepsvereniging
BDF
van
Lieve Vercauteren Alexander Claeys
de biologische landbouw en voeding in Vlaanderen. Haar leden zijn producenten, verwerkers, verkopers van biologische producten en verenigingen die actief zijn in de biologische landbouw en voeding.
BioForum beheert het keurmerk Biogarantie (Belgium) voor Vlaanderen.
BioForum heeft als doel het stimuleren van alle activiteiten die bijdragen aan de ontwikkeling van de biologische sector op alle mogelijke vlakken, zoals teelt, verwerking, handel, istributie enverbruik. Zij volgt wetgeving op Vlaams, nationaal en Europees vlak, telt lobbydossiers op voor diverse beleidsdepartementen.
Daarnaast is er een sterke communicatiepoot uitgebouwd, zowel naar de biologische sector als naar consumenten
Boerenbond
Diestsevest 40, 3000 Leuven 0032-16286000, www.boerenbond.be info@boerenbond.be

Hoofdbestuur: Lode Ceyssens (voorzitter), Eric Van Meervenne (ondervoorzitter), Frans De Wachter (algemeen secretaris), E.H. Jos Daems (algemeen proost), Pieter Verhelst (lid Hoofdbestuur), Guy Vandepoel (lid Hoofdbestuur), Nik Van Gool (voorzitter Ferm), Bram Van Hecke (voorzitter Groene Kring)
Namens de provincies: Bert De Keyser (Antwerpen), Johan Hillen (Limburg), Lut D’Hondt (Oost-Vlaanderen), Joris Claeys (VlaamsBrabant), Joris Vande Vyvere (West-Vlaanderen), Roger Croë (Oost-België).
Vertegenwoordiger namens Ferm: Liesbet Berger. Namens Groene Kring: Maarten Moermans Namens Landelijke Gilden: Luc Florus Vertegenwoordigers van de sectorvakgroepen: Mathieu Vrancken (akkerbouw), Christ Wolfcarius (fruitteelt), Geert Van Hulle (groenteteelt), Eric Van Meervenne (pluim- en kleinvee), Filip Goossens (sierteelt), Rik Bogaert (varkens), Michiel Deroo (vleesvee en kalveren), François Achten (melkvee) Sectorvakgroep Melkvee: Dirk Van de Keere (voorzitter), Roel Vaes (secretaris)
Boerenbond is de grootste Vlaamse landbouwor ganisatie. De organisatie behartigt de belangen van alle land- en tuinbouwers, zorgt voor vor ming en doet aan (individuele) dienstverleningen. 240 medewerkers in de hoofdzetel in Leuven, in de 5 Vlaamse provincies en in Oost-België ondersteunen de werking. De organisatie wordt bestuurd door het Hoofdbestuur waarin verte genwoordigers van alle sectoren en alle provin cies zetelen. Voor elke sector is er een sector vakgroep. Zo is er dus ook een sectorvakgroep Melkvee. Deze sectorvakgroep is samengesteld uit vertegenwoordigers van de provinciale vak groepen wat zorgt voor een democratisch en evenwichtige standpuntinname, typerend voor de Boerenbondwerking.
114 ZUIVEL IN ZICHT / 2022 BELANGENBEHARTIGING / BELGIË
DGZ (Dierengezondheidszorg Vlaanderen) vzw
Maatschappelijke zetel: Hagenbroeksesteenweg 167, 2500 Lier Administratieve zetel: Industrielaan 29, 8820 Torhout 0032-78-050523 info@dgz.be www.dgz.be Voorzitter raad van bestuur: Marcel Heylen (melkveehouder) Directeur: Benedikt Sas Manager informatiebeheer: Veerle Ryckaert Manager labo: Thalia Vanblaere Manager dienstverlening: Evelyne De Graef
DGZ is dé betrouwbare partner van de Vlaamse veehouder en fungeert als brugfunctie tussen de veehouder, zijn dierenarts en de overheid. Dit doet ze door het partnerschap tussen de veehouder en zijn dierenarts te ondersteunen en blijvend te investeren in medewerkers en innovatie. Samen met de veehouders en hun dierenartsen streeft DGZ er dagelijks naar om, met gezonde dieren én goede economische resultaten, de consument gezond en veilig voedsel te kunnen bezorgen. Het DGZ-team bestaat uit tal van specialisten zoals dierenartsen, ingenieurs, informatici, laboranten en administratieve krachten. Zij voeren onderzoek uit, ontwikkelen diergezondheidsprogramma’s en begeleiden veehouders en dierenartsen bij
de monitoring, bestrijding en preventie van dierziekten. Op haar site in Torhout voert DGZ jaarlijks ruim 1,3 miljoen laboratoriumonderzoeken en bijna 10.000 autopsies uit in het kader van dierengezondheidszorg. Om dit alles goed te kunnen realiseren, is een degelijke identificatie en registratie van bedrijf en dieren een must. Ook daar ondersteunt DGZ de veehouder bij. Met dit alles helpt DGZ de veehouder én de keten om een dier en zijn producten te volgen van bij de productie en de verwerking tot de distributie. Zo vormt DGZ een onmisbare schakel in een voedselproductie die niet alleen van een uiterst hoge kwaliteit is maar ook transparant en betrouwbaar.
IKM-Vlaanderen vzw
Hagenbroeksesteenweg 167, 2500 Lier 0032-78-154710 ikm@ikm.be www.ikm.be www.mcc-vlaanderen.be/nl/ikm
Voorzitter raad van bestuur: Rianne Covens-Van Tilburg (melkveehoudster) Contactpersoon: Veerle Ryckaert
IKM-Vlaanderen (kortweg IKM) voorziet in een extern kwaliteitsbewakingssysteem van gras tot glas. Daardoor wordt de volledige keten geresponsabiliseerd met tal van regels voor de verschillende schakels. Hierbij gaat het
115 ZUIVEL IN ZICHT / 2022 BELANGENBEHARTIGING / BELGIË
vooral om een bundeling van reeds bestaande en te respecteren wettelijke bepalingen die aangevuld zijn met een aantal codes van goede praktijk. IKM wordt trapsgewijs een referentienorm in de zuivelsector. Het IKM-systeem is door de Vlaamse overheid erkend als voedselkwaliteitsbepaling in het kader van de Europese regelgeving voor plattelandsontwikkeling. Momenteel wordt meer dan 99% van de melk geproduceerd op melkveebedrijven met een IKM-certificaat. Het IKM-lastenboek is door BELAC geaccrediteerd volgens ISO 17065 en is door de Vlaamse overheid erkend als centrum voor duurzame landbouw. Het IKM-secretariaat is geïntegreerd in de structuur van MCC-Vlaanderen.
ILVO-T&V Instituut voor Landbouw-, Visserijen Voedingsonderzoek
Eenheid Technologie en Voeding Brusselsesteenweg 370, 9090 Melle 0032-9-2723000 (fax 3001)
Burgemeester van Gansberghelaan 115, 9820 Merelbeke 0032--9-27228000 (fax 2801)




Lieve.Herman@ilvo.vlaanderen.be www.ilvo.vlaanderen.be www.foodpilot.be
Leiding: dr. Lieve Herman (afdelingshoofd), dr. Marc Heyndrickx (wetenschappelijk directeur Voedselveiligheid), dr. Marc De Loose (wetenschappelijk directeur Productkwaliteiten innovatie), dr. Jürgen Vangeyte (wetenschappelijk directeur Agrotechniek)
In het kader van de verwerking van primaire grondstoffen uit de landbouw en visserij bestrijkt de eenheid Technologie en Voeding een breed gamma aan onderwerpen die zich situeren op het vlak van voedselveiligheid, productkwaliteit en –innovatie, machineontwikkeling en sensortechniek. Dit betreft toegepast basisen dienstverlenend onderzoek dat zowel beleidsondersteunend is, als ten dienste staat van de landbouw en de verwerkende industrie, met bijzondere aandacht voor de agrovoedingsindustrie.
ILVO-T&V beschikt over Belac geaccrediteerde laboratoria zowel voor het uitvoeren van analyses als voor het organiseren van ringonderzoeken.
ILVO T&V biedt vanuit de Food Pilot een totaal dienstverleningspakket op maat van de voedingsindustrie. De infrastructuur omhelst zowel pilootinfrastructuur voor food processing als laboratoria. Product- en procesontwikkeling wordt gesteund door analyses voor geur en smaak, analyse van bioactieve componenten, houdbaarheidsonderzoek (microbiologisch en fysico-chemisch), advies omtrent reiniging en desinfectie, urgentieservice bij contaminatie-problematieken en advies omtrent problemen met analyses of twijfels over de analyseresultaten.
Daarnaast richt het onderzoek zich naar de ontwikkeling van analytische technieken (omtrent bederforganismen, pathogenen, residuen van diergeneesmiddelen, GGO’s, allergenen en de evaluatie en ontwikkeling van sneltesten), sensor-
116 ZUIVEL IN ZICHT / 2022 BELANGENBEHARTIGING / BELGIË
Lieve Herman Marc Heyndrickx Jürgen Vangeyte Marc De Loose
en prototype machineontwikkeling en een uitgebreide referentiewerking via het organiseren van ringonderzoeken, adviesverlening en het uitvoeren van analyses in geval van betwisting of twijfel van resultaten.
Tot slot beschikt ILVO-T&V over een proefmelkinstallatie voor de uitvoering van melktechnisch onderzoek. De adviesdienst voor de zuivelsector biedt meer specifiek technische ondersteuning bij hoevezuivelproductie, melkwinningsapparatuur, huisvesting van dieren en landbouwmachines.
Melkcontrolecentrum Vlaanderen (kortweg MCC) is dé betrouwbare partner van de Vlaamse melkveehouder en de zuivelsector. MCC waarborgt de kwaliteit en de samenstelling van alle rauwe melk die in Vlaanderen geproduceerd en aan de zuivelindustrie geleverd wordt. Daarbij houdt ze toezicht op de bemonstering, voert ze hoogkwalitatieve analysen uit op de monsters die ze ophaalt bij de producenten en zorgt ze voor zowel de gegevensverwerking als de rapportering. Daarnaast ondersteunt MCC de connectie tussen de Vlaamse melkveehouders en de kopers van melk. Zo zorgt de buitendienst van MCC voor de begeleiding van de Vlaamse melkveehouders, in samenspraak met de andere betrokken partners (zuivelindustrie, landbouworganisaties...).

MCC investeert continu in haar medewerkers, in kennis en innovatie. Jaarlijks voert MCC ruim 12 miljoen analyses uit op melkmonsters in haar gespecialiseerd laboratorium in Lier. Door deze snelle en efficiënte aanpak garandeert MCC de kwaliteit van de zuivel die uiteindelijk in de winkelrekken komt. Het labo van MCC is door BELAC geaccrediteerd volgens ISO 17025, de norm voor kwaliteitsmanagement in laboratoria, en ISO 17020, de norm voor controleactiviteiten in de distributiesector. Bovendien is MCC ook gecertificeerd volgens ISO 17065, voor de certificatie van het IKM-lastenboek en van weidegang en kan ze binnen de sector worden ingeschakeld voor andere certificatie-initiatieven. Zo zorgt MCC er mee voor dat de Vlaamse zuivel bij de meest kwalitatieve ter wereld behoort.
Veerle Ryckaert Manager labo: Thalia Vanblaere Manager dienstverlening: Evelyne De Graef
117 ZUIVEL IN ZICHT / 2022 BELANGENBEHARTIGING / BELGIË
MCC (Melkcontrolecentrum Vlaanderen) VZW Hagenbroeksesteenweg 167, 2500 Lier 0032-78-154710 info@mcc-vlaanderen.be www.mcc-vlaanderen.be Voorzitter raad van bestuur: François Achten (melkveehouder) Contactpersonen: Veerle Ryckaert (zuivel en melkveehouderij) en Thalia Vanblaere (labo) Directeur: Benedikt Sas Manager informatiebeheer:
MilkBE
Kolonel Begaultlaan 1A bus 11 3012 Leuven 0032 16 30 07 70
office@milkbe.org
Bestuur: Dirk Van De Keere (voorzitter), Renaat Debergh (ondervoorzitter), Marc Decoster (on dervoorzitter), Michèle Lambrechts, André Ledur, Koen Lowagie, Roel Vaes, Hendrik Van den Haute, Paul Vanhengel en Ingeborg Van Wonterghem
Contactpersoon: Astrid Vangerven

MilkBE is de brancheorganisatie voor de Belgische zuivelsector. MilkBE vertegenwoordigt de melkveehouders en de zuivelindustrie. MilkBE is actief op het vlak van kwaliteit en samenstel ling van de melk, voedselveiligheid, duurzaam heid in de keten en relaties tussen de producen ten en de zuivelindustrie. MilkBE is beheerder van het lastenboek IKM en het solidariteitsfonds voor botulisme. Verder bevordert MilkBE het goe de imago van de ganse zuivelketen.

Ministerie van Landbouw en Landelijke Aangelegenheden, Waals

Minister Benoît Lutgen Chaussée de Louvain 2, 5000 Namen 0032-81-710310 (fax 710380)
Cabinet.lutgen@gov.wallonie.be
Kamer van volkvertegenwoordigers
Leuvenseweg 13, 1008 Brussel 0032-2-5498111 www.dekamer.be PRI@dekamer.be
Commissie bedrijfsleven, wetenschapsbeleid, on derwijs, nationale wetenschappelijke instellingen, middenstand en landbouw.
Overheid, Vlaamse
Departement Landbouw en Visserij Koning Albert II-laan 35 bus 40, 1030 Brussel 0032 2 552 77 72 www.vlaanderen.be/landbouw
Contactpersoon: Marian Debonne, 0032 2 552 77 72
118 ZUIVEL IN ZICHT / 2022 BELANGENBEHARTIGING / BELGIË
Dirk Van De Keere Astrid Vangerven
Parlement, Vlaams
Leuvenseweg 86 Vlaams Parlement, 1011 Brussel 0032-2-5521111 www.vlaamsparlement.be Commissie voor Landbouw, Visserij en Plattelandsbeleid
Contact: Marthe Van Den Abbeele, marthe.vandenabbeele@vlaamsparlement.be
TÜV NORD Integra
Daarnaast biedt TÜV NORD Integra bvba certificatie aan voor de biologische productie, verwerking en verkoop alsook certificatie van een aantal sociale en duurzame standaarden zoals RSPO, Rainforest Alliance, Fairtrade, V-Label en Visserij Verduurzaamt.
TÜV NORD Integra bvba is ook actief in de certificatie in de primaire productie, zoals GlobalG.A.P, Vegaplan, GRASP en Tesco NURTURE.
TÜV NORD Integra bvba is geaccrediteerd door BELAC in het kader van de internationale normen ISO 17020, ISO 17021 en ISO 17065.


Certificatie in landbouw en voeding
Statiestraat 164, 2600 Berchem-Antwerpen 0032-3-2873760 (fax 2873761) info@tuv-nord-integra.com www.tuv-nord-integra.com
Contactpersoon: Guy Buysse (zaakvoerder)
TÜV NORD Integra is een certificatie-organisatie voor landbouw en voeding actief in België en een groot aantal andere Europese en nietEuropese landen. TÜV NORD Integra bvba is het kenniscentrum voor landbouw- en voedingscertificatie binnen de Duitse TÜV NORD groep. TÜV NORD Integra bvba biedt een gamma certificatiesystemen mbt voedselveiligheid zoals BRC, IFS, STNO, VLOG, ISO 22000, FSSC 22000, QS, FCA en autocontrole.
119 ZUIVEL IN ZICHT / 2022 BELANGENBEHARTIGING / BELGIË
Vlaams Centrum voor Agro- en Visserijmarketing VLAM Vlaams Centrum voor Agro-
Visserijmarketing Koning Albert II laan 35, bus 50, 1030 Brussel 0032-2-5528003
5528015) frederik.vandermersch@vlam.be www.vlam.be Instagram: melkmoment Facebook
melkmoment
VLAM
en
(fax
:
www.kazenvanbijons.be www.melk4kids.be Verantwoordelijke zuivelpromotie: Frederik Vandermersch (promotiemanager Zuivel)
VLAM, het Vlaams Centrum voor Agro- en Visserijmarketing, voert promotie voor de producten van de Vlaamse landbouw, tuinbouw en visserij in binnen- en buitenland. VLAM is een privaatrechtelijke organisatie met als opdrachtgever de Vlaamse overheid en werkt in nauw overleg met het bedrijfsleven. De promotie gebeurt grotendeels per product of product-groep. Daarnaast communiceert VLAM ook onder het overkoepelende ‘Lekker van bij ons’-concept. Het merendeel van het budget wordt via decretale heffingen opgebracht door diverse ondernemers in land- en tuinbouw. Voor zuivel brengen de Vlaamse melkveehouders samen een programma uit ten belope van 4 mio euro. Voor bepaalde projecten wordt ook gebruik gemaakt van de hefboomsystemen die er zijn om EU-middelen in te zetten.
Campagnes worden uitgerold ten gunste van consumptiemelk en kaas. Daarnaast wordt ook ingezet op educatie, communicatie op het vlak van duurzaamheid en dierenwelzijn. Verspreiding van voedingsinformatie is ook een belangrijk thema. En vermits de helft van de productie geëxporteerd wordt, zijn er ook een aantal exportactiviteiten. Middelen voor onderzoek en PR zijn ook speerpunten van de acties.
Assifonte
22 – 28, avenue d’Auderghem, 1040 Brussel, België +32 2 549 50 41 aanton@euromilk.org
Contactpersoon: Alexander Anton (secretaris)
Europese organisatie van smeltkaasproducenten
Aangeslotenen
België
St Paul NV
Lid: Dieter Kuijl Industriepark Rozen Weverslaan 20 9160 Lokeren +32 9 3488119 d.kuijl@st-paul.be www.st-paul.be
Denemarken
Danish Dairy Board Rue de Luxembourg 47-51 1050 Brussel België +32 2 2302705 ddb@agridan.be
Danish Agriculture & Food Council
Danish Dairy Board Agro Food Park 13 8200 Aarhus +45 87312000 ddb@mejeri.dk www.mejeri.dk
120 ZUIVEL IN ZICHT / 2022 BELANGENBEHARTIGING / EUROPA
Duitsland
Jermi Käsewerk GmbH
Lid: Gerhard Jerg Ritter-Heinrich-Strasse 2-4 88471 Laupheim-Baustetten +49 7392 9771-102 jerg@jermi.de Schreiber Foods Europe GmbH
Lid: Christof Kessler Im Unteren Feld 18 88239 Wangen +49 7522 9166-520 christof.kessler@schreiberfoods.com
Frankrijk
SAVENCIA
Lid: Emmanuel Treuil Edelweis Käseerke D-87435 Kempen +33 1 34 586791 emmanuel.treuil@alliance.com
Bel-Group
Lid: Virginie Rivas 2, allée de Longchamp 92150 Suresnes +33 1 84027834 vrivas@groupe-bel.com
Nederland
BeNeLuxSmelt - Association of the Processed Cheese Manufacturers
Lid: Van Stolkpark 31 NL-2585 JN The Hague +31 70 4131910
Noorwegen
TINE SA
Lid: Helle Huseby Postboks 4242 Sluppen 7436 Trondheim +47 9703 1731 helle.huseby@tine.no
Oostenrijk
Österreichische Schmelzkäseindustrie
Lid: Ludwig Rupp Krüzastrasse 8 6912 Hörbranz +43 5574 4973-0 E-mail: ludwig.rupp@rupp.at
Verband der Schmelzkäseindustrie Zaunergasse 1-3 1030 Wien +43 1 712212127
Tsjechië çeskomoravský svaz mlékárenský
Lid: Dr. Jiri Kopácek V Olsìnách 75, 100 00 Praha 10 0042-602-271315 www.cmsm.cz
121 ZUIVEL IN ZICHT / 2022 BELANGENBEHARTIGING / EUROPA
EDA European Dairy Association

Avenue d’Áuderghem 22-2B, B-1040 Brussel 0032-2-5495040 eda@euromilk.org
Bestuur: Michel Nalet (voorzitter), Alexander Anton (secretaris)

Commissies
Trade & Economics: Mrs. Lise Andreasen Høyer (DDB) and Mr. Béranger Guyonnet (Sodiaal) (voorzitters)
Food & Environment Policies Committee: Mr. J. Hald Christensen (voorzitter, DDB)
De European Dairy Association behartigt de belangen van de Europese zuivelindustrie bij de autoriteiten van de Europese Unie. Bij de organisatie zijn de nationale zuivelorganisaties van de EU-landen
aangesloten. Het bestuur van de associatie bestaat uit een vertegenwoordiger van iedere lidstaat.
Leden
België
BCZ-CBL, Belgische Confederatie van de Zuivelindustrie
Kolonel Begaultlaan 1a, bus 11 B-3032 Leuven www.bcz-cbl.be
Bestuurslid: Mr. Renaat Debergh (BCZ)
Denemarken
Mejerieforeningen Danish Dairy Board Agrofood Park 13 DK-8200 Aarhus N www.mejeri.dk Danish Dairy Board (Brussels) Rue du Luxembourg 47-51 B-1050 Brussels Bestuurslid: Peter Giortz-Carlsen
Duitsland
MIV (Milchindustrie-Verband) Jägerstraße 51 D-10117 Berlin www.milchindustrie.de DRV (Deutscher Raiffeisenverband) Postfach 080549 D-10005 Berlin www.raiffeisen.de
Bestuurslid: Mr. I. Müller
Estland
Estonian Dairy Association, Eesti Piimaliit J. Vilmsi 53 EE-10147 Tallinn www.piimaliit.ee
Bestuurslid: Mr Maido Solovjov (Valio Estonia)
122 ZUIVEL IN ZICHT / 2022 BELANGENBEHARTIGING / EUROPA
Alexander Anton
Finland
Finnish Milk Processors and Dairy Products Wholesalers
Meijeritie 6, P.O. Box 10 FI-00039 Valio
Bestuurslid: Mrs. Riitta Brandt (Valio)
Finnish Food & Drink Industries Federation P.O. Box 115 Pasilankatu 2 FI 00241 Helsinki www.etl.fi
Frankrijk
ATLA Maison du Lait 42, rue de Châteaudun F-75314 Paris Cédex 9 www.atla.asso.fr
Bestuurslid: Mr. F. Chausson
Georgië Dairy Georgia 15, Agladze Str. GE-Tbilisi Georgia, 0154 www.dairygeorgia.ge
Griekenland
SEVGAP, Hellenic Association of Milk and Dairy Products Industry Kifissias Av. 340 GR-15451 Neo Psychiko-Atens
Bestuurslid: Mr. Christos Apostolopoulos
Ierland
DII - Dairy Industry Ireland Confederation House 84-86 Lower Baggot Street IRL-Dublin 3 www.ibec.ie
Bestuurslid: Mr Conor Mulvihill
Italië ASSOLATTE Via Adige 20 IT-20135 Milano www.assolatte.it Bestuurslid: Vittorio Fiore (Lactalis)
Kroatië Association of Croatian Purchasers & Processors of Milk, CroMilk Zadarska 80/V Zagreb www.cromilk.hr Bestuurslid: Mr Janda Dalibor
Luxemburg A.L.L. Luxemburg Dairy Association 7, Rue Alcide de Gasperi, BP 1304 L-1013 Luxemburg info@luxlait.lu
Bestuurslid: Mr Gilles Gerard
Nederland NZO, Nederlandse Zuivel Organisatie Benoordenhoutseweg 46 NL-2596 BC Den Haag www.nzo.nl
Bestuurslid: Albert de Groot (Vreugdenhil)
Oostenrijk VÖM, Vereinigung Österreichischer Milchverarbeiter F. Wilhelm-Raiffeisen-Platz 1 A-1020 Wien www.voem.or.at
Bestuurslid: Mr. Helmut Petschar (Kärntnermilch)
123 ZUIVEL IN ZICHT / 2022 BELANGENBEHARTIGING / EUROPA
Polen
ZPPM (Association of Private Dairy Processors) ul. Zlota 59, budynek Lumen, pietro 6 PL-00-613 Warszawa www.zppm.pl
Bestuurslid: Mr Jaroslaw Kowalik
KZSM (National Union of Dairy Co-operatives) ul. Hoza 66/68 PL-00-682 Warszawa www.kzsm.org.pl
KSM (Dairy Technology Diploma Holders Association) ul. Hoza 66/68 PL-00-682 Warszawa www.mlekoland.com
PIM (Polish Chamber of Milk) Ul. Mickiewicza 7/23 PL-15-213 Bialystok www.izbamleka.pl
Portugal
ANIL, Associaçào Nacional dos Industriais de Lacticinios
Rua de Santa Teresa 2-C2 P-4050 Porto www.anilact.pt
FENALAC (Federação Nacional das Cooperativas de Produtores de Leite) Rua Alexandre Herculano 351 - 1e andar P - 4000-055 Porto www.fenalac.pt
Bestuurslid: Mr Rui Batista
Slowakije
Slovensky mliekarensk zväz (SMZ) Záhradnicka 21 SK 811 07 Bratislava Bestuurslid: Mr Peter Novorolnik
Slovenië Chamber of Commerce and Industry of Slovenia Chamber of Agricultural and Food Enterprises (GZS - Zbornica kmetijskih in živilskih podjetij) Dimiceva 13 SI - 1000 Ljubljana www.gzs.si/zkzp Bestuurslid: Mr. Tomaz Znidaric
Spanje
FENIL - Federación Nacional de Industrias Lacteas Ayala 10 – 1 Izqda E-28001 Madrid www.fenil.org Bestuurslid: Mr. Antoni Bandres (Danone) Tsjechië Czech & Moravian Dairy Association V Olsinách 75 CZ 100 00 Praha 10 Bestuurslid: Mr Jan Teply Potravinárská Ceské republiky Pocernická 96/272 CZ-10803 Praha 10 Malesice
Verenigd Koninkrijk Dairy UK 210 High Holborn UK - London WC1V 7EP www.dairyUk.org Bestuurslid: Ms Judith Bryans Zweden Federation of Swedish Farmers Franzéngatan 6 SE-10533 Stockholm www.lrf.se
124 ZUIVEL IN ZICHT / 2022 BELANGENBEHARTIGING / EUROPA
EMB European Milk Board

Rue de la Loi 155, 1040 Brussel 0032-2808-1935 (Fax 8265) www.europeanmilkboard.org office@europeanmilkboard.org
Directie: Silvia Däberitz (directeur)
De EMB is een overkoepelende organisatie van melkveehoudersvakbonden en -lobbyorganisa ties. Organisaties uit 16 landen hebben zich ge bundeld. Bovendien is er veel samenwerking met andere Europese landen.
Leden
België
• MIG (Milchzeuger Intessengemeinschaft) www.milcherzeuger.eu
• FMB (Flemish Milk Board)
Denemarken
• LDM (Landsforeningen af Danske Mælkeproducenter) www.maelkeproducenter.dk
Duitsland
• AbL (Arbeitsgemeinschaft bäuerliche Landwirtschaft) www.abl-ev.de
• BDM (Bundesverband deutscher Milchviehhalter) www.bdm-verband.de
Frankrijk
• CR (Coordination Rurale) www.producteurs-lait.com
• APLI (Association des Producteurs de lait indé pendants) www.apli-nationale.org
Ierland
• IMCSA (Irish Creamery Milk Suppliers Association) www.icmsa.ie
Italië
• APL (Associazione Produttori Latte della Pianura Padana) www.aplpianurapadana.it
Kroatië
• HSUPM (Hrvatski Savez Udruga Proizvodaca Mlijeka)
Letland
• LOSP (Lauksaimnieku organizaciju sadarbibas padome) www.losp.lv
Litouwen:
• LPGA (Lietuvos pieno gamintoju asociacijos) www.pienogamintojai.lt
Luxemburg
• LDB (Luxembourg Dairy Board) www.idb.lu
Nederland
• DDB (Dutch Dairymen Board) www.ddb.nu
• NMV (Nederlandse Melkveehouders Vakbond) www.nmv.nu
Noorwegen
• Bondesolidaritet www.bondesolidaritet.no
125 ZUIVEL IN ZICHT / 2022 BELANGENBEHARTIGING / EUROPA
• Portugal
Aprolep www.aprolep.pt
Spanje
• OPL (Organización de Productores de Leche) www.opleche.com
Zweden
• Sveriges Mjölkbönder www.sverigesmjolkbonder.se
Zwitserland
• BIG-M (Bäuerliche Interessengruppe für Preis und Marktkampf) www.faire-milch.ch
• Uniterre www.uniterre.ch
Eucolait
Belliardstraat 199, 1040 Brussel 0032-2-2374372 www.eucolait.eu

European Association of Dairy Trade Bestuur: F. van Stipdonk (voorzitter), J. Likitalo (secretaris)
Leden
België
Belgian Dairy Trade Federation (BDF) Hoogveld 89 9200 Dendermonde
Duitsland
Bundesverband Molkereiprodukte e.v. (BUMO) Jägerstrasse 51 10117 Berlin www.mopro.de Export Union Jägerstrasse 51 10117 Berlin www.export-union.de
Estland
Estonian Chamber of Agriculture & Commerce (ECAC) Pärnu mnt 141 11314 Tallinn www.epkk.ee
Finland VALIO LTD R1D Meijeritie 4 P.O. Box 30 00039 Valio - Helsinki www.valio.com
Frankrijk
FEDALIS Avenue du Viaduc 3 Fruileg CP 90761 94594 Rungis Cedex
FEDALIS Export Group Avenue du Viaduc 3 Fruileg CP 90761 94594 Rungis Cedex
Ierland Ornua Grattan House Lower Mount Street Dublin 2 www.ornua.com
126 ZUIVEL IN ZICHT / 2022 BELANGENBEHARTIGING / EUROPA
Italië
Assocaseari
Via Beltrami 16 26100 Cremona www.assocaseari.it
Litouwen
Lithanian Organisation of Dairy Exporters
Kirtimu str. 49 02244 Vilnius
Nederland
Gemzu - Secretariat of the Dutch Dairy Trade Association
Van Stolkweg 31 2585 JN Den Haag www.gemzu.nl
Oostenrijk
Vereinigung Österreichischer Milchverarbeiter (VÖM)
Friedrich-Wilhelm-Raiffeisen-Platz 1/9 St. 1020 Wien www.voem.or.at
Polen
Zwiazek Pracodawcow Eksporterow i Importerow Produktow Mleczarskich ul. Sobieszynska 9 00764 Warsaw www.zpeipm.eu
Tjechië
Czech Dairy Trade Association (CDTA) Nad Palatou 32 15000 Prague 5
Verenigd Koninkrijk
Provision Trade Federation (PTF)
Clerkenwell Green 17 EC1R 0DP London www.provtrade.co.uk
EuroCommerce

Avenue des Nerviens 85, 1040 Brussels 0032-2-7370598 (fax 2300078) www.eurocommerce.eu
Bestuur: Régis Degelcke (voorzitter) Directie: Christian Verschueren (directeur generaal, 0032-2-7370591, guedes@eurocommerce.eu
Europese organisatie van retail en distributieorganisaties.
Leden van EuroCommerce zijn nationale organisaties in detailhandel, groothandel en internationale handel in de EU en daarbuiten. Onder de geassocieerde leden zijn brancheorganisaties en individuele bedrijven.
Euroglaces
European Ice Cream Association vzw Rue de la Science 14 1040 Brussel
Bestuur: Carl Fjeldberg (voorzitter), Myriam Goffings (secretaries)
Europese organisatie van ijsproducenten
127 ZUIVEL IN ZICHT / 2022 BELANGENBEHARTIGING / EUROPA
Aangeslotenen
België
FebelGlaces vzw Rue de la Science 14 B - 1040 Bruxelles 0032-2-2138478 www.belgianicecream.be
Bulgarije
Froneri Bulgaria SA 261, Lomsko Shosse blvd. BG - 1220 Sofia 0359-2-9375525 www.froneri.com
Duitsland
Bundesverband der Süsswarenindustrie e.V. (BDSI) Schumannstrasse 4-6, D-53113 Bonn 0049-228-260070 (fax 2600789) www.bdsi.de bdsi@bdsi.de
Frankrijk
Association des Entreprises des Glaces 9 boulevard Malesherbes F - 75008 Paris 033-1-53839231 www.les-glaces.com
Italië
Unione Italiana Food Viale del Poggio Fiorito, 61 I - 00144 Roma 039-6-80910728 www.unioneitalianafood.it
Nederland
Nederlandse Vereniging van ConsumptieIJsfabrikanten Schenkkade 50 Postbus 96949, 2509 JH Den Haag 070-3365150
Noorwegen
IskremForeningen P BOX 432NO 4664 Kristiansand 047-38-001100 https://iskremforeningen.no
Slovenië
INCOM d.o.o. Tovarniška cesta 6a SI-5270 Ajdovšcˇina 0386 5 364 39 00 www.leone.si
Verenigd Koninkrijk
FDF Ice Cream Committee 6, Catherine Straat, UK-London WC2B 5JJ 0044-20-74207181 (fax 78360580) www.fdf.org.uk
Zweden
Föreningen Svenska Glasstillverkare North European Ice cream Association, NEICA C/O Livsmedelsföretagen Box 55680 SE-102 15 STOCKHOLM 046-8-7626537 https://www.svenskaglasstillverkare.se
128 ZUIVEL IN ZICHT / 2022 BELANGENBEHARTIGING / EUROPA
Europese Commissie
Wetstraat 130, 1049 Brussel, België 0032-22-2951111 (fax 2-2991761)
Directie: Wolfgang Burtscher (directeur-generaal)
Directoraat G Landbouwmarkten: M. Scannell, (directeur a.i.), Brigitte Misonne (hoofd dierlijke producten)
Directoraat D Duurzaamheid en inkomenssteun: Pierre Bascou (directeur)
Directoraat Landbouw en Plattelandsontwikkeling DG Landbouw en plattelandsontwikkeling telt ongeveer 1000 personeelsleden en is belast met de tenuitvoerlegging van het beleid op het gebied van landbouw en plattelandsontwikkeling. DG Landbouw en plattelandsontwikkeling bestaat uit tien directoraten, die zich bezighouden met alle aspecten van het gemeenschappelijk landbouwbeleid: steun aan boeren, marktmaatregelen, plattelandsontwikkelingsbeleid, duurzaamheid, financiële en juridische vraagstukken en internationale betrekkingen.
voorzitter), Philippe Vareille - Euroserum (FR) (vice-voorzitter), Mathias Hauer - Sachsenmilch (DE) (vice-voorzitter), Alexander Anton (secretaris)
Europese organisatie van weiproducenten. Uitvoering van gezamenlijke projecten op wetenschappelijk, technisch, economisch en juridisch terrein voor wat betreft de basisproducten, en het bevorderen van goede contacten tussen de leden.
Leden
België Milcobel
Denemarken Arla Food Ingredients
Duitsland Alpavit Biolac
BMI DMK Group Hochwald Megle Milei Sachsen Milch, Milk & Whey Ingredients Wheyco
Finland Valio
Frankrijk Armor proteines Bonilait, nutrition animale Eurial Eurosérum Lactalis Ingredients
129 ZUIVEL IN ZICHT / 2022 BELANGENBEHARTIGING / EUROPA
EWPA European Whey Products Association Avenue d’Áuderghem 22-2B, B-1040 Brussel 0032-2-5495040 ewpa@euromilk.org www.ewpa.euromilk.org
Bestuur: Luis Cubel - Arla Foods Ingredients (DK) (voorzitter, James Neville - Volac (UK) (vice-
Ierland
Arrabawn Carbery Dairygold Glanbia Kerry Litouwen Pieno Zvaigzdes Nederland Fonterra Royal FrieslandCampina Royal FrieslandCampina Ingredients VanDrie Group
Noorwegen Tine Polen Polmlek
Verenigd Koninkrijk Dale Farm Saputo Dairy UK Volac
FoodDrinkEurope
Avenue des Nerviens 9-31, 6e etage, 1040 Bruxelles 0032-2-5141111 (fax 5112905) info@fooddrinkeurope.eu www.fooddrinkeurope.eu
Bestuur: Marco Settembri (voorzitter) Directie: Dirk Jacobs (algemeen directeur)
FoodDrinkEurope is de Europese organisatie voor de voedings- en drankenindustrie.
International Dairy Federation

Hoofdkantoor, Silver Building Boulevard Auguste Reyers 70, 1030 Brussel 0032-2-3256740 (fax 3256741) info@fil-idf.org www.fil-idf.org
Bestuur: Piercristiano Brazzale (Italië) (IDF President) Directie: Caroline Emond (Canada) (IDF Directeur-generaal)
IDF vertegenwoordigt de wereldwijde zuivel sector en zorgt dat de beste wetenschappelijke expertise wordt gebruikt om hoge kwaliteit melk en voedzaam, veilige en duurzame zuivelproduc ten te ondersteunen. De leden van IDF, waaron der Nederland (lid sinds de oprichting van IDF in 1903), leveren meer dan 75% van de melk in de wereld en vertegenwoordigen ruim 85% van de mondiale melkpoeder export. IDF wordt als internationale autoriteit erkent door bijvoorbeeld FAO, Codex Alimentarius, ISO en OiE.
130 ZUIVEL IN ZICHT / 2022 BELANGENBEHARTIGING / EUROPA
BluePrint Automation (BPA) is gespecialiseerd in het automatiseren van uw secundaire verpakkingsproces zoals het verpakken van flexibele zakken, dieptrekverpakkingen, cups, kartons en andere moeilijk te verwerken verpakkingen in dozen, trays of kratten. Of het nu gaat om het om-verpakken van een flowpack of (dieptrek)bakje met plakjes of blokjes kaas, een doypack met yoghurtdrank, maar ook een melk gabletop of een beker met ijs, BPA heeft voor elke toepassing een passende oplossing.












van

dan 60 landen zijn BPA verpakkingsoplossingen
Met duizenden succesvolle installaties in meer dan 60 landen zijn BPA verpakkingsoplossingen wereldwijd befaamd vanwege hun korte omsteltijden, flexibiliteit en eenvoudige bediening. De geheel geïntegreerde vooruitstrevende technologieën bestaan onder meer uit kartonneren, gravitysystemen, pick and place, wrap around en cameragestuurde robotica-oplossingen.
Daarom BPA













• No nonsens bedrijf met eigen wereldwijd sales & service netwerk (>500 fte)


• Zeer flexibele oplossingen gebruikmakend van gestandaardiseerde modules
• Meer dan 15 jaar ervaring met vision gestuurde robottechnologie

• BPA denkt mee en ontwikkelt samen met u innovatieve doosconstructies, desgewenst ondersteund met 3D visuals en/of plotmodellen.
Wilt u uw bestaande secundaire verpakkingen efficiënt verwerken en/of wilt u voorbereid zijn op de verpakkingsbehoefte van uw klant in de nabije toekomst, neem dan vandaag nog contact op met Ed Mets of Hans Verhoef.
BluePrint Automation BV Carrosserieweg 3 3445 BC Woerden, The Netherlands T 0031 348 410 999 E sales@blueprintautomation.nl W www.blueprintautomation.com
131 ZUIVEL IN ZICHT / 2021 TOELEVERING / NEDERLAND
MACHINEBOUW
Bos MG-serie. Capaciteiten van 20 tot 44.000 liter per uur en druk tot 1400 bar.




SPAREPARTS
Ruim assortiment aan onderdelen en cilinderblokken direct beschikbaar voor diverse merken en fabrikanten.
REVISIE
Complete revisies om uw oude homogenisator of hogedrukpomp een tweede leven te geven. SERVICE
Een gespecialiseerd service team voor onderhoud, training en ingebruikstelling van uw homogenisator of hogedrukpomp.
Vraag naar onze mogelijkheden. Ons team van professionals staat voor u klaar om de beste oplossing te bieden.
132 TOELEVERING / NEDERLAND ZUIVEL IN ZICHT / 2022
‘SPECIALIST HOMOGENISATOREN EN HOGEDRUKPOMPEN’ BOS Homogenisers BV | Oscar Romerolaan 18, Hilversum Telefoon:
|
Email
+31 (0) 35 62 13 190
www.boshomogenisers.com
: sales@boshomogenisers.com
Mindenstraat 20 8028 PK Zwolle
Mindenstraat 20 8028 PK Zwolle
Mindenstraat 20 8028 PK Zwolle info@buismanzwolle.nl www.buismanzwolle.nl
Mindenstraat 20 8028 PK Zwolle info@buismanzwolle.nl www.buismanzwolle.nl
info@buismanzwolle.nl www.buismanzwolle.nl
info@buismanzwolle.nl www.buismanzwolle.nl
ZUIGELINGENVOEDING
BUISMAN
BUISMAN
BUISMAN
BUISMAN
ZUIGELINGENVOEDING
Daarnaast kan Buisman voor bestaande merken een comanufacturer zijn.
Buisman is gespecialiseerd in het mengen en verpakken van poedervormige voedingsmiddelen, met een sterke focus op zuivel en kindervoeding. Ons totaalconcept omvat een breed scala aan activiteiten. Of het nu gaat om het mengen en verpakken van zuivelpoeders, het produceren van kindervoeding of warehousing & logistieke diensten, wij zijn uw partner.
BUISMAN
Buisman is gespecialiseerd in het mengen en verpakken van poedervormige voedingsmiddelen, met een sterke focus op zuivel en kindervoeding. Ons totaalconcept omvat een breed scala aan activiteiten. Of het nu gaat om het mengen en verpakken van zuivelpoeders, het produceren van kindervoeding of warehousing & logistieke diensten, wij zijn uw partner.
Buisman is gespecialiseerd in het mengen en verpakken van poedervormige voedingsmiddelen, met een sterke focus op zuivel en kindervoeding. Ons totaalconcept omvat een breed scala aan activiteiten. Of het nu gaat om het mengen en verpakken van zuivelpoeders, het produceren van kindervoeding of warehousing & logistieke diensten, wij zijn uw partner.
Buisman is gespecialiseerd in het mengen en verpakken van poedervormige voedingsmiddelen, met een sterke focus op zuivel en kindervoeding. Ons totaalconcept omvat een breed scala aan activiteiten. Of het nu gaat om het mengen en verpakken van zuivelpoeders, het produceren van kindervoeding of warehousing & logistieke diensten, wij zijn uw partner.
kindervoeding produceren, van zuigelingenvoeding “stage 1” tot peutergroeimelk “stage 5”. Zo kunt u een private label vermarkten die door ons ontwikkeld en geproduceerd is. Daarnaast kan Buisman voor bestaande merken een comanufacturer zijn.




Buisman kan voor iedere levensfase kindervoeding produceren, van zuigelingenvoeding “stage 1” tot peutergroeimelk “stage 5”. Zo kunt u een private label vermarkten die door ons ontwikkeld en geproduceerd is. Daarnaast kan Buisman voor bestaande merken een comanufacturer zijn.
Buisman kan voor iedere levensfase kindervoeding produceren, van zuigelingenvoeding “stage 1” tot peutergroeimelk “stage 5”. Zo kunt u een private label vermarkten die door ons ontwikkeld en geproduceerd is. Daarnaast kan Buisman voor bestaande merken een comanufacturer zijn.
groeimelk “stage 5”. Zo kunt u een private label vermarkten die door ons ontwikkeld en geproduceerd is. Daarnaast kan Buisman voor bestaande merken een comanufacturer zijn.
Buisman heeft de mogelijkheid om grote volumes kindervoeding te produceren in industriële (begasbare) verpakkingen zoals zakgoed of big bags. Daarnaast hebben we de mogelijkheid om kindervoeding af te vullen in consumentenverpakkingen zoals bag-in-box en blik.
MELK POEDERS
MELK POEDERS
Buisman is gespecialiseerd in het mengen en verpakken van poedervormige voedingsmiddelen, met een sterke focus op zuivel en kindervoeding. Ons totaalconcept omvat een breed scala aan activiteiten. Of het nu gaat om het mengen en verpakken van zuivelpoeders, het produceren van kindervoeding of warehousing & logistieke diensten, wij zijn uw partner.
Buisman heeft de mogelijkheid om grote volumes kindervoeding te produceren in industriële (begasbare) verpakkingen zoals zakgoed of big bags. Daarnaast hebben we de mogelijkheid om kindervoeding af te vullen in consumentenverpakkingen zoals bag-in-box en blik.
Buisman heeft de mogelijkheid om grote volumes kindervoeding te produceren in industriële (begasbare) verpakkingen zoals zakgoed of big bags. Daarnaast hebben we de mogelijkheid om kindervoeding af te vullen in consumentenverpakkingen zoals bag-in-box en blik.
MELK POEDERS
MELK POEDERS
Buisman heeft meer dan 60 jaar ervaring in het mengen en verpakken van diverse soorten zuivelproducten. Hierin staan kwaliteit en hygiëne centraal. Buisman biedt diverse vormen van verpakken aan zoals bulk, big bags, zakgoed en (consumenten) verpakkingen als sachets en bag-in-box.
Buisman heeft de mogelijkheid om grote volumes kindervoeding te produceren in industriële (begasbare) verpakkingen zoals zakgoed of big bags. Daarnaast hebben we de mogelijkheid om kindervoeding af te vullen in consumentenverpakkingen zoals bag-in-box en blik.
MELK POEDERS
Buisman heeft meer dan 60 jaar ervaring in het mengen en verpakken van diverse soorten zuivelproducten. Hierin staan kwaliteit en hygiëne centraal. Buisman biedt diverse vormen van verpakken aan zoals bulk, big bags, zakgoed en (consumenten) verpakkingen als sachets en bag-in-box.
Buisman heeft meer dan 60 jaar ervaring in het mengen en verpakken van diverse soorten zuivelproducten. Hierin staan kwaliteit en hygiëne centraal. Buisman biedt diverse vormen van verpakken aan zoals bulk, big bags, zakgoed en (consumenten) verpakkingen als sachets en bag-in-box.
KWALITEIT
KWALITEIT
Buisman heeft de mogelijkheid om grote volumes kindervoeding te produceren in industriële (begasbare) verpakkingen zoals zakgoed of big bags. Daarnaast hebben we de mogelijkheid om kindervoeding af te vullen in consumentenverpakkingen zoals bag-in-box en blik.

Al vanaf het allereerste begin zijn wij ons ervan bewust dat het leveren van de juiste kwaliteit het bestaansrecht vormt van Buisman. Dat doen we samen, met passie en overtuiging. En juist daar ligt onze kracht! Buisman is FSSC22000, Halal, Kosher, Skal, NOP en GMP+ gecertificeerd.
KWALITEIT
KWALITEIT
KWALITEIT
Buisman heeft meer dan 60 jaar ervaring in het mengen en verpakken van diverse soorten zuivelproducten. Hierin staan kwaliteit en hygiëne centraal. Buisman biedt diverse vormen van verpakken aan zoals bulk, big bags, zakgoed en (consumenten) verpakkingen als sachets en bag-in-box.
ZUIGELINGENVOEDING
Buisman kan voor iedere levensfase kindervoeding produceren, van zuigelingenvoeding “stage 1” tot peutergroeimelk “stage 5”.
Buisman heeft meer dan 60 jaar ervaring in het mengen en verpakken van diverse soorten zuivelproducten. Hierin staan kwaliteit en hygiëne centraal. Buisman biedt diverse vormen van verpakken aan zoals bulk, big bags, zakgoed en (consumenten) verpakkingen als sachets en bag-in-box.
Al vanaf het allereerste begin zijn wij ons ervan bewust dat het leveren van de juiste kwaliteit het bestaansrecht vormt van Buisman. Dat doen we samen, met passie en overtuiging. En juist daar ligt onze kracht!
Al vanaf het allereerste begin zijn wij ons ervan bewust dat het leveren van de juiste kwaliteit het bestaansrecht vormt van Buisman. Dat doen we samen, met passie en overtuiging. En juist daar ligt onze kracht!
Al vanaf het allereerste begin zijn wij ons ervan bewust dat het leveren van de juiste kwaliteit het bestaansrecht vormt van Buisman. Dat doen we samen, met passie en overtuiging. En juist daar ligt onze kracht!
OPSLAG & LOGISTIEK
Al vanaf het allereerste begin zijn wij ons ervan bewust dat het leveren van de juiste kwaliteit het bestaansrecht vormt van Buisman. Dat doen we samen, met passie en overtuiging. En juist daar ligt onze kracht!
Buisman is FSSC22000, Halal, Kosher, Skal, NOP en GMP+ gecertificeerd.
Buisman is FSSC22000, Halal, Kosher, Skal, NOP en GMP+ gecertificeerd.
Buisman is FSSC22000, Halal, Kosher, Skal, NOP en GMP+ gecertificeerd.
Buisman is uw professionele partner als het gaat om opslag en logistiek. Ons moderne magazijn van 38.000m2 is volledig uitgerust en ontworpen om uw producten veilig en hygiënisch op te slaan. Uiteraard wordt voor uw goederen het proces van ‘Track en Trace’ geborgd en besteed Buisman de grootst mogelijke zorg aan kwaliteit en service.

Buisman is FSSC22000, Halal, Kosher, Skal, NOP en GMP+ gecertificeerd.

TOELEVERING / NEDERLAND
Charm Sciences Inc. USA
Logistiekweg 20-27
7007 CJ Doetinchem
Tel: 0314 380527 Fax: 0314 382899 www.charm.com


Charm Sciences (USA) is een wereldspeler in het testen van levensmiddelen en zuivelproducten voor voedselveiligheid.
Veehouders en zuivelaars vertrouwen op de Charm testen om zich te verzekeren van de hoogste kwaliteitsstandaarden en bescherming van hun merken.
Charms test-gamma bestaat uit sneltesten en geïntegreerde programma’s voor antibiotica residuen, aflatoxine M1, alkalische fosfatase, pesticides, pathogenen en eindproduct controle voor ESL en UHT melk, allergene controle, water kwaliteit en ATP Hygiene-monitoring.
Voor meer informatie contacteer info@charm.com
134 ZUIVEL IN ZICHT / 2022 TOELEVERING / NEDERLAND
Natuurlijke ingrediënten voor een duurzame toekomst
Al meer dan 145 jaar is Chr. Hansen een toonaangevende leverancier van natuurlijke ingrediënten zoals cultures, enzymen. Wij leveren wereldwijd in ongeveer 140 landen producten aan allen takken van de voedingsmiddelenindustrie.
Iedere dag consumeren meer dan 1 biljoen consumenten producten gemaakt met Chr. Hansen ingrediënten. Producten gemaakt door jarenlang onderzoek en ontwikkeling gebaseerd op onze schatkist met meer dan 40,000 bacterie stammen.
Kaas - Chr. Hansen heeft een zeer omvangrijke portfolio voor het produceren van kaas: Stremsels
NATUREN®, dierlijk
CHY-MAX® gefermenteerd
MICROLANT® Supreme microbieel
Cultures
Direct Vat Set® (DVS) starter cultures
EASY-SET® alternatief voor bulk SWING® rijping cultures
Delight™ laag vette kazen BIOSAFE™ nisine cultures
Enzymen
YieldMAX® lipase AFILACT® lysozyme
Gefermenteerde zuivel - Voor de productie van bijvoorbeeld yoghurt, (UHT) melk, zure room heeft Chr. Hansen een zeer breed portfolio aan ingrediënten:

Cultures
YOFLEX® thermofiele cultures
YOFLEX® Acidifix® pH stabiel >4.5
FRESHQ® natuurlijke bioprotectie
EXACT® mesofiele cultures
SWEETY® suiker reductie
NU-TRISH® probiotica b.v. BB-12
Enzymen
NOLA® Fit acid lactase
HA-LACTASE™ neutral lactase
Heeft u interesse of staat u voor een specifieke uitdaging. Neem dan contact op met ons lokaal verkoopkantoor in Houten: +31 30 6019920 of nlsaro@chr-hansen.com
135 TOELEVERING / NEDERLAND ZUIVEL IN ZICHT / 2022




136 ZUIVEL IN ZICHT / 2021
Mr. F.J. Haarmanweg 44
Postbus 82, 4530 AB Terneuzen Tel. 0115-682000 www.elopak.com
Elopak (European License Of PURE-PAK®) is één van ‘s werelds leidende leveranciers van verpakkingssystemen voor vloeibare voedingsmiddelen. Elopak ontwikkelt, vervaardigt en verkoopt complete systemen voor verpakkingen voor niet koolzuurhoudende vloeibare voedingsmiddelen.
Als leverancier van totaalsystemen met organisaties en partners in meer dan 40 landen en klanten in meer dan 80 landen, streeft de Elopak Groep ernaar om haar internationale expertise en producttechnologie toe te passen in nieuwe markten en toepassingen.
In Terneuzen is een productiebedrijf voor Pure-Pak® verpakkingen gevestigd. Tevens staat hier de marketing- en serviceorganisatie voor Market Area Europe West en Global Accounts en de extrusiecoating fabriek Elocoat.
Management
Jeroen Rijnhout : General Manager
Bert Lohuis : Director Global Accounts & BeNeLux

Peter Lernout : Plant Manager Converting Jesse de Jonge : Plant Manager Coating
Joost van Uchelen : Finance Director
Robert Marcus : Human Resources Manager
Feenstra Adviseurs is al meer dan 100 jaar een onafhankelijk adviesbureau voor architectuur, bouwkunde, draagconstructies en gebouwgebonden installaties.

Wij laten de voedingsmiddelenindustrie in heel Nederland voldoen aan de hoogste standaarden op het gebied van hygiëne, veiligheid en brand. De projecten van Feenstra Adviseurs kenmerken zich door hun zakelijke en functionele aanpak. Het succes wordt bepaald door de functionaliteit van het geheel, de kwaliteit van het detail en aandacht voor bouwproces, bouwkosten en levertijden. De kracht van Feenstra Adviseurs is een integrale benadering waarmee wij onze opdrachtgevers op alle gewenste vlakken ondersteunen en ontlasten.
Feenstra Adviseurs b.v. Geograaf 40 6921 EW Duiven 026 384 44 00 www.feenstra.nl
Contactpersoon: ir. Mark van Westerlaak
137 TOELEVERING / NEDERLAND ZUIVEL IN ZICHT / 2022
Kweldamweg 1a
2973 LA MOLENAARSGRAAF
Telefoon: 0184-641266 info@heuvelzuivelmachines.nl www.heuvelzuivelmachines.nl
Leverancier voor de zuivelindustrie en voedingsmiddelenindustrie wereldwijd.
Van den Heuvel Dairy & Food Equipment b.v. levert wereldwijd kwalitatief hoogstaande zuivelmachines en apparatuur voor de bereiding van zuivelproducten - zoals melk, kaas, boter, yoghurt, kwark, kefir - en machines voor vloeibare voedingsproducten.


Onze apparatuur, van afzonderlijke componenten voor zuivelmachines tot complete proceslijnen, is klantspecifiek maatwerk en voldoet aan de laatste Europese richtlijnen. Daarnaast hebben we een groot assortiment nieuwe, gebruikte en gereviseerde machines voor de zuivelindustrie en voor de inrichting van kaasproductielijnen.
Houdt u zich bezig met melkverwerking, productie van zuivelproducten of vloeibare voedingsmiddelen? Van den Heuvel Dairy & Food Equipment b.v. denkt met u mee over efficiency van productieprocessen en levert alle technische apparatuur of componenten daarvan.
139 TOELEVERING / NEDERLAND
ZUIVEL IN ZICHT / 2021
verbindendekracht indezuivelindustrie
verbindendekracht indezuivelindustrie

Oosterwolde

Oosterwolde
Jongsma Engineering Solutions B.V. Boskamp 11, 8431 PS Oosterwolde Tel. : 0516-522071 www.jongsmasolutions.com
JongsmaEngineering SolutionsB.V.
Boskamp 11 8431 PSOosterwolde Tel.: 0516-522071 www.jongsmasolutions.com
JongsmaEngineering SolutionsB.V. Boskamp 11 8431 PSOosterwolde Tel.: 0516-522071 www.jongsmasolutions.com
Wietze Jongsma
Wietze Jongsma
StephanJongsma Mobiel: 06-22900111 06-13902503 E-mail: wietze@jongsmasolutions.comstephan@jongsmasolutions.com


Stephan Jongsma Mobiel : 06-22900111 06-13902503 E-mail : wietze@jongsmasolutions.com stephan@jongsmasolutions.com
StephanJongsma Mobiel: 06-22900111 06-13902503 E-mail: wietze@jongsmasolutions.comstephan@jongsmasolutions.com
Wietze Jongsma
140 TOELEVERING / NEDERLAND ZUIVEL IN ZICHT / 2021
Rott amInn
Langeais Elsau
Cuneo
Kauhajoki Artix
Dresden
Houten
Zwolle
Sneek
Jellum
StephanJongsma Jongsma
Rott amInn
Langeais Elsau
Cuneo
Kauhajoki Artix
Dresden
Houten
Zwolle
Sneek
Jellum
StephanJongsma Wietze Jongsma
Lamberink Logistiek B.V. Noorwegenweg 11 7772 TA Hardenberg www.lamberink-logistiek.nl info@lamberink-logistiek.nl +31 (0)523 - 216999
Lamberink logistiek is al 40 jaar dienstverlener in de zuivel.
Wij kunnen u compleet ontzorgen voor wat betreft; Opslag en stoken van kaas, ontkisten en kwaliteitsbewaking Koelopslag
Orderpicking op doos niveau en uitlevering retail/groothandel Dagelijkse distributie naar retail en groothandel



Kortom; van achter de band tot aan de klant. Voor info neem contact met ons op.

141 TOELEVERING / NEDERLAND ZUIVEL IN ZICHT / 2021
Dairy & EquipmentFood


Handelsweg 2 3411 NZ Lopik T: +31(0)348-558080 E: info@lekkerkerker.nl W: ww w.lekkerkerker.nl


Lekkerkerker Dairy & Food Equipment, voorheen Machinehandel Lekkerkerker B.V., is gespecialiseerd in de revisie van proces- en verpakkingsmachines voor de voedingsmiddelen industrie en dan voornamelijk de zuivel. Met meer dan 70 technische mensen worden wereldwijd complete fabrieken of machines geïnstalleerd Maar ook binnen de landsgrenzen en België




worden aan de grootste zuivelfabrieken machines opgeleverd. Gebruikte zuivelmachines worden opgekocht en na opdracht geheel gereviseerd. Indien fabrieken gebruikte machines beschikbaar hebben, kunnen ze altijd contact opnemen. Met een opslag van 10.000 m2 aan gebruikte machines, is Lekkerkerker één van ’s werelds grootste handelaren in gebruikte zuivelmachines.
Met de knowhow die is opgebouwd in de afgelopen 25 jaar, levert Lekkerkerker niet alleen de machines maar ook de kennis van producten. De snelle terugverdientijd van de machines, de op maat gemaakte machines zorgen voor een goede verkooppositie van Lekkerkerker. Lekkerkerker Dairy & Food Equipment is onderdeel van de Lekkerkerker Groep.
exibiliteit, duurzaamheid door hergebruik en
Machines
Separatoren, homogenisatoren, pasteurisatie (UHT) installaties, vulmachines, boter en margarine proces & verpakkingsmachines, smeltkaas machines, kaas machines, machines voor plant-based producten, CIP installaties en ltratie units
Contactpersonen:
Coen van Beek (verkoop) coen@lekkerkerker.nl Walter van der Kaa walter@lekkerkerker.nl Sebastiaan de Winter (inkoop machines) s.dewinter@lekkerkerker.nl
142 TOELEVERING / NEDERLAND ZUIVEL IN ZICHT / 2021
Coen van Beek Walter van der Kaa
Sebastiaan Inkoop
de Winter Service Verkoop
Wereldwijd specialist in zuivel en voedsel machines.
duurzame oplossingen voor zuivel & voedsel
Pentair Südmo GmbH – Verkoopkantoor Nederland
Pentair Südmo GmbH – Verkoopkantoor Nederland
Marssteden 50, 7547 TC Enschede
Postbus 7500 AS Enschede
Marssteden 50, 7547 TC Enschede
Postbus 7500 AS Enschede
Tel. +31 (0)53 428 70 20 Fax +31 (0)53 428 70 21 www.foodandbeverage.pentair.com info.suedmo@pentair.com
Tel. +31 (0)53 428 70 20 Fax +31 (0)53 428 70 21 www.foodandbeverage.pentair.com pentaircs@pentair.com

Pentair Food & Beverage
Met ruim 10.000 medewerkers wereldwijd werkt Pentair dagelijks aan kostenefficiënte technologie voor de voedingsindustrie. Met onze verschillende merken bieden we een breed scala aan oplossingen voor de voedsel-, zuivel- en drankensector, daaronder kleppen, pompen en componenten. Onze producten worden verkocht en onderhouden in meer dan 100 landen, en ons multidisciplinaire team staat garant voor alle expertise die nodig is om de producten optimaal te kunnen gebruiken.
Pentair Food & Beverage
Met ruim 19.000 medewerkers wereldwijd werkt Pentair dagelijks aan kostenefficiënte technologie voor de voedingsindustrie. Met onze verschillende merken bieden we een breed scala aan oplossingen voor de voedsel-, zuivel- en drankensector, daaronder kleppen, pompen en componenten. Onze producten worden verkocht en onderhouden in meer dan 150 landen, en ons multidisciplinaire team staat garant voor alle expertise die nodig is om de producten optimaal te kunnen gebruiken.
Producten en diensten Pentair Südmo werd opgericht in 1954 en ontwerpt en produceert sindsdien hygiënische en aseptische proceskleppen en componenten, waaronder enkelzitting afsluiters van roestvrij staal, mengvrije kleppen, speciale kleppen en compacte systemen. Alle producten voldoen aan de hoogste normen op het gebied van hygiëne en aseptische toepassingen. Onlangs werd het productportfolio uitgebreid met hygienische pompen. Deze componenten en compacte systemen voldoen aan de hoogste normen op het gebied van hygiëne en aseptische toepassingen en zijn daardoor interessant voor toepassingen in de zuivel- en drankensector en zelfs voor de farmaceutische industrie. Ons ervaren multidisciplinaire team biedt verwerkers in de zuivelen drankenindustrie alles wat nodig is om hun productietijd en operationele flexibiliteit optimaal te benutten.
Producten en diensten Pentair Südmo werd opgericht in 1954 en ontwerpt en produceert sindsdien hygiënische en aseptische proceskleppen en componenten, waaronder enkelzitting afsluiters van roestvrij staal, mengvrije kleppen, speciale kleppen en compacte systemen. Alle producten voldoen aan de hoogste normen op het gebied van hygiëne en aseptische toepassingen. Onlangs werd het productportfolio uitgebreid met hygienische pompen. Deze componenten en compacte systemen voldoen aan de hoogste normen op het gebied van hygiëne en aseptische toepassingen en zijn daardoor interessant voor toepassingen in de zuivel- en drankensector en zelfs voor de farmaceutische industrie. Ons ervaren multidisciplinaire team biedt verwerkers in de zuivelen drankenindustrie alles wat nodig is om hun productietijd en operationele flexibiliteit optimaal te benutten.
Oplossingen voor proces installaties
regelgeving moeten voldoen tot totaaloplossingen voor internationale brouwerijen.
Ons multidisciplinaire team biedt oplossingen voor hygiënische en aseptische procesmiddelen die de productietijd en operationele flexibiliteit kunnen maximaliseren. Het team biedt begeleiding voor processystemen van de ontwerpfase tot de ingebruikname. Bovendien bieden we oplossingen voor (afval)waterbehandeling en -beheersing, alsook vitale procescontrole en elektrische systemen.
regelgeving moeten voldoen tot totaaloplossingen voor internationale brouwerijen. Ons multidisciplinaire team biedt oplossingen voor hygiënische en aseptische procesmiddelen die de productietijd en operationele flexibiliteit kunnen maximaliseren. Het team biedt begeleiding voor processystemen van de ontwerpfase tot de ingebruikname. Bovendien bieden we oplossingen voor (afval)waterbehandeling en -beheersing, alsook vitale procescontrole en elektrische systemen.
Servicebeheer
Service gaat veel verder dan alleen reparatie en onderhoud: het begint al in een vroege fase van projectmanagement wanneer het serviceteam van Pentair de klant voor het eerst ontmoet.
Om hun efficiëntie te verhogen, hebben productiebedrijven in de voedsel- en drankensector hoogwaardige, hygiënische en flexibele processystemen nodig. Pentair is gespecialiseerd in duurzame vloeistofbeheeroplossingen, variërend van diensten voor zuivelinstallaties die aan strikte
Oplossingen voor procesinstallaties
Om hun efficiëntie te verhogen, hebben productiebedrijven in de voedsel- en drankensector hoogwaardige, hygiënische en flexibele processystemen nodig. Pentair is gespecialiseerd in duurzame vloeistofbeheeroplossingen, variërend van diensten voor zuivelinstallaties die aan strikte
Servicebeheer Service gaat veel verder dan alleen reparatie en onderhoud: het begint al in een vroege fase van projectmanagement wanneer het serviceteam van Pentair de klant voor het eerst ontmoet. Ons serviceteam verzamelt op locatie waardevolle informatie over de lokale omstandigheden van het proces. Door de prestatiegegevens actief te monitoren kunnen we lange termijn gegevens verzamelen, waardoor we zeer efficiënt problemen kunnen oplossen en serviceactiviteiten kunnen afstemmen. De servicecontracten vormen een integraal onderdeel van het programma voor preventief onderhoud. Pentair voert de service- en onderhoudstaken uit via een gecertificeerde servicepartner, zodat we zeker weten dat de installaties regelmatig en continu worden verbeterd.
Ons serviceteam verzamelt op locatie waardevolle informatie over de lokale omstandigheden van het proces. Door de prestatiegegevens actief te monitoren kunnen we lange termijn gegevens verzamelen, waardoor we zeer efficiënt problemen kunnen oplossen en serviceactiviteiten kunnen afstemmen. De servicecontracten vormen een integraal onderdeel van het programma voor preventief onderhoud. Pentair voert de service- en onderhoudstaken uit via een gecertificeerde servicepartner, zodat we zeker weten dat de installaties regelmatig en continu worden verbeterd.
143 TOELEVERING / NEDERLAND ZUIVEL IN ZICHT / 2022
Sijtsma Noord BV is dé coating specialist in de voedingsmiddelenindustrie. Wij leveren vakkundig werk en hebben veiligheid, betrouw- baarheid, hygiëne en levering binnen de afgesproken tijd hoog in het vaandel staan. Sijtsma Noord biedt een totaalpakket aan van inspectie tot advisering, budgettering en uitvoering tot en met de nazorg.






Buitenlandse export en een steeds strenger wordende regel en wetgeving voor de zuivel- en voedingsmiddelenindustrie “dwingen” deze industrie om hun huidige en toekomstige productie omgeving continue onder de loep te nemen. Voor het renoveren en aanleggen van productieruimtes, bedrijfsruimtes en an dere commerciële omgevingen waar deze strenge eisen van toepassing zijn is een grote deskundigheid vereist. In zowel binnen- als buitenland verricht Sijtsma Noord al meer dan 45 jaar diverse werkzaamheden binnen de zuivel- en voedingsmiddelenindustrie en heeft deze expertise en deskundigheid in huis.
Sijtsma Noord is een VCA**, NEN & ISO 9001, ISO 22000 en HACCP gecertificeerd bedrijf. Ook onze toeleveranciers hebben ons officeel gecertificeerd als applicatiebedrijf. We werken uitsluitend met hoogwaardig en modern materieel. De zorg voor kwaliteit, veiligheid en hygiëne staat dan ook voorop. Om de coating werkzaamheden zo goed en snel mogelijk te laten verlopen, ontwikkelen wij continu nieuwe technologieën. Zo is Sijtsma Noord dé enige binnen dit vakgebied die uw pekelbad kan inspecteren en renoveren tijdens het productieproces. Dit betekent weinig tot geen omzetverlies door productiestagnatie. Tevens wordt ons personeel regelmatig bijgeschoold in productkennis en het beheersen van de nieuwste toepassingstechnieken op het gebied van veilige en hygiënische coatings.
144
VCA**, ISO 9001 & 22000 en HACCP gecertificeerd vakmanschap Uitvoering volgens de geldende wet- en regelgeving Uitvoering van (renovatie)werkzaamheden tijdens het productieproces MEERWAARDE SIJTSMA NOORD SPECIALIST IN BETONRENOVATIE, STRALEN, EN VEILIGE EN HYGIËNISCHE COATING SYSTEMEN VOOR O.A. VLOEREN, WANDEN, PLAFONDS, STAALCONSTRUCTIES EN PEKELBADEN Sijtsma Noord BV Ljouwertertrekwei 30 9035 ed Dronrijp +31(0)517 23 22 00 info@sijtsma-noord.nl www.sijtsma-noord.nl CONTACTGEGEVENS Alle vakmanschap is onder één dak te vinden! N S
& engineered proces systemen specifiek voor de zuivel, voeding, brouwerijen, frisdranken, farmaceutica, industrie en chemie.
SPX Flow Technology staat voor toegevoegde waarde, proces optimalisatie in combinatie met een goede dienstverlening op het gebied van service. SPX Flow Technology heeft een uitgebreid assortiment aan eigen componenten. Deze zijn ontworpen met als doelstelling: een
IndampSeparators • Op Sales Jos Kennes,
Netherlands (SFEL)
Nederland:
Nederland:
Albert Thijsstraat 12 6471 WX EYGELSHOVEN
SPX Flow Europe Limited Netherlands (SFEL)
Albert Thijsstraat 12 6471 WX EYGELSHOVEN
Tel. +31 592 711 399
Email: apv.be.info@spxflow.com www.spxflow.com
Tel. +31 592 711 399
SPX Flow Europe Limited Netherlands (SFEL) Albert Thijsstraat 12 6471 WX EYGELSHOVEN Tel. +31 592 711 399 Email: apv.be.info@spxflow.com www.spxflow.com
maximale operationele efficiëntie en het zuinig omspringen met energie. De combinatie van industriële uitmuntendheid en een strenge kwaliteitscontrole garandeert dat het assortiment van producten en systemen voldoen aan de hoogste internationale hygiënenormen.
maximale operationele efficiëntie en het zuinig omspringen met energie. De combinatie van industriële uitmuntendheid en een strenge kwaliteitscontrole garandeert dat het assortiment van producten en systemen voldoen aan de hoogste internationale hygiënenormen.
Belgie:
Email: apv.be.info@spxflow.com www.spxflow.com
Belgie:
SPX Flow Europe Limited Belgium (SFEL)
Belgie:
maximale operationele efficiëntie en het zuinig omspringen met energie. De combinatie van industriële uitmuntendheid en een strenge kwaliteitscontrole garandeert dat het assortiment van producten en systemen voldoen aan de hoogste internationale hygiënenormen.
Dankzij lokale vestigingen in meer dan 40 landen, waaronder Nederland en België, kan SPX Flow Technology haar klanten tal van voordelen bieden.
SPX Flow Europe Limited Belgium (SFEL) Evenbroekveld 2-6 B-9420 ERPE-MERE
Evenbroekveld 2-6 B-9420 ERPE-MERE Tel. +32 53 60 27 80
Email: apv.be.info@spxflow.com www.spxflow.com
Tel. +32 53 60 27 80
SPX Flow Europe Limited Belgium (SFEL) Evenbroekveld 2-6 B-9420 ERPE-MERE Tel. +32 53 60 27 80 Email: apv.be.info@spxflow.com www.spxflow.com

Email: apv.be.info@spxflow.com www.spxflow.com
SPX Flow Technology levert met de merken APV, Johnson Pump, Gerstenberg & Schröder, Seital en Anhydro (hygiënische) centrifugaal pompen, hoge druk pompen, volumetrische pompen, kleppen, warmtewisselaars, standaard systemen & engineered proces systemen specifiek voor de zuivel, voeding, brouwerijen, frisdranken, farmaceutica, industrie en chemie.
SPX Flow Technology levert met de merken APV, Johnson Pump, Gerstenberg & Schröder, Seital en Anhydro (hygiënische) centrifugaal pompen, hoge druk pompen, volumetrische pompen, kleppen, warmtewisselaars, standaard systemen & engineered proces systemen specifiek voor de zuivel, voeding, brouwerijen, frisdranken, farmaceutica, industrie en chemie.
SPX Flow Technology levert met de merken APV, Johnson Pump, Gerstenberg & Schröder, Seital en Anhydro (hygiënische) centrifugaal pompen, hoge druk pompen, volumetrische pompen, kleppen, warmtewisselaars, standaard systemen & engineered proces systemen specifiek voor de zuivel, voeding, brouwerijen, frisdranken, farmaceutica, industrie en chemie.
SPX Flow Technology staat voor toegevoegde waarde, proces optimalisatie in combinatie met een goede dienstverlening op het gebied van service. SPX Flow Technology heeft een uitgebreid assortiment aan eigen componenten. Deze zijn ontworpen met als doelstelling: een
SPX Flow Technology staat voor toegevoegde waarde, proces optimalisatie in combinatie met een goede dienstverlening op het gebied van service. SPX Flow Technology heeft een uitgebreid assortiment aan eigen componenten. Deze zijn ontworpen met als doelstelling: een
SPX Flow Technology staat voor toegevoegde waarde, proces optimalisatie in combinatie met een goede dienstverlening op het gebied van service. SPX Flow Technology heeft een uitgebreid assortiment aan eigen componenten. Deze zijn ontworpen met als doelstelling: een
Dankzij lokale vestigingen in meer dan 40 landen, waaronder Nederland en België, kan SPX Flow Technology haar klanten tal van voordelen bieden.
Dankzij lokale vestigingen in meer dan 40 landen, waaronder Nederland en België, kan SPX Flow Technology haar klanten tal van voordelen bieden.
PRODUCTEN EN DIENSTEN
PRODUCTEN EN DIENSTEN
PRODUCTEN EN DIENSTEN
(Hygiënische) centrifugaal pompen, hoge druk pompen, volumetrische pompen, kleppen, warmtewisselaars, standaard systemen & engineered proces systemen en lokale service.
(Hygiënische) centrifugaal pompen, hoge druk pompen, volumetrische pompen, kleppen, warmtewisselaars, standaard systemen & engineered proces systemen en lokale service.
Voor de zuivelindustrie
• Melk- en Roomprocessen
(Hygiënische) centrifugaal pompen, hoge druk pompen, volumetrische pompen, kleppen, warmtewisselaars, standaard systemen & engineered proces systemen en lokale service.
Voor de zuivelindustrie
• Melk- en Roomprocessen
• Steriele technologie UHT behandeling
Voor de zuivelindustrie
• Steriele technologie
• Boteruitrusting Membraan filtratie installaties
• UHT behandeling
• Melk- en Roomprocessen • Steriele technologie • UHT behandeling • Boteruitrusting
• Boteruitrusting
• Membraan filtratie installaties
• Mix- en mengtoepassingen Indamp- en droogtechniek
• Mix- en mengtoepassingen
Separators
• Membraan filtratie installaties • Mix- en mengtoepassingen • Indamp- en droogtechniek
• Indamp- en droogtechniek
• Op maat gemaakte oplossingen
Separators
Sales Management Benelux
• Op maat gemaakte oplossingen
Separators
Jos Kennes, Sales
• Op maat gemaakte oplossingen
Sales Management Benelux
Jos Kennes, Sales


Sales Management Benelux
Jos Kennes, Sales
• Membraan • Mix•
145 TOELEVERING / NEDERLAND ZUIVEL IN ZICHT / 2022
Familiebedrijf Stafier Holland BV maakt al meer dan 60 jaar producten uit staal en RVS, waaronder de duurzame, geperforeerde RVS-kaasplank.



Pluspunten: minder schoonmaken, geen chemicaliën nodig, homogene rijping en minder kaas keren.

www.stafier.com Tel.
+31 (0)316-332741 Steeds meer kaasmakers rijpen de kaas op geperforeerd RVS.
“Weinig schimmel en schoonmaak. RVS werkt superfijn.”
Wilco de Crom Kaasmakerij Nieuwerwets, Knegsel
Hendrika de Jong De Deelen, Tijnje
Daniëlle Vuulink De Kaastobbe, Duiven Anton Wijen Mildershoof, Nederweert-Eind
146 TOELEVERING /
ZUIVEL IN
NEDERLAND
ZICHT / 2021
Van grondstof tot eindproduct
Tetra Pak biedt een totaalpakket aan: van ruwe grondstof tot de verpakkingen. Ons portfolio dekt het hele traject met oplossingen voor zuivel, kaas, ijs, dranken, prepared food en powder tot en met complete afvullijnen, afgestemd op uw specifieke wensen.
Het productportfolio bestaat uit o.a. warmtewisselaars, separatoren, homogenisatoren, CIP-systemen, filtratiemodules, pasteurisatie- en sterilisatiesystemen, (aseptische) tanks, ontluchters, kaas- en ijsproductielijnen, drogers en indampers, poedertransport, oplos-, blending- en mixsystemen, verpakkingmachines, proces- en automation engineering en project management. Tetra Pak is ook “preferred distributor” van Alfa Laval sanitaire componenten. Met op maat gesneden service-producten levert Tetra Pak 24/7 ondersteuning op apparatuur en automation-systemen.

Scan voor informatie

Ontdek deze site om de voordelen te leren van Tetra Pak apparatuur zijn klanten over de gehele wereld en de mogelijkheden die het kan creëeren voor uw activiteiten.
www. tetrapak.com
147 ZUIVEL IN ZICHT / 2021
Processing, packaging, Automation & Service Solutions BELGIE & LUXEMBURG A. Gossetlaan 28A b1 1702 Groot-Bijgaarden +32 (0)2 467 68 11 NEDERLAND
Deventerlaan 30-40 3528 AE Utrecht +31 (0)30
99
Van
634 99
URSCHEL B.V.
Vogelpoelweg 8 3961 NL Wijk bij Duurstede T +31 343 575454
URSCHEL B.V.
Vogelpoelweg 8 3961 NL Wijk bij Duurstede T +31 343 575454
I www.urschel.nl
E netherlands@urschel.com
I www.urschel.nl
E netherlands@urschel.com
Urschel is met meer dan 50 verschillende machines wereldwijd marktleider op het gebied van voedsel snij-, rasp- en maalmachines. In de zuivelbranche kent Urschel vele toepassingen op onder andere kaas, ricotta, caseine. Ook bij het snijden van fruit, noten en andere toevoegingen aan zuivelproducten en bij de productie van soja-, amandelmelk en smoothies spelen Urschel machines een belangrijke rol.
Bedrijfstype: Machinefabriek/groothandel
Bedrijfstype: Machinefabriek/groothandel
Organisatie: Besloten vennootschap
Organisatie: Besloten vennootschap
Moederbedrijf:
URSCHEL LABORATORIES, INC. USA

Moederbedrijf: URSCHEL INC., USA.
Contactpersoon: Luc van Buynder, Technical Sales Director
Contactpersoon: Luc van Buynder, Sales Manager Nederland, België Producten
Producten
• Industriële snijmachines voor plakjes, blokjes en reepjes
• Industriële snijmachines voor plakjes, blokjes en reepjes
• Industriële raspmachines met traploos instelbare rasp-/snijkoppen
• Industriële raspmachines met traploos instelbare rasp-/snijkoppen
• Industriële maalmachines voor droge en natte processen voor onder andere poederkaas en ricotta
• Industriële maalmachines voor drogeen natte processen voor onder andere poederkaas en ricotta
• Raspkoppen voor de traditionele gekrulde rasp en voor poeder van Parmezaanse kaas
• Raspkoppen voor de traditionele gekrulde rasp en voor poeder van Parmezaanse kaas
Urschel is met meer dan 50 verschillende machines wereldwijd marktleider op het gebied van voedsel snij-, rasp- en maalmachines. In de zuivelbranche kent Urschel vele toepassingen op onder andere kaas, ricotta, caseine. Ook bij het snijden van fruit, noten en andere toevoegingen aan zuivelproducten en bij de productie van soja-, amandelmelk en smoothies spelen Urschel machines een belangrijke rol. Urschel machines staan bekend om hun hoge snijkwaliteit en -capaciteit gecombineerd met
Urschel machines staan bekend om hun hoge snijkwaliteit en -capaciteit gecombineerd met duurzaamheid en lage onderhoudskosten. URSCHEL B.V. is uw aanspreekpunt voor de verkoop, service en technische ondersteuning van klanten in Nederland en België.
148 TOELEVERING / NEDERLAND ZUIVEL IN ZICHT / 2022
Luc van Buynder
Nobelweg 8
5482 NN SCHIJNDEL tel. 073-5492911 fax. 073-5478874 info@voetsdonkers.nl www.voetsdonkers.nl

Voets & Donkers produceert en installeert op maat gemaakte luchtbehandelingsystemen en koelinstallaties voor de (levensmiddelen) industrie, tuinbouw en utiliteit.
Energiebesparing
Middels een door Voets & Donkers ontwikkeld HR-ontvochtigingssysteem voor o.a. kaasrijping kan een energiebesparing tot wel 40% bereikt worden (EIA code 210705).
Onze kernactiviteiten zijn
• Koeltechniek
• Luchtbehandeling voor kaasrijping
• High care verwerkingsruimten
• Cleanrooms
Door de bundeling van de disciplines koeltechniek, besturingstechniek en luchttechniek binnen één bedrijf, bieden wij totaaloplossingen die volledig aansluiten op de gewenste condities. Van creatief maatwerk tot standaardoplossingen.
Contactpersonen
ir. P.G.M. Donkers ing. M.A.J. Voets
149 TOELEVERING / NEDERLAND ZUIVEL IN ZICHT / 2022
Postbus 93044
Postbus 93044
2509 AA ‘s-GRAVENHAGE tel. 070-2191707
2509 AA ‘s-GRAVENHAGE tel. 070-2191707
Postbus 93044
redactie.zuivelzicht@bdu.nl www.zuivelzicht.nl
redactie.zuivelzicht@bdu.nl www.zuivelzicht.nl
2509 AA ‘s-GRAVENHAGE tel. 070-2191707 redactie.zuivelzicht@bdu.nl www.zuivelzicht.nl

Vakblad en digitaal magazine met nieuws en achtergronden over de Nederlandse en Belgische zuivelketen (melkveehouderij, zuivelindustrie en -handel, retail, aanverwante en toeleverende bedrijven).
Vakblad en digitaal magazine met nieuws en achtergronden over de Nederlandse en Belgische zuivelketen (melkveehouderij, zuivelindustrie en -handel, retail, aanverwante en toeleverende bedrijven).
Vakblad en digitaal magazine met nieuws en achtergronden over de Nederlandse en Belgische zuivelketen (melkveehouderij, zuivelindustrie en -handel, retail, aanverwante en toeleverende bedrijven).
Het magazine verschijnt twaalf keer per jaar en besteedt aandacht aan onder meer het EU-zuivelbeleid, de ontwikkelingen op de internationale zuivelmarkt, de strategieën van zuivelondernemingen en de afzetmogelijkheden van zuivel.
Het magazine verschijnt twaalf keer per jaar en besteedt aandacht aan onder meer het EU-zuivelbeleid, de ontwikkelingen op de internationale zuivelmarkt, de strategieën van zuivelondernemingen en de afzetmogelijkheden van zuivel.
Het magazine verschijnt twaalf keer per jaar en besteedt aandacht aan onder meer het EU-zuivelbeleid, de ontwikkelingen op de internationale zuivelmarkt, de strategieën van zuivelondernemingen en de afzetmogelijkheden van zuivel.
Redactie
Redactie
René van Buitenen, hoofdredacteur 070-2191707 r.v.buitenen@bdu.nl
René van Buitenen hoofdredacteur 070-2191707 r.v.buitenen@bdu.nl
Redactie
René van Buitenen, hoofdredacteur 070-2191707 r.v.buitenen@bdu.nl
Contenthuis BDUvakmedia, eindredactie redactie@bdu.nl
Contenthuis BDUvakmedia, eindredactie redactie@bdu.nl
Medewerkers
Medewerkers
Contenthuis BDUvakmedia, eindredactie redactie@bdu.nl
Ria Besseling, rbesseling@quicknet.nl Yves De Groote, yves@thetextfactory.eu

Ria Besseling rbesseling@quicknet.nl Yves De Groote yvesgm.degroote@outlook.com


Medewerkers
Advertenties
Advertenties
Ria Besseling, rbesseling@quicknet.nl Yves De Groote, yves@thetextfactory.eu
Hielke van der Werf, 020-5736056 h.v.d.werf@bdu.nl
Advertenties
Hielke van der Werf, 020-5736056 h.v.d.werf@bdu.nl
BDUvakmedia
Marconistraat 33 Postbus 67 3770 AB Barneveld www.bduuitgevers.nl
Hielke van der Werf 06-31958305 h.v.d.werf@bdu.nl BDUvakmedia Marconistraat 33 Postbus 67 3770 AB Barneveld www.bduvakmedia.nl
BDUvakmedia
Marconistraat 33 Postbus 67 3770 AB Barneveld www.bduuitgevers.nl
René van Buitenen Ria Besseling
Yves de Groote
René van Buitenen Ria Besseling Yves de Groote
150 ZUIVEL IN ZICHT / 2022 TOELEVERING / NEDERLAND
151 NOTITIES ZUIVEL IN ZICHT / 2022
In2Food, uw partner voor het produceren van smakelijke zuivel op een veilige en hygiënische manier.


Ontdek ons brede assortiment op www.in2food.nl
Jouw partner in procesautomatisering
Als zuivelproductent wil je de zekerheid dat je producten veilig en tijdig de juiste bestemming bereiken. Dat kan alleen als de industriële omgeving tot in perfectie en veilig is ingericht en wordt onderhouden.
Samen realiseren we een constante vooruitgang.
Meer weten?
Neem contact op met Sebastian Taken: sebastian.taken@actemium.com +31 (0)88 83 18 200 Of bekijk onze website.
152
ZUIVEL IN ZICHT / 2022

153 ZUIVEL IN ZICHT / 2022













154 ALPMA – Customized solutions for dairies Mould Material Process Technology Mozzarella Brining Technology Cutting Technology Cheese Technology Packaging Technology Semi hard Cheese Process Technology Cheese Technology Cutting Technology Packaging Technology Mozzarella Semi hard Cheese Hard Cheese NOW From Camembert, Brie, Feta to Semi hard & Hard cheese, Mozzarella Visit our new website: www.alpma.com Take advantage of ALPMA’s complete product range. We offer our customers and partners unique product solutions from a single source by combining our divisions Process, Cheese, Cutting- & Packaging-Technology –from technically and technologically leading machines for processing and packaging food up to complete system solutions for dairies . For more infos please contact Wietze & Stephan Jongsma: Jongsma Engineering Solutions B.V. + 31 622 900 111 wietze@jongsmasolutions.com NEW NEW NEW
155 NOTITIES ZUIVEL IN ZICHT / 2022
156 NOTITIES ZUIVEL IN ZICHT / 2022
ABAB Accountants en Adviseurs 72
Actemium 152
Agri-Best BV 42
Agribusiness Service BV 72 Agro & Agri 73
Alexanderhoeve kaas & noten 42
Albert Heijn BV 42
Aldi Inkoop BV 42
Alfa accountants en adviseurs 73
Alpha Group of Companies 43
Alpma 154
Alphenaar De Jong Cheese 11
Amalthea B.V. 11
Amsterdam Ingredients B.V. 43 Arla Foods B.V. 12
Assifonte 120
Ausnutria 14
Ausnutria Dairy Ingredients 44
AVH dairy trade B.V 44
BCZ Belgische Confederatie van de Zuivelindustrie 112
BDF Belgian Dairytrade Federation 113 Belgische Senaat 113
Bel Nederland BV 14
BeNeLuxSmelt Association of Processed Cheese Manufactures 88
Bettinehoeve BV 15 BioForum vzw 113
Bloomfield Dairy BV 45 BluePrint Automation 131
Boerenbond 114
Boerenkaasnotering, Commissie 89
Bond van Boerderijzuivelbereiders 88
Boni Supermarkten BV 45
Bos Homogenisers 132
Buisman Warehousing 133
Butterei Pur Natur AG 36
Capra s.a. 36
CBL - Centraal Bureau Levensmiddelenhandel 89
CBM - Coöperatieve Belangenvereniging
Melkgeitenhouderij Midden Nederland ua. 91
Charm Sciences 134 Chimay Fromages 36 Chr Hansen 135 Coferme S.C. 36 Collectief Praktiserende Dierenartsen 91 Complete Filtration 136 CONO Kaasmakers 16
Controle Orgaan Kwaliteits Zaken 84 Coop Supermarkten 45 Corman SA 36
CZ “Rouveen” u.a. 30 Dairy Campus 74
Danone Nederland BV 45 DDB - Dutch Dairymen Board 92 DeJong Alphenaar Cheese 11 Den Eelder Zuivel 17 ‘De Producent’ BA 60 Detailresult Groep 46 De Unie in jouw belang 108 DGZ (Dierengezondheid Vlaanderen) vzw 115 Diverspack 46
DLV Advies 74
DOC Kaas U.A. Hoogeveen 17 Dr. Oetker Nederland 17
DSM 10
EDA European Dairy Association 122 Elopak 137
EMB European Milk Board 125 Eucolait 126 EuroCommerce 127
Euroglaces 127
Europese Commissie 129 EWPA European Whey Products Association 129
ExpertCheese B.V. 46 Fabelco BV 47 Farm Dairy BV 19 Farmel dairy business 19 Fedecom 93
FEENSTRA Adviseurs 137 Flynth adviseurs en accountants 75
157 ZUIVEL IN ZICHT / 2022 INDEX
FND - Federatie
Nederlandse Diervoederketen 94
FNLI - Federatie Nederlandse Levensmiddelen Industrie 93 FNV 94
Fonterra 47 FoodDrinkEurope 130 FoodService Instituut Nederland 76 Foodvalley NL 76 Frésena-Salland BV 48
Fromunion NV- Kaasmakerij Passendale 37 GemZu Vereniging Gemeenschappelijk
Zuivelsekretariaa 95
Genootschap t.b.v. Melkkunde 95
Geris Dairy Solutions 48
Gestam Kaasexport B.V. 48 Global Dairy Farmers 96 Globemilk 21 Goat Milk Powder B.V. 22 Groba 138 Grozette BV 49 Havero Hoogwegt BV 49 Hazeleger Kaas BV 50 Henri Willig Groep 24 Heuvel Van den 139 Hisfa 96 Hochwald Foods Nederland B.V. 25 Hoogvliet BV 51 Hoogwegt Cheese BV 51 Hoogwegt Group BV 52 Hoogwegt International BV 52 Hoogwegt Milk 53
IKM-Vlaanderen VZW 115
ILVO-T&V Instituut voor Landbouw- en Visserijonderzoek 116
Imeko dairy products bv 53 Interfood B.V. 54
International Dairy Federation 130 Jacques’ Kruidenboter B.V. 25 Jan Linders 56 Jongsma Engineering Solutions 140
Kaashandel Remijn 55 Kaasmakerij Özgazi 26 Kaasmerk Matec 97 Kaas-Pack Holland BV 55
Kamer van volkvertegenwoordigers 118 Kaptein 56 Kaptein PCF 26
KB - Stichting Kwaliteitszorg Boerenkaas 97 Klaver Kaas BV 27 KNMvD 98
KOM - Stichting Kwaliteitszorg Onderhoud Melkinstallaties 98
Konings-Zuivel BV 56 Koninklijke ERU 18 Koninklijke FrieslandCampina N.V. 20 LaBan Foods BV 28 Labeij Food Products 28 Lactalis Nestlé Produits Frais SA/NV 37 Laiterie Socabel S.A. 38
Lamberink Logistiek 141 Lekkerkerker Equipment 142 Lekkerkerker Food 29 Lidl Nederland 56 Limelco NV 38 LTO Nederland 99 Luxlait Association Agricole 41 MAAZ Cheese BV 57 Makro Nederland 56 MCC Melkcontrolecentrum - Vlaanderen 117 Melkweg Holland BV 59 MilkBE 118 Milcobel cvba 39 Ministerie van Landbouw en Landelijke Aangelegenheden, Waals 118 Ministerie van Landbouw, Natuur en Voedselkwaliteit 85 NAJK - Nederlands Agrarisch Jongeren Kontakt 100 Nestlé Nederland 29 Nettorama 59 Nevedi 100
158 ZUIVEL IN ZICHT / 2022 INDEX
NGZO - Nederlandse GeitenZuivel
Organisatie 101
NIZO food research B.V. 101
NMV - Nederlandse Melkveehouders Vakbond 102
NNC-IDF 102
NNKC - Stichting Nederlands Nationaal Kaaskeur Concours 103 Numidia 59
NVC - Nederlandse IJsfabrikanten 104
NVC - Nederlands Verpakkingscentrum 105
NV Danone SA 71
NV INEX 37
NV LACTIS Pur Natur SA 38
NV Pur Natur SA 40
NVWA - Nederlandse Voedsel en Waren Autoriteit 85
NZO - Nederlandse Zuivel Organisatie 105 O.D.I. de Dageraad BV 30 Olympia NV 39
Overheid, Vlaamse 118 Parlement, Vlaams 119 Pentair 8, 143
Platform Boerderijeducatie Nederland 78 Plus Retail B.V. 60
Qlip 106
Royal A-ware 13 Royal GD 77
Royal Lactalis Leerdammer BV 27 Royal VIV Buisman 32
S.A Vache Bleue N.V. 71
SIBK - Stichting Importeurs Buitenlandse Kaas 107 Sijtsma Noord 4, 144 Skal Biocontrole 85
Sligro Food Group Nederland BV 61
SOLAREC S.A. 41 Spar Holding 61 SPX Flow 145 Stafier 146 Stichting Foodspecialiteiten Nederland 77
Stichting Nederlandse Zuivelbeurs 108 Stichting Top Institute Food and Nutrition 78 St. Jozef CV 37 St. Paul NV 40
Tetra Pak 147
TKI Agri&Food 79 Treur Kaas 61 Trouw Nutrition 79 TÜV NORD Integra 119
Tweede Kamer der Staten Generaal 86 Uniekaas Holland B.V. 62 Unilac Holland 62
Urschel 148 Vakcentrum Foodspecialiteiten 108 Vakgroep LTO Melkgeitenhouderij 99 Vakgroep LTO Melkveehouderij 99 Van der Heiden Cheese Services 51 Van der Heiden Kaas B.V. 50 Vandersterre 63
Veco Zuivel BV 31
Vee&Logistiek Nederland 109 Vepo Cheese 65 Verder 6
Vereniging Automatisering Kaasgroothandel 109 Vergeer & Zn. B.V., Th. 65 Vika BV 31
Visser Kaas 67
VLAM Vlaams Centrum voor Agro- en Visserijmarketing 119
VLB - Vereniging van Accountants- en Belastingadviesbureaus 80
VNFKD - Vereniging van Nederlandse Fabrikanten van Kinder- en
Dieetvoedingsmiddelen 110 Voets & Donkers 6, 149
Vreugdenhil Dairy Foods 32 Vreugdenhil Dairy Foods 68 Wageningen Economic Research 82 Wageningen Livestock Research 832Wageningen University & Research 81 Walhorn S.A. 41
159 ZUIVEL IN ZICHT / 2022 INDEX
Weerribben Zuivel 33
Westland Kaas BV 68
WSP 153
Yakult Belgium NV/S.A 71
Yakult Europe B.V. 34
Zijerveld 69
Zuivelculinair Exloo BV 35
Zuivelfabriek De Graafstroom 23
Zuivelhoeve B.V. 35
ZuivelNL 111 Zuivelzicht 150
160 ZUIVEL IN ZICHT / 2022 INDEX
161 NOTITIES ZUIVEL IN ZICHT / 2022
162 NOTITIES ZUIVEL IN ZICHT / 2022
United in Food Solutions

Onze passie voor food is wat ons drijft. Enerzijds door van roomkaas en kaasproducten op zuivel- en plantaardige Anderzijds door het reviseren, wereldwijd verhandelen
Onze passie voor food is wat ons drijft. Enerzijds door de productie van roomkaas en kaasproducten op zuivel en plantaardige basis. Anderzijds door het reviseren, wereldwijd verhandelen en installeren van gebruikte zuivel- en food machines.

Door onze kennis en ervaring van het product en de techniek zijn we in staat om snel te innoveren en kwalitatieve, betrouwbare oplossingen te bieden.
Wij zijn regelmatig op zoek naar technisch en productie personeel, bezoek onze website voor meer informatie.



lekkerkerkergroep.nl